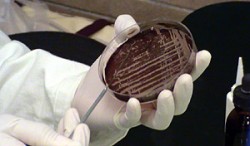

2012/04/30
Crystal Lagoons e Inmobiliaria Aconcagua Impulsan Proyecto Inmobiliario Más Grande de Chile con Lagunas Cristalinas
* Con una inversión asociada de US$1.800 millones y 20 mil viviendas, el proyecto considerará varias lagunas cristalinas. La primera será de 1,8 hectáreas, revolucionando por completo el estilo de vida de las personas en el Norte de Chile*

30 de Abril de 2012.- Un nuevo hito en el Norte de Chile anunciaron Crystal Lagoons e Inmobiliaria Aconcagua con el proyecto inmobiliario con lagunas cristalinas más grande del país, y a la vez, uno de los más importantes de Latinoamérica Se trata de un megaproyecto inmobiliario de más de US$1.800 Millones en inversión, situado en plena ciudad de Antofagasta, que incorporará varias lagunas cristalinas navegables, con arenas blancas y palmeras. La primera de ellas tendrá 1,8 hectáreas, en el corazón de este proyecto de primera vivienda. “Costa Laguna” es el segundo Resort Urbano con vida de playa en plena ciudad, que impulsan ambas firmas en el norte, sumándose al proyecto “Laguna del Mar” que se levanta en La Serena.
Este megadesarrollo estará emplazado en un terreno de 320 hectáreas en el sector norte de la ciudad y con excelente conectividad. Su mayor atractivo será la incorporación de playas privadas de arenas blancas, palmeras y lagunas cristalinas con aguas turquesas donde será posible realizar todo tipo de deportes náuticos. Contempla la construcción de 20 mil casas y departamentos en un plazo estimado de 20 años, con precios que van desde las 3.000 a 8.000 UF. Además, este gran proyecto incluirá supermercados, hoteles, clínicas y colegios, lo que lo convierten en uno de los desarrollos más icónicos de Chile.
“Costa Laguna”, cuya entrega de casas comenzará a fines de este año, incorpora 32 hectáreas de áreas verdes, equipamiento deportivo, áreas de juegos y servicios.
“Costa Laguna representa un radical cambio en el estilo y calidad de vida de las personas, ya que podrán vivir en un paraíso tropical en la puerta de la casa y disfrutar de los beneficios de vivir junto a la playa los 365 días del año, realizando todo tipo de actividades náuticas y implicando la sensación de estar permanentemente de vacaciones. Sin duda este megaproyecto marcará tendencias relevantes no sólo en el desarrollo inmobiliario del norte de Chile, sino que de todo Latinoamérica” destaca Felipe Pascual, Brand Manager de Crystal Lagoons.
BOOM DE LAGUNAS
Crystal Lagoonse Inmobiliaria Aconcagua ya suman once proyectos en distintas etapas de desarrollo en todo Chile, siendo uno de los más emblemáticos Laguna del Sol, el primer resort urbano de primera vivienda con laguna navegable de la Región Metropolitana, que se inauguró el año pasado llevando vida de playa a pocos minutos de Santiago y convirtiéndose en una revolución inmobiliaria impensada. Este proyecto ha sido un récord de ventas desde el lanzamiento de su primera etapa, vendida completamente a pocas semanas de su apertura.
El concepto y tecnología de Crystal Lagoons es transversal a distintos segmentos socioeconómicos. La Portada es uno de los ejemplos de proyectos residenciales en Chile que cuentan con una laguna cristalina, donde destacan además Laguna del Sol (Padre Hurtado), Laguna Norte (Lampa) y Laguna Santiago (Cerrillos). Estos “Resorts Urbanos”, están orientados a familias de clase media, y cuentan con un pedazo del caribe en el corazón de las ciudades. Adicionalmente están marcando tendencias innovadores proyectos de segunda vivienda como por ejemplo San Alfonso del Mar (Algarrobo) y Las Brisas (Santo Domingo).
Crystal Lagoonse
En cercanías del volcán Copiapó, Brigadistas de Kinross Maricunga realizan exitoso rescate
Last changed: may 04, 2012 20:07 by Editor Portal Minero Labels: kinross, maricunga, rescate
![1335800082.jpg [ignored]](/download/attachments/31981831/1335800082.jpg?version=1&modificationDate=1336000207000)
30 de Abril de 2012.- Sin problemas fueron socorridas tres personas extraviadas en las cercanías del Volcán Copiapó, a unos 60 kilómetros de Mina Maricunga, al norte de la laguna del Negro Francisco,por la Brigada de Rescate de Kinross Maricunga. Los extraviados iban a bordo de una camioneta e informaron que estaban atrapados desde las 15 horas deljueves26 de abril. Tan pronto se tuvo conocimiento del extravío de las tres personas que viajaban en una camioneta de la empresa contratista Tiffi, que no presta servicios a Kinross Maricunga. Esta dispuso la búsqueda de los extraviados destinando para ello una motoniveladora, dos camionetas todo terreno y un paramédico. La camioneta perdida se ubicó a eso de las 23:30 hs. del viernes 27 de Abril a los pies del Volcán Copiapo. La unidad de rescate llegó al lugar de los hechos luego de ocho y media horas de búsqueda, procediendo de inmediato a proporcionar la asistencia médica y logística necesaria a las personas extraviadas. In situ se pudo verificar que las tres personas se encontraban sin problemas de salud y en buenas condiciones generales. Los ocupantes fueron identificados como José Castillo, Claudio Cabrera y Rubelindo Catalán, quienes fueron trasladados al Campamento de Compañía Minera Maricunga, donde fueron chequeados por médico, pernoctaron y fueron trasladados a la ciudad de Copiapó en la mañana de este sábado. Kinross Maricunga
2012/04/27
Especialistas en procesos de negocios se reunieron en la USM Campus Santiago
Last changed: may 02, 2012 19:10 by Editor Portal Minero Labels: utfsm
En la tercera edición del seminario BPM&SOA, organizado por el BPM Center, los asistentes pudieron interiorizarse en las últimas tendencias del Business Process Management.

27 de Abril de 2012.- La evolución del Business Process Management en la región, además de sus tendencias, factores críticos y modelos, fueron las temáticas tratadas en el tercer seminario BPM&SOA, organizado por el BPM Center de la Universidad Técnica Federico Santa María, y que se desarrolló en su Campus Santiago San Joaquín.
“La Universidad, desde su perspectiva formativa, y la empresa desde su misión productiva deben ser el bastión del crecimiento inmediato de las naciones. Y por ello creo en las capacidades de todos para aportar en la generación de conocimientos de punta en una nueva herramienta que en el corto plazo será muy útil para mejorar la gestión en los procesos de negocios. Me refiero al Business Process Management, o BPM, que combina a la perfección la gestión de procesos de negocio y las tecnologías de la información”, señaló en su discurso de apertura, José Rodríguez, Rector de la Universidad Técnica Federico Santa María.
Durante el encuentro, expusieron destacados exponentes en procesos de negocios, como David García, Director Nacional de Procesos y Leopoldo Cárdenas, Vicerrector de Procesos y Tecnologías de la Corporación Santo Tomás; Ricardo Zengin, Founder & CEO de Guru YU; Alberto Bethke, Socio de Olivia Consultoría; el Dr. Pierre Hadaya, de la Universidad de Quebéc; el Dr. Marcos Sepúlveda, de la PUC; Arturo Barrios, Gerente de Gestión de Procesos de BancoEstado; Álvaro Flores, Sub Jefe del Departamento de Tecnologías y Procesos de Organización de FONASA; y Bernhard Hitpass, Director Ejecutivo de BPM Center del Departamento de Informática de la Universidad Santa María.
“El tema hoy en día no se trata de seguir explicando qué es BPM, sino que actualmente el interés se enfoca en analizar los factores críticos como elementos condicionantes para el logro de objetivos y la obtención de resultados, introduciendo BPM en tanto las instituciones públicas como privadas “, comentó el Director Ejecutivo del BPM Center, Bernhard Hitpass.
“Recomiendo que, según lo que hemos ido observando en la práctica, separen el gran tema de BPM como disciplina que integra muchas disciplinas parciales en dos grandes áreas: primero BPM Governance como disciplina de gestión corporativa, y segundo a BPM operacional como disciplina de gestión de un proceso de negocios o de una línea de negocios que abarcan un modelo de negocios en conjunto a sus procesos”, agregó el especialista.
Cabe indicar que en el encuentro, los asistentes también tuvieron la oportunidad de visitar la Feria BPM & SOA, exposición que reunió en un solo lugar a los principales proveedores de consultoría, soluciones y tecnología de BPM (Business Process Management) y SOA (Service Oriented Architecture) en Latinoamérica.
UTFSM
Perú tiene cartera inversión de proyectos auríferos por más de US$8,000 millones
Last changed: may 02, 2012 19:10 by Editor Portal Minero Labels: snmpe, oro, auríferos, proyectos, perú

27 de Abril de 2012.- El Perú cuenta con una cartera de inversión en proyectos auríferos estimada en 8,250 millones de dólares que será difundida en el marco del Décimo Simposium Internacional del Oro y Segundo Foro de la Plata, que es organizado por el Comité Aurífero de la Sociedad Nacional de Minería, Petróleo y Energía (SNMPE).
Así lo anunció el presidente del Comité Aurífero de la SNMPE, José Miguel Morales Dasso, al informar que el lema que identifica a esta nueva edición del Simposium, que se realizará en Lima del 14 al 16 de mayo próximo, es “Oro y Plata: Un mundo de oportunidades”.
El Perú -informó- registra una producción anual de oro de 164 toneladas (al cierre del año 2011), lo que le ha permitido consolidarse como el sexto productor mundial al concentrar el 6% de la producción internacional de este metal precioso.
La minería aurífera de nuestro país tiene un potencial aún por desarrollar, manifestó Morales Dasso, al señalar que la cartera de proyectos identificadosdemandará una inversión futura de aproximadamente 8,250 millones de dólares.
Entre los proyectos más importantes – explicó-figuran Conga en Cajamarca, que representa una inversión de aproximadamente 4,800 millones de dólares y Chucapaca en Moquegua con un estimado de inversión de 1,500 millones de dólares.
También figuran los proyectos Chaquicocha (US$ 400 millones) y Shahuindo (US$ 185 millones) en Cajamarca; La Arena (US$ 360 millones) y Lagunas Norte – Ampliación (US$ 400 millones) en La Libertad; Ollachea (US$170 millones) y Pucamarca (US$ 120 millones) en Tacna; e Inmaculada (US$ 315 millones) en Ayacucho.
El presidente del Comité Aurífero de la SNMPE manifestó que en el Décimo Simposium del Oro y Segundo Foro de la Plata tiene como objetivo difundir la riqueza aurífera y argentífera que tiene nuestro país con el fin de alentar nuevas inversiones.
“Para el sector minero peruano es importante atraer nuevos capitales para poder hacer realidad los proyectos auríferos y argentíferos, pues es necesario impulsar el crecimiento de la producción de oro que en el año 2011 se mantuvo igual en relación al año 2010 (164 toneladas)”, refirió.
Asimismo, en el caso de la plata, dijo que urge revertir la caída de 6 % que registró la producción (3,414 toneladas) en el 2011 frente a las 3,640 toneladas del período 2010.
El presidente del Comité Aurífero de la SNMPE, expresó que el Décimo Simposium Internacional del Oro y el Segundo Foro de la Plata, tienen como propósito difundir el gran potencial geológico aurífero y argentífero que posee América Latina, así como fortalecer el posicionamiento de la región como centro de inversión y negocios.
De otro lado, -anotó- se buscará fomentar la formación de clusters mineros destinados a crear polos de desarrollo en Latinoamérica, revisar las experiencias mundiales en materia de responsabilidad social y dar a conocer la importancia que tiene la actividad minera para el desarrollo del Perú.
SNMPE
Premian el emprendimiento e innovación en Chile
Last changed: oct 08, 2012 11:45 by Webmaster Labels: premio, innovación, fundación, chile
La iniciativa organizada por Fundación Chile –a través de su Fondo de Exploración y Red de inversionistas- y el Estudio Jurídico Albagli Zaliasnik, tiene como objetivo desarrollar nuevas ideas y potenciarlas para que sean exitosas en su salida al mercado 27 de Abril de 2012.-
EmprendeFCh, ChileGlobal Angels y el Estudio Jurídico Albagli Zaliasnik, lanzarán un concurso denominado “Partner Up”, orientado a promover emprendimientos tempranos que contengan un importante componente de innovación, altas posibilidades de generar un impacto económico y potencial de escalabilidad en sus modelos de negocio, dentro de las áreas de Alimentos, Biotecnología y TICs. El objetivo es dar valor al desarrollo de nuevas ideas y potenciarlas para que sean exitosas en su salida al mercado, potenciando el desarrollo del emprendimiento e innovación en Chile. El primer lugar recibirá un año de asesoría legal de la Firma Albagli Zaliasnik, equivalente a $20 millones, y el segundo lugar obtendrá una asesoría anual equivalente a $10 millones. Además, el Fondo de Exploración y ChileGlobal Angels, le dará a los participantes la posibilidad de presentar sus iniciativas antes sus comités de inversión para conseguir capital y expertise relacionado con la gestión del proyecto. Las mejores ideas de negocio se presentarán ante un jurado, quien los evaluará durante la realización deun seminario que se efectuará el 20 de junio de 2012 y donde se dará a conocer el proyecto ganador, dando cierre al concurso. Las postulaciones estarán abiertas hasta el 25 de mayo y los participantes deberán completar un formulario descargable en el sitio web de Emprende FCh (www.emprendefch.cl/postula/partnerup) o en el sitio del estudio (www.az.cl/partnerup), y enviarlo al correo emprende@fundacionchile.cl antes de esa fecha. Fundación Chile
Solminihac encabeza junta de accionistas de Codelco y destaca buenos resultados
* Los buenos resultados expuestos en la Junta de Accionistas reflejan la voluntad del Gobierno y de Codelco para que la empresa cuprífera se mantenga como líder mundial en la industria del cobre.*

27 de Abril de 2012.- El ministro de Minería, Hernán de Solminihac, junto al titular de Hacienda, Felipe Larraín, encabezaron al mediodía de hoy la segunda junta de accionistas de Codelco, donde los máximos ejecutivos de la empresa estatal dieron a conocer los resultados que la cuprífera obtuvo durante 2011.
Al respecto, Codelco tuvo un record en producción de toneladas de cobre fino que llegó al millón 735 mil toneladas. También destacó la utilidad neta de 2.055 millones de dólares, un 9% superior a 2010. En cuanto a los excedentes antes de impuestos, estos alcanzaron los 7.033 millones de dólares, esto es un 21,2% superior al año anterior.
“Los resultados expuestos en la Junta de Accionistas, así como los proyectos de inversión contemplados para el quinquenio reflejan la voluntad tanto de Codelco como del Gobierno en cuanto a que la empresa estatal se mantenga como líder mundial en la industria del cobre”, afirmó Solminihac.
En los buenos resultados se dieron factores tales como el alto precio que tuvo el cobre el año pasado, promediando los cuatro dólares por libra. Asimismo, por el incremento en la producción, pese a las bajas en las leyes de los minerales y al aumento en los costos de la industria. Solminihac destacó al respecto que Codelco “fue la única empresa, de los más grandes productores de cobre del mundo, que aumentó su producción en 2011”.
Inversión
Cabe destacar los 27.000 millones de dólares que Codelco se ha propuesto invertir en sus proyectos por los próximos cinco años. Cifra que demuestra la voluntad de la empresa y del Gobierno por mantener a la cuprífera como líder mundial en la industria del cobre.
Está presupuestado que 17.000 millones de dólares sean asignados a proyectos estructurales para incrementar la base de producción y enfrentar los actuales desafíos productivos de Codelco.
“Estos dineros permitirán explotar nuevos yacimientos y ampliar los actuales, con el fin de contrarrestar la baja en las leyes minerales de las faenas que se encuentran en operación”, destacó el ministro Solminihac.
Algunos ejemplos son Chuquicamata Subterránea, el nuevo nivel de la mina el Teniente, la expansión de Andina y Radomiro Tomic.
Los 10.000 millones de dólares restantes serán utilizados para mantener operaciones continuas de las instalaciones, mejorar la productividad de la empresa en sus áreas organizativas y de información, con el fin de enfrentar eventuales escenarios de precios menos favorables. También se trabajará en la sustentabilidad, en la seguridad laboral de las faenas y en la responsabilidad social respecto a las comunidades aledañas a las operaciones.
Respecto del financiamiento de las inversiones, se decidirá a junio de este año, considerando las necesidades de la empresa, la disponibilidad de financiamiento en condiciones favorables y teniendo presente los requerimientos sociales por recursos públicos y los equilibrios en las cuentas fiscales.
Ministerio de Minería
Premio Nacional de Ciencias Exactas 2011 visita la USM
Last changed: may 02, 2012 19:09 by Editor Portal Minero Labels: usm, ciencias, exactas, premio

27 de Abril de 2012.- Importantes aportes en el área de la educación han marcado la carrera del Premio Nacional de Ciencias Exactas 2011, el académico Patricio Felmer, quien en el marco de la inauguración de la nuevas dependencias del Departamento de Matemática de la Universidad Técnica Federico Santa María revisó las principales implicancias de su innovador proyecto "Herramientas para la formación de Profesores de Matemáticas".
Según precisó quien hoy es considerado uno de los matemáticos más talentosos del país, se trata de una colección de monografías temáticas para la formación de profesores de enseñanza media. “Incluye material especialmente elaborado para los futuros profesores de las más distintas áreas de la matemática como álgebra, análisis numéricos, probabilidades, etc. Todo esto presentado a través de una metodología que resulta más amigable para los estudiantes”.
Con este trabajo, agregó el ingeniero, “también se busca involucrar a los matemáticos que normalmente están abocados en el desarrollo de distintas investigaciones en la enseñanza de esta disciplina, dado el gran aporte en que esto se puede traducir a la hora de enseñar. De hecho, muchos de los que participaron en el desarrollo de estas monografías están hoy trabajando en proyectos ligados a la educación”.
Felmer también precisó que existen muchos temas que no son tratados adecuadamente en las escuelas de pedagogía, como por ejemplo, lo que se refiere a estadísticas y probabilidades y las monografías que diseñamos pretenden mejorar esa área de formación. “Percibíamos que había un mayor énfasis en materias como ecuaciones diferenciales, tema ampliamente conocido y utilizado por los ingenieros y si bien es bueno que un profesor conozca sobre ello, esto debe estar orientado a un tema más conceptual que operacional”, indicó destacando también que “un ingeniero debe tener buenas herramientas de cálculo, pero un profesor no necesariamente, porque no va a enseñar esa materia, aunque si es necesario que entienda el contexto porque significa un gran aporte”.
Cabe destacar que Patricio Felmer se tituló de Ingeniero Matemático de la Universidad de Chile en 1983 y es Magíster y Ph. D. en Matemática de la Universidad de Wisconsin. Además, participó fuertemente en la creación del Centro de Modelamiento Matemático (CMM) de la Universidad de Chile, donde actualmente es investigador y miembro del comité directivo, junto con ser profesor titular desde 1998 en el Departamento de Ingeniería Matemática de esa casa de estudios.
UTFSM
Pirquineros del Sindicato Minero de Andacollo se capacitan para operar su máquina de sondajes

27 de Abril de 2012.- Faustino Sarria ha trabajado hace más de treinta años como pirquinero, literalmente abriendo túneles en la roca con gran esfuerzo y tesón. Si bien se reconoce como un hombre de gran experiencia minera, no tiene temor en aprender cosas nuevas, “que nos ayuden a hacer el trabajo más sencillo”, reconoce.
Faustino es uno de los ocho pirquineros que durante esta semana recibió el entrenamiento para el uso de una máquina de sondajes de diamantina de 1 pulgada de diámetro, diseñada para realizar trabajos de exploración asociados a la minería de menor escala, es decir, es especial para faenas de Pequeña Minería.
El Sindicato de Pirquineros de Andacollo se adjudicó como gremio el año 2009 este equipo en comodato, a través del instrumento PAMMA FOMENTO del Ministerio de Minería, sin embargo, la inducción que recibieron en ese momento fue mínima y nunca había podido utilizarse. Por ello, la SEREMI de Minería de la Región de Coquimbo, después de muchos esfuerzos gestionó nuevamente un curso gratuito, práctico e intensivo en contenidos con la empresa Tassaroli Ltda. quien el 2009 se había adjudicado la licitación de venta de este equipo al Ministerio.
Pero según explica la SEREMI de Minería Jocelyn Lizana, dicha capacitación no será el único paso a seguir para garantizar el uso prolongado de este equipo, sino que la autoridad realizará otras tres etapas más.
En primer lugar la construcción de un manual mínimo de uso que será confeccionado por nosotros en base a lo instruido en la capacitación, en segundo lugar, la Geóloga del Programa de Desarrollo y Regularización de la Pequeña Minería ("Programa Mineros de Ley"), Blanca Gana, realizará capacitación en terreno para enseñarles a decidir donde sondear y cómo cuidar, almacenar y procesar la información que obtengan de sus sondajes y en tercer lugar, se verá con Sercotec u otro servicio, como enseñarles habilidades comerciales como gremio, para que además de atender a sus socios, puedan entregar servicios de sondaje, a otros pequeños mineros de la Región y eso les permita financiar la operación y mantención de esta maquinaria a bajos valores para los usuarios de su propio Sindicato.
La SEREMI fue explícita, "la idea es que antes de cuestionarlos y quitarles una maquinaria entregada en comodato por el Ministerio dado que la tenían en desuso absoluto, les demos la instrucción para que nos demuestren que son capaces de hacerse cargo de este tipo de herramientas de alto valor. De ahora en adelante, deberán demostrar que se la pueden y vale la pena apoyarlos. Conozco a mis viejitos mineros y sé que no nos defraudarán".
Ante esta experiencia que la SEREMI conoció al asumir su cargo, ella ha exigido que antes de adjudicar un beneficio del PAMMA Fomento, a gremios o personas individuales que postulan, ellos deben presentar buenos proyectos de administración de los equipos que ellos desean que se les adjudique y a la fecha los resultados han exitosos, ha aumentado considerablemente el nivel de uso por parte de los pequeños mineros y el cuidado de los mismos, así mismo, se están mejorado continuamente los cursos de inducción cuando se entrega un equipo.
La capacitación de sondajes referida comenzó este martes 24 de abril, y consistió en la perforación en terreno durante tres días de la Mina Las Azulitas. Los ocho pirquineros aprendieron conceptos básicos de una operación de sondaje, así como descripciones del equipo y aspectos como la presión, rotación, empuje.
De acuerdo a Leonardo Alfaro, coordinador regional de la Pequeña Minería, “estuvieron un poco tensos al principio, pero tienen ganas de aprender y han demostrado muchas ganas. Si ellos se aplican, podrán manejar esta máquina en un tiempo prudente”.
Seremi Minería Coquimbo
Ministerio de Energía anuncia segunda prórroga del Decreto de Racionamiento Preventivo
Con éste se extienden una serie de medidas que tienen por objetivo darle mayor seguridad y estabilidad al Sistema Interconectado Central.

27 de Abril de 2012.- Tomando en consideración las proyecciones fundadas respecto de un eventual déficit de generación en el Sistema Interconectado Central (SIC), que se extiende desde Taltal a Chiloé y abarca al 93% de la población, el Gobierno ha decidido prorrogar el decreto de racionamiento preventivo hasta el 30 de agosto de 2012.
El objetivo de este decreto, es evitar, manejar, disminuir o superar los déficit de generación que se puedan producir en el SIC, así como también preservar la seguridad en el sistema, mediante ciertas medidas orientadas a reducir sus impactos para los usuarios, a incentivar y fomentar el aumento de capacidad de generación en dicho sistema, a estimular o premiar el ahorro voluntario y a aminorar los costos económicos que dichos déficit puedan ocasionar al país.
El Decreto de Racionamiento preventivo original (Decreto Supremo Nº 26) se publicó el 9 de febrero de 2011, y posteriormente se prorrogó (Decreto Supremo Nº 58) en agosto del mismo año. Mediante el Decreto Supremo Nº38, que se publicará el lunes 30 de abril, se está realizando la segunda prórroga.
Cabe destacar que la prórroga de este decreto no significará ninguna alteración en la vida de los chilenos, ya que sólo se están extendiendo medidas que fueron adoptadas hace más de un año, y que se centran en generadoras y distribuidoras, no en los clientes residenciales.
Algunas de las medidas contempladas en este Decreto, son, entre otras:
1. Las empresas generadoras y distribuidoras quedan autorizadas para adoptar medidas tales como promover disminuciones del consumo de electricidad y pactar con sus clientes reducciones de consumo.
2. Se establecen estándares de calidad y continuidad de servicio especiales y provisionales, mediante los cuales se autoriza a las distribuidoras reducir la tensión nominal de suministro en el punto de conexión de sus clientes y a la Dirección de Operación del CDEC-SIC a aplicar, excepcionalmente, reducciones de tensión o de reserva operacional, en caso que ello permita reducir el déficit en el sistema o bien aumentar las reservas hídricas.
3. Se flexibilizan los plazos para proceder a la conexión de nuevas instalaciones.
4. Se autoriza la operación en condiciones especiales de ciertas instalaciones. Por ejemplo, en transmisión se autoriza a operar ciertas instalaciones con un estándar de seguridad que permita mayores flujos de potencia.
5. Se establece la acumulación de una reserva hídrica en los embalses del sistema para enfrentar contingencias durante el período de racionamiento. A diferencia de lo ocurrido con el anterior Decreto de Racionamiento Preventivo, éste determina que la reserva hídrica que debe acumular el sistema es de 312 GWh, mientras que el anterior establecía una cifra de 500 GWh. Ahora, con la dictación de este Decreto de Racionamiento, es la Dirección de Operación del CDEC-SIC quien debe determinar, con miras a preservar la seguridad el sistema, los embalses en que dicha reserva deba ser acumulada.
Ministerio de Energía
René Aguilar, nuevo Director de Seguridad y Salud del
International Council on Mining and Metals (ICMM).
Last changed: may 02, 2012 19:09 by Editor Portal Minero Labels: codelco, council, mining, metals

27 de Abril de 2012.- El próximo 1 de mayo René Aguilar, asumirá como nuevo Director de Seguridad y Salud del International Council on Mining and Metals (ICMM)en Londres, entidad internacional que reúne 21 compañías mineras y 32 asociaciones del rubro, cuyo objetivo es enfrentar los principales desafíos en desarrollo sustentable de la industria.
Aguilar, sicólogo laboral de la Universidad de Valparaíso, MBA de la Pontifica Universidad Católica y Magister en Dirección de Recursos Humanos de la Universidad Adolfo Ibáñez, ocupó hasta marzo de este año el cargo de Gerente de Seguridad y Salud Ocupacional de la Corporación y será el primer latinoamericano que accede a ese nivel en el ICMM.
Con más de 10 años de experiencia en la División El Teniente, René Aguilar asumió en febrero de 2011 la Gerencia de Seguridad y Salud Ocupacional de Codelco. En 2010, formó parte del equipo de la Corporación que participó en el rescate de los 33 mineros atrapados en la mina San José.
Codelco
2012/04/26
La escasez de energía pone en peligro US$100.000 millones de proyectos de inversión mineros en Chile
Last changed: may 02, 2012 19:09 by Editor Portal Minero
Chile tiene que sumar 8.000 megawatts a su sistema eléctrico de 17.000 megawatts para 2020, según los cálculos de la Comisión Nacional de Energía. La industria minera representa alrededor de un quinto de la demanda de energía del país.

26 de Abril de 2012.-
La mayor serie de proyectos de cobre de la historia corre peligro debido a que Chile, el mayor productor del mundo, tiene dificultades para contener la creciente oposición a unas nuevas centrales eléctricas.
Proyectos para alcanzar 5.000 megawatts de capacidad como mínimo, incluida una central a carbón de US$5.000 millones propuesta por el multimillonario brasileño Eike Batista, sufren demoras o han sido archivados en momentos en que compañías como BHP Billiton Ltd. y Anglo American Plc invierten US$100.000 millones en proyectos de cobre y metales en Chile.
El país, que sufrió un apagón esta misma semana, tiene que ampliar su capacidad en un 47 por ciento en ocho años para ir al compás del consumo. Manifestantes de distintos sectores, desde pescadores a estudiantes universitarios, se oponen a las centrales, lo que ha llevado a los mineros a pensar en sus propios proyectos para contribuir a satisfacer la demanda de cobre de China.
“Chile tendrá que desechar muchas de las inversiones del país en minería debido al alto costo y la escasez de electricidad”, dijo el 19 de abril en Santiago Joaquín Villarino, presidente del Consejo Minero, grupo de lobby en minería. Las demoras pondrán en peligro una parte “significativa” de las inversiones mineras propuestas, agregó.
BHP Billiton, la mayor compañía minera del mundo, podría solicitar ofertas para construir una central eléctrica en el norte de Chile, dijo el 10 de abril Peter Beaven, responsable de la filial de metales base de la compañía con sede central en Melbourne. Teck Resources Ltd. está en conversaciones con proveedores de energía para construir centrales eléctricas en el Desierto de Atacama para abastecer a su mina de Quebrada Blanca, informó el diario de Santiago La Tercera el 21 de abril.
Chile tiene que sumar 8.000 megawatts a su sistema eléctrico de 17.000 megawatts para 2020, según los cálculos de la Comisión Nacional de Energía. La industria minera representa alrededor de un quinto de la demanda de energía del país.
Terremoto
Las líneas de transmisión dañadas por un terremoto de magnitud 8.8 ocurrido el 27 de febrero de 2010 también necesitan inversiones. La red estará expuesta a sufrir apagones durante años, dijo el ex ministro de Energía de Chile Rodrigo Álvarez el 17 de febrero. El último corte de energía tuvo lugar esta semana y afectó desde la capital, Santiago, hasta la región meridional de Los Lagos el 23 de abril.
El precio de la energía en la red central de Chile aumentó de aproximadamente US$100 el megawatt hora a comienzos de 2010 a más de US$150 el megawatt hora a fines de 2011, según el Ministerio de Energía.
“Es un desafío del que el gobierno es bien conciente –la necesidad de garantizar que el desarrollo económico no se vea limitado por la falta de energía-”, señaló John MacKenzie, responsable de la filial de cobre de Anglo, en una entrevista del 10 de abril en la capital chilena.
Álvarez renunció tras un conflicto relacionado con los subsidios a los combustibles en la región sureña de Aysén. El presidente Sebastián Piñera entonces nombró a Jorge Bunster el 3 de abril como su quinto ministro de Energía en dos años.
Oposición de ambientalistas
La oposición de los ambientalistas y los grupos comunitarios está retrasando la construcción de proyectos eléctricos, incluido el de HidroAysén en la Patagonia, que se convertiría en el mayor generador de energía del país, según Villarino.
HidroAysén, que está siendo desarrollado por Colbun SA y la Empresa Nacional de Electricidad SA, generaría 2.750 megawatts para la red central de Chile. La estatal Codelco, el mayor productor de cobre del mundo, opera tres minas en esa región del país. El año pasado, la aprobación del proyecto desató protestas que llevaron a cientos de detenciones y costaron millones de dólares en daños a la infraestructura pública.
HidroAysén todavía no ha recibido aprobación para construir una línea de transmisión de 1.900 kilómetros (1.180 millas).
MPX Energía SA, controlada por Batista, tiene demorado su proyecto luego de que los pescadores obtuvieron una orden judicial para interrumpir su desarrollo. La planta suministrará energía a las nuevas minas propuestas por Freeport McMoRan Copper Gold Inc. y Teck.
GDF Suez
En 2010, Piñera pidió a GDF Suez, la mayor operadora europea de redes de gas natural, que desechara sus planes de construir una central eléctrica a carbón de 540 megawatts en la zona costera de Barrancones debido a la oposición de los ambientalistas.
Xstrata Plc se asoció a Origin Energy Ltd. de Australia para desarrollar su proyecto hidroeléctrico Energía Austral en el sur de Chile.
“El riesgo energético es significativo y tenemos que asegurarnos de que los riesgos han sido debidamente reducidos”, dijo Charlie Sartain, responsable de la división de cobre de Xstrata, en una entrevista del 17 de abril.
Las importaciones de gas natural licuado a Chile pueden incrementarse a través de las dos terminales de GNL que ya operan en el país, dijo Beaven de BHP.
El gobierno ha adoptado un papel más importante en la toma de decisiones para mejorar el suministro de energía en Chile, declaró el máximo responsable ejecutivo de Codelco Diego Hernández en una entrevista del 18 de abril en Santiago. Anteriormente, el gobierno se limitaba a regular el sector, añadió.
Piñera apunta a lograr un crecimiento económico promedio del 6 por ciento durante su mandato de cuatro años como parte del objetivo de convertir a Chile en un país desarrollado en 2018. Ese plan depende de la aprobación de los proyectos energéticos, según un discurso del 28 de febrero.
“Si no ganamos esta batalla para tener energía barata, limpia y segura, no seremos un país desarrollado”, dijo Piñera.
Mostrador
Endress+Hauser realizó con éxito la Reunión “Global Primaries & Metal Network - SIG” en Chile
Last changed: may 02, 2012 19:09 by Editor Portal Minero Labels: endress+hauser, reunion, global

26 de Abril de 2012.- Por primera vez en el país, Santiago fue la sede de una reunión doble orientada a fortalecer la estrategia del Grupo Endress+Hauser en el mercado de Minería y Metales. La agenda de trabajo consideró la revisión de proyectos de inversión, intercambio de experiencias con otros países mineros y la organización de las fábricas con las necesidades de este mercado. La actividad se hizo luego de la presentación de la compañía en Expomin 2012.
Dada la importancia que tiene el mercado minero en Chile, la decisión fue reforzar la acción del Centro de Ventas en el país, donde además reside el Centro de Competencia Minería, responsable de la ejecución de grandes proyectos mineros en Chile y la región.
El “Global Primaries & Metal Network Meeting” se realiza todos los años en diferentes parte del mundo. En esta ocasión fue liderada por ejecutivos del Holding de Endress+Hauser y de E+H Instruments International. Junto a ellos, miembros de las fábricas de sensores de flujo, nivel, presión; temperatura, equipos analíticos y tecnologías de comunicaciones digitales. Por parte de los centros de venta, asistieron delegados de Australia, Sudáfrica, Francia, Chile y Brasil. A ellos, se sumaron ejecutivos de Xtrata Process Control (Canadá) como invitados.
Xstrata tiene desde el 2008 una organización que atiende los temas de control de procesos para sus operaciones mineras de todo el mundo, donde lleva relaciones estrechas con proveedores claves, como es el caso de Endress+Hauser.
El SIG Meeting (Strategical Industry Group) se efectuó a continuación de la primera reunión, también se extendió por dos días, y fue su primera versión. En ella se establecieron los lineamientos de la industria de Minería y Metales y el aporte de las fábricas en término de mejora de equipos y de I+D para futuras tecnologías. Cabe destacar que recién el año pasado este mercado se agregó como estratégico dentro de los objetivos del Grupo.
Durante la semana de trabajo, además se concertaron reuniones en empresas de ingenieríaaprovechando la presencia del Representante de Endress +Hauser en Perú, Corsusa S.A.
Endress+Hauser
BASF ofrece a la industria minera una amplia gama de soluciones para reducir el consumo energético

26 de Abril de 2012.- BASF, la compañía líder mundial en productos químicos a través de su filial Aislapol -el mayor transformador de Poliestireno Expandido en Chile – presentó una amplia gama de soluciones y productos destinados a la minería, orientados a reducir consumo energético y aumentar el confort ambiental.
Una de las soluciones considera una línea especial de paneles termo aislante para la construcción en Chile. Los paneles Aislapol están recubiertos con acero galvanizado prepintado al horno, lo que impide la corrosión tanto interior como exterior. Las láminas de acero del panel están premunidas de hendiduras en forma de canales que junto al núcleo de poliestireno expandido de 20 Kg/m3 de densidad confieren una excelente resistencia mecánica frente a esfuerzos de pandeo, flexión y cargas de viento.
Los productos Aislapol prácticamente no absorben humedad, calificando para ser utilizados en regiones y en recintos con altos porcentajes de ella. Son dimensionalmente estables, es decir, no pierden espesor frente a solicitaciones mecánicas producidas durante el transporte, la instalación o la mantención. Son versátiles, lo cual posibilita resolver múltiples singularidades propias de la construcción. Poseen gran resistencia físico mecánica, lo que posibilita utilizarlos como relleno estructural en obras civiles u otras aplicaciones similares.
A la vanguardia en grandes proyectos Adicionalmente, presentó Geofoam, se trata de una versión especial de Aislapol especialmente orientada a obras civiles y geotécnicas.
Al considerar la magnitud de los proyectos que involucra el desempeño de terraplenes (carreteras; vías férreas; puentes; protección de tuberías; etc.), se puede tener una idea de los costos de mantenimiento y operación que genera reparar las grandes deformaciones involucradas en este tipo de obras a lo largo de su periodo de servicio.
Procesos y soluciones constructivas tales como el uso de pilotes; drenajes del subsuelo; sustitución parcial o total del suelo existente; procesos graduales de sobrecarga; drenaje vertical; etc., son normalmente usados y/o considerados para solucionar esta clase problemas, no siempre con los mejores resultados.
Una alternativa a esta clase de soluciones constructivas la constituye el reemplazo de este material de baja capacidad de soporte por otro de mejores características mecánicas y cuyo peso sea notablemente inferior al del material tradicional, lo que se conoce como terraplén liviano. Existen variadas alternativas de materiales y/o mezclas de ellos que lo pueden constituir, una de las cuales consiste en el uso de Geobloques de poliestireno expandido o Aislapol, técnica que se conoce como Geofoam.
Sustentabilidad Aislapol responde cotidianamente al concepto de conducta responsable mediante la mejora continua y control de cada uno de los procesos productivos, concepto aplicado también al manejo, distribución, uso y disposición de cada uno de nuestros productos.
La gestión ambiental preventiva aplicada a estas actividades ha permitido obtener la distinción especial de producción limpia por parte de ASIQUIM. Aislapol participa, a su vez, junto a BASF de las mesas de trabajo de Chile Green Building Council, institución que vela por el crecimiento sustentable, con foco en construcción, tanto a nivel nacional como internacional y posee ISO 9001: 2008, lo cual lo destaca respecto a sistemas de gestión y calidad.
Aislapol S.A., el mayor transformador de Poliestireno Expandido del país, trabaja hace casi 40 años en avances tecnológicos y estándares de calidad en el manejo de la materia prima Styropor. Con sus dos modernas plantas en Santiago y Puerto Montt y, una bodega comercial en Concepción, abastece los requerimientos de todo el mercado nacional satisfaciendo las necesidades en los rubros de construcción, embalaje, en los sectores, acuícola, agrícola, forestal y hortícola, refrigeración, industrial y consumo.
BASF
Chile GBC define créditos que serán considerados como Prioridad Regional local para la Certificación LEED®
Last changed: may 02, 2012 19:09 by Editor Portal Minero Labels: green, buildingcouncil, leed
El Comité Técnico de Chile Green Building Council realizó un análisis y evaluación de las áreas importantes a incluir en este crédito.

26 de Abril de 2012.- Dentro de las áreas de evaluación LEED®, tales como Ahorro en el uso del Agua; Materiales y Recursos; Sitios Sustentables; Calidad del Ambiente Interior; Energía y Atmósfera; y la Innovación en el Diseño del Proyecto, existe también un criterio de Prioridad Regional que prioriza un proyecto de acuerdo a la zona donde se esté construyendo.
En este sentido, Chile Green BuildingCouncil se propuso evaluar la prioridad regional para el país, idea planteada en el último LEED® International Roundtable, realizado en octubre pasado en Toronto, Canadá.
Para ello, el Comité Técnico del Directorio de Chile GBC encabezó una serie de reuniones con asesores LEED® y profesionales del área, con la finalidad de abordar las necesidades y potencialidades a nivel nacional, las que se basaron en los documentos Mejores Políticas para el Desarrollo (OCDE 2011); Proyecto 20/20 y Agenda para el Cambio Climático, Cumbre de Durban (Instituto Libertad y Desarrollo); Diagnóstico Nacional de Edificios Públicos (Instituto de la Construcción); Estrategia Nacional de Energía (Gobierno de Chile); entre otros. Luego del trabajo y análisis efectuado, se identificaron 6 áreas a priorizar en base a las necesidades locales: Trabajo; Descentralización; Calidad de Vida; Eficiencia Energética; Recurso Hídrico y Manejo de Residuos.
José Ignacio Gana, Gerente Técnico del Chile GBC, señaló que, “finalmente y luego de un exhaustivo análisis logramos seleccionar los siguientes créditos: Crédito MR 5 (Materiales Regionales), Crédito SS 7,2 (Efecto Isla de Calor, Espacios Cubiertos), Crédito IEQ 8,1 (Luz natural y Vistas, Luz Natural), Crédito EA 2 (Energías Renovables dentro del Sitio), Crédito WE 3 (Reducción del uso del Agua) y Crédito MR 2 (Manejo de Residuos de Construcción). Se podrá acceder a la puntuación a través de estos créditos (Regional Priority Credits) a finales de mayo, en base a lo informado por el USGBC”.
Green BuildingCouncil
MOP presenta soluciones para mejorar suministro de agua potable en localidad de Lora
Last changed: may 02, 2012 19:09 by Editor Portal Minero

26 de Abril de 2012.- El Secretario Regional Ministerial de Obras Públicas, Juan Espinoza Pacheco, informó que la Dirección Regional de Obras Hidráulicas (DOH) dispuso de un equipo técnico de profesionales para inspeccionar el sistema de Agua Potable Rural (APR) de la localidad de Lora, en la comuna de Licantén, Provincia de Curicó.
La autoridad señaló que el Director Regional de Obras Hidráulicas, Claudio Darrigrandi, y profesionales de la empresa sanitaria Nuevo Sur, visitaron al concejo municipal de la comuna de Licantén, para exponer el diagnóstico de la situación que afecta al suministro de agua potable de la comunidad de Lora. En la oportunidad, Darrigrandi señaló como marco general y de acuerdo a estudios realizados sobre la calidad del agua en esa parte de la Región, “la presencia de hierro y manganeso en la parte alta de la cuenca se debe a la litología propia del sector compuesta por formaciones volcánicas andinas”, esto quiere decir, que “existe una condición natural de las napas de agua en Licantén para contener este tipo de elementos y en altos porcentajes.
A su vez, dependiendo de la concentración de agua en la línea de distribución, se genera turbiedad y mal olor durante periodos alternos en el día. Por esa razón es fundamental que se cumpla con el monitoreo en forma semestral de los parámetros de calidad de la fuente, por parte del comité responsable y se ejecute el procedimiento correcto de cloración, coagulación y filtración de las aguas”, agregó. Por su parte, el Alcalde de Licantén, Héctor Quiero Palacios, agradeció a la actual Administración de la Dirección de Obras Hidráulicas del Maule, “ya que ha puesto a disposición toda la colaboración pertinente para abordar esta situación, recabando antecedentes, asesorando técnicamente y aprontándose en terreno con profesionales junto con la unidad técnica de la empresa Nuevo Sur.
Este tema es prioridad para mí, desde hace tiempo que se viene dando esto, pero ya en esta última fecha esto fue agravándose. Ahora esperamos contar con los recursos para solucionar este problema y así cumplir nuestro compromiso con la comunidad de Lora”, sostuvo el edil. En el encuentro se propuso para el mediano plazo optimizar el proceso de tratamiento de las aguas, reacondicionando la planta, utilizando coagulantes y nuevos filtros.
René Bochée
Encuentro Internacional Energético en Chile,“Grandes Compañías Energéticas Internacionales Presentarán sus Innovaciones en IFT ENERGY 2012”
Last changed: may 02, 2012 19:09 by Editor Portal Minero Labels: ift, energy, 2012, energía, santiago, feria
*• La Feria de Energía más grande de Latinoamérica, contará con la presencia de grandes empresas internacionales que traen innovadoras tecnologías de punta en eficiencia energética.*

26 de Abril de 2012.- Ya es un hecho la presencia confirmada de 72 expositores de más de 18 países del mundo en la Feria Internacional de Tecnologías Energéticas, IFT ENERGY 2012 que se desarrollará los próximos días 9, 10 y 11 de mayo en el centro de eventos Espacio Riesco. Patrocinada oficialmente por el Ministerio de Energía, el evento será el más grande del sector energético en Latinoamérica.
La Feria de Energía, contará con 4.500 mt2 construidos en stand de exhibiciones y ocho salones de conferencia donde se realizarán mm ás de 50 foros, debates y charlas técnicas que marcarán 155 horas de exposiciones sobre las últimas innovaciones tecnológicas energéticas patrocinadas por la Compañía IBM, empresa que está trabajando fuertemente en el área de las Redes Inteligentes o Smart Grids, para hacer ciudades con un consumo eficiente de energía.
El evento será respaldado por importantes compañías internacionales del sector energético en sus diferentes líneas de productos, entre las que destacan los sponsor oficiales com EPD Solar Systems, compañía española experta en proyectos de paneles solares fotovoltaicos; NIAGARA Conservation, compañía norteamericana especializada en conservación de agua y energía; GREEN Power, compañía española líder en aplicación de tecnología de punta en equipos energéticos; DVA Global Energy Services, empresa española consultora experta en desarrollo de proyectos de eficiencia energética; RES Americas, compañía norteamericana experta en parques eólicos y energías renovables; DNB Bank ASA, Entidad financiera de origen noruego que invierte fuertemente en proyectos de energía renovable; Industrial Info Ressources, empresa que realiza investigación y entrega información para el sector industrial; CAF Banco de Desarrollo de América Latina, organización bancaria con sede en Venezuela y que dentro de sus unidades de negocios presenta el programa PROPEL, Programa Especial de Financiamientos Para Energía Limpias, destinado a medianos y pequeños emprendimientos en el sector energético sustentable y CNEEC, China National Electric Engineering, compañía consultora china, que entrega certificación internacional a grandes empresas mundiales del sector energético.
Además de los sponsor oficiales, estarán presentes enIFT ENERGY 2012 importantes empresas del sector entre las que podemos mencionar a ENEL Green Power, AES Gener, Grupo Enersis, Pratt Whitney, Geotek, entre muchas otras. Destaca además, la gran cantidad de entidades privadas y gubernamentales, cámaras de comercio, departamentos comerciales y organizaciones vinculadas a la energía que están apoyando a este gran evento mundial de la energía.
IFT ENERGY 2012
Enex Cumple Cinco Años sin Accidentes en Minera Candelaria
Last changed: may 02, 2012 19:09 by Editor Portal Minero Labels: enex, candelaria, accidentes
Este importante logro refleja el valor que la Empresa Nacional de Energía le asigna al cuidado de las personas y del entorno, más aún en un área de alto riesgo como la minería.

26 de Abril de 2012.- Tras una destacada gestión en seguridad preventiva en el transporte y suministro de combustibles y lubricantes Shell, la Empresa Nacional de Energía, Enex S.A., cumplió cinco años sin accidentes con tiempo perdido en la operación de minera Candelaria, equivalentes a 700 mil horas-hombre y 2 millones de kilómetros recorridos. Este importante logro refleja la consistencia del trabajo que la compañía ha llevado a cabo en seguridad laboral, y que le ha valido el reconocimiento por parte de la firma estadounidense Freeport-McMoRan Copper & Gol, con quien Enex mantiene una alianza estratégica de largo plazo.
Al respecto, Juan José Jutronich, gerente de ventas zona norte de combustible industrial de Enex, indicó que “éste es un logro sumamente importante y muy valorado por la compañía. Para Enex, la seguridad es un tema de primera línea, por lo que todos estamos involucrados y comprometidos para garantizarla en cada faena. Constantemente somos evaluados por nuestros clientes y como socios estratégicos debemos generar confianza y colaborar con el cumplimiento de sus objetivos”.
El trabajo en conjunto con Candelaria se ha extendido por más de 16 años, sustentado en el interés común por ofrecer un servicio de excelencia, privilegiando el cuidado del medioambiente y la seguridad. “Cada año, la minera realiza auditorias periódicas a las empresas que trabajan en las faenas, para evaluar los estándares que se deben alcanzar desde el punto de vista de salud, seguridad y medioambiente, con revisiones in situ de las operaciones. Luego, a partir de este diagnóstico, la compañía realiza un ranking anual en el que Enex siempre ha estado dentro de los primeros lugares”.
Alcanzar cinco años sin accidentes no es común en la minería. El desarrollo e implementación de nuevos programas y herramientas en seguridad, que Enex ha gestionado en sus operaciones, es altamente valorado por las empresas del sector, debido a que existe una alta exposición a muchos riesgos en la actividad diaria. “Además, cualquier interrupción del servicio podría generar pérdidas muy importantes, por lo que una buena gestión incide en la posibilidad de establecer nuevos negocios”, explicó Jutronich.
El servicio de abastecimiento va de la mano del cuidado medioambiental, con la preocupación de no generar derrames ni contaminar los terrenos donde están ubicadas las faenas.
Enex entrega a las compañías mineras un valor agregado en sus servicios de abastecimiento, por lo que en conjunto se construye una alianza estratégica, más que una relación entre proveedor y cliente. Lo principal es asegurar el suministro de combustible y lubricante. Juan José Jutronich agregó que “este reconocimiento nos motiva para continuar acumulando años sin incidentes y seguir con el buen trabajo que hemos llevado a cabo”.
Enex
Subsecretario Iglesias destaca fuerte caída en tasa de accidentes laborales fatales durante el 2011
Según la autoridad durante el 2010 fallecieron 246 trabajadores por accidentes laborales, mientras que el 2011 esta cifra bajó a 185.

26 de Abril de 2012.- Una importante noticia dio a conocer este jueves el subsecretario de Previsión Social, Augusto Iglesias, junto a la fiscal de la Superintendencia de Seguridad Social, Lucy Marabolí, al entregar los resultados de las tasas de accidentabilidad y mortalidad delaño 2011 al Consejo Consultivo de Seguridad y Salud en el Trabajo.
“Quiero destacar el resultado que obtuvimos durante el 2011 en materia de fatalidades, yaque logramos pasar de 246 trabajadores muertos en accidentes laborales a 185 el 2011”, manifestó el personero de gobierno al tiempo que aclaró que pese a que este resultado es “positivo, no marca tendencia” y lo que necesita el país es “seguir trabajando duro en materia de prevención para que lleguemos ojalá algún día a tener cero accidentes fatales”.
“Así, mientras el año 2010 hubo que lamentar el fallecimiento de 246 trabajadores por accidentes laborales, el año 2011 esta cifra bajó a 185 trabajadores, sin considerar los accidentes de trayecto”, agregó.
De esta forma, la tasa de mortalidad es la más baja en la última década, que muestra un promedio cercano al 7x100.000.
El subsecretario calificó esto como una “muy buena noticia”, y enfatizó que lo que se requiere ahora es “perseverar en los esfuerzos por seguir mejorando las condiciones de trabajo, especialmente en el segmento de empresas medianas y pequeñas”.
A su vez, Lucy Marabolí de la Superintendencia de Seguridad Social (Suseso) explicó que estás cifras “están relacionadas con elSeguro de Accidentes del Trabajo de la Ley 16.744, las que muestran que al 2011 existían sobre cinco millones de trabajadores cubiertos de los cuales 4.100.000 están afiliados a las mutuales de empleadores”.
Respecto al leve aumento que registró la tasa de accidentabilidad, al pasar de un 5,4 el 2010 a un 5,5 el 2011, la abogada justificó lo anterior por “un incremento en la cantidad de trabajadores protegidos por el seguro entre un año y otro”.
Por otra parte, Héctor Humeres, presidente del Consejo Consultivo de Seguridad y Salud en el Trabajo, señaló que los resultados de accidentes “no han cambiado significativamente desde el año 2008, lo que ratifica la importancia y necesidad de hacer un esfuerzo adicional en materia de modernización del sistema de seguridad laboral”.
Ministerio Trabajo
2012/04/25
Seremi de Minería de Coquimbo comienza a atender público en nuevas dependencias de Illapel
Last changed: may 02, 2012 19:09 by Editor Portal Minero
Desde este miércoles 25 de abril, los mineros del Choapa cuentan con una oficina provincial donde se atenderán sus demandas.

25 de Abril de 2012.- Con el objetivo de cumplir los compromisos adquiridos en el Programa de Regularización y Desarrollo de la Minería de Menor Escala, “Mineros de Ley”, la SEREMIA de Minería de la Región de Coquimbo anunció la apertura de una oficina en la ciudad de Illapel, cumpliendo así uno de los anhelos de los mineros de la provincia del Choapa.
El nuevo recinto deberá hacerse cargo de llevar adelante operaciones de regularización de faenas en las comunas de Illapel, Salamanca, Los Vilos y Canela; recibir las postulaciones a los programas PAMMA en Capacitaciones y Proyectos; y atender los problemas de los mineros del Choapa en general.
Al respecto, la SEREMI de Minería, Jocelyn Lizana señaló que “esto nos permite descentralizarnos, acercar el Ministerio de Minería a una provincia minera, brindando todo nuestro apoyo y además dar el ejemplo a otras regiones, dado que somos la primera en Chile que tendrá atención en provincia desde la creación de las Seremías de Minerías”.
Asimismo, el Coordinador Regional de la Pequeña Minería, Leonardo Alfaro, explicó que “esta oficina en Illapel es una solicitud realizada desde hace muchos años por los mineros de la provincia, y gracias a las gestiones del Senador Uriarte y del Gobernador Iván Cisternas con el Ministerio de Minería, más los fondos del Gobierno Regional, se hace posible un sueño anhelado por los pirquineros del Choapa”.
Las nuevas dependencias de la Secretaría Regional Ministerial de Minería estarán ubicadas en la calle Constitución N° 389. Segundo Piso, Of. N°15. La funcionará a cargo será Maribel Chávez, Ingeniera de Medio Ambiente, que ejercerá el cargo de Coordinadora Provincial de la seremía de Minería en Choapa.
Seremia Minería de Coquimbo
En Antofagasta, TTM capacita en nuevas tendencias en transporte de minerales
Last changed: may 02, 2012 19:09 by Editor Portal Minero Labels: ttm, curso, antofagasta, tecnologías
La compañía realiza periódicamente seminarios técnicos con el objetivo de instruir en nuevas tendencias y tecnologías en esta área, y en eficiencia energética a sus clientes y socios.

25 de Abril de 2012.- TTM, empresa con operaciones en Chile, Perú y Bolivia, y dedicada a proveer soluciones tecnológicas y soporte a la gestión minera en el ámbito de los Sistemas de Transporte de Mineral, realizó recientemente en la ciudad de Antofagasta una nueva charla técnica orientada a sus clientes, con fin de optimizar el proceso productivo de cada uno de ellos, mediante el desarrollo de la eficiencia y continuidad de su flujo de mineral.
La exposición de TTM tuvo por objetivo difundir toda su experiencia en materia de Eficiencia energética en sistemas transportadores, Raspadores de alta tecnología, Correas transportadoras de última generación, y Polines con larga duración y ahorro energético, además de abordar know-how de la compañía y sus socios estratégicos, donde se analizaron los principios detrás de cada elemento, su rol en un sistema integral y cómo se puede lograr una operación más eficaz y eficiente.
“Mediante estas charlas, los clientes reciben las herramientas para mejorar las especificaciones de componentes en sus proyectos, además pueden contar con toda la información técnica que les permita definir claramente cuáles son las variables de decisión que deben considerar al momento de realizar compras tan importantes como correas, polines, raspadores, etc. Inversiones que no son menores y que deben tener un real impacto en el desempeño eficiente del sistema transportador. De esta manera, se pueden minimizar las reinversiones a lo largo de la operación de la planta, mejorando así los valores actuales netos y tasas internas de retorno de cada proyecto”, señaló Waldo Díaz, gerente de Sucursal Antofagasta de TTM en Chile.
Asimismo, el encuentro también tuvo como misión exponer los desarrollos e innovaciones tecnológicas que apuntan a lograr la mayor eficiencia energética en esta área. Además, se abordaron otros temas, como los factores determinantes en la eficiencia energética de un sistema de transporte de minerales; la experiencia práctica ante este desafío, y el diseño y especificación de componentes que cumplan con este requisito. Particularmente se presentaron casos exitosos de eficiencia energética implementados en Chile, como es el caso de los polines de alta duración y ahorro energético que están funcionando en Codelco Andina.
En esta ocasión, los participantes fueron un grupo selecto de trabajadores y ejecutivos de Minera Escondida, Termoeléctrica ECL, Termoeléctrica AES GENER, Ultraport, Fundición AltoNorte, Minera Franke, y Minera El Peñón.
TTM
Rockwell Automation realizó Curso de Actualización del Sistema DCS PlantPAx

25 de Abril de 2012.- Rockwell Automation, empresa líder en procesos de automatización, realizó un Curso de Actualización Tecnológica del Sistema DCS PlantPAx a sus Integradores de Procesos, con el objetivo de potenciar sus soluciones para la industria nacional, especialmente enfocadas al rubro minero.
Estas actualizaciones se efectúan de forma continua durante el año y buscan mantener informado con los últimos desarrollos, capacidades y novedades a los profesionales de Rockwell Automation y al grupo de compañías que trabajan con ellos, a través de un entrenamiento avanzado, donde se incluyen charlas temáticas yentrenamientos prácticos, tanto comerciales como técnicos.
En esta oportunidad,durante tres días de presentaciones, demostraciones y laboratorios prácticos, participaron el grupo de Proyectos y de Servicios de Rockwell Automation y las tres empresas integradoras de sistemas especializadas en el Área de Procesos: Tunning Automatización, DPA Ingeniería y Ceskat Ingeniería.Estas compañías, incluidas en el programa de Proveedores de Soluciones de Procesos, proveen amplios conocimientos y experiencia en las principales áreas industriales en Chile, con especial énfasis en Sistemas de Control de Procesos.
“Con estas Actualizaciones nuestros profesionales e integradores de procesos están preparados para enfrentar nuevos proyectos del rubro de la minería en Chile. Lo que permite complementar la oferta, a través del Sistema DCS PlantPAx. Es importante destacar que más de 25 personas participaron en estos tres días de entrenamiento, proveyendo al mercado un grupo de profesionales altamente capacitados en el DCS PlantPAx”. Manifestó Patricio Gómez, Gerente Regional de Procesos para América Latina de Rockwell Automation.
En este sentido, la empresa busca una aproximación con sus clientes, mediante la entrega de mejores soluciones. Por lo mismo se encargan de mantener actualizado y entrenado a sus integradores y al propio equipo de Rockwell Automation, con el fin de entregar una garantía de proyectos y servicios eficientes y de calidad.
Rockwell Automation
Ventyx LinkOne Introduce Capacidades Innovadoras de Visualización 3D Para Catalogación Electrónica de Componentes
La versión más reciente del catálogo electrónico de piezas líder de la industria, permite ordenar partes de manera más rápida y precisa, para optimizar el mantenimiento de los activos críticos.

25 de Abril de 2012.- Ventyx, una empresa del grupo ABB, anunció recientemente que ha añadido a su catálogo electrónico de piezas y manuales de mantenimiento Ventyx LinkOne, visualización en 3D de gran alcance, con capacidades interactivas precisas o "hot pointing".
Con esta nueva funcionalidad, Ventyx LinkOne WebView 3.7 mejora significativamente la capacidad de los gerentes de mantenimiento y de otros usuarios finales, de visualizar gráficamente el ensamblaje de un producto - localizando un componente en cuestión de segundos, permitiendo realizar las órdenes de partes de manera más rápida y efectiva. Al mismo tiempo, los fabricantes de maquinaria industrial y otro equipamiento pesado pueden entregar un contenido más completo en formato LinkOne, proveyendo a clientes y distribuidores de una solución para la gestión de partes más avanzada y diferenciada, que puede ayudar de manera más eficiente a impulsar las ventas de repuestos.
"LinkOne WebView 3.7 lleva la gestión electrónica de piezas al siguiente nivel, proporcionando a los clientes tecnología de punta para reducir al mínimo el tiempo de inactividad del negocio y de la maquinaria, al tiempo que proporciona a los fabricantes las herramientas necesarias para distinguirse de sus competidores y generar mayores ingresos en el mercado de partes”, afirmó John Benders, Vicepresidente de Soluciones de Industrias Intensivas en Activos de Ventyx. "Los modelos en 3D se han utilizado tradicionalmente sólo en el ámbito de la ingeniería, sin embargo, con LinkOne, Ventyx sitúa las capacidades de visualización 3Den manos de los profesionales de mantenimiento y fabricación, para una gestión y pedidos de partes electrónicas más avanzada”, explicó.
Ventyx LinkOne está considerado como el estándar de facto para los catálogos electrónicos de piezas en la industria minera. Ventyx LinkOne es empleado por algunas de las compañías mineras más grandes del mundo, así como porcuatro de los cinco mayores fabricantes mundiales de maquinaria pesada, para proveer los catálogos electrónicos de piezas a sus clientes. LinkOne también es utilizado por los operadores de mantenimiento de activos en energía, petróleo, gas, defensa e infraestructura pública.
Además de proporcionar la capacidad de visualizar y manipular modelos 3D de piezas y ensamblajes, LinkOne WebView 3.7 introduce capacidades interactivas precisas “hot pointing” cuando se observa un modelo del producto en 3D. Esta capacidad vincula automáticamente los componentes de un modelo de producto a las listas de precios correspondientes, garantizando que el pedido de partes sea el correcto. Esta característica también permite a los modelos 3D ser utilizados como una herramienta para navegar rápidamente un libro o un catálogo de piezas LinkOne.
Adicionalmente, Ventyx LinkOne WebView incluye ahora una integración “out-of-the-box” (lista para utilizar) con Microsoft SharePoint, proporcionando un método alternativo para las organizaciones, de vincular el contenido con un libro LinkOne sin tener que republicar el libro original. Una vez que la asociación entre los documentos de SharePoint y los libros LinkOne se ha establecido, el documento de SharePoint aparece como un ítem adicional en la tabla de contenidos LinkOne en el lugar apropiado.
Algunas de las nuevas mejoras incluyen:
- Notificaciones “Push”. LinkOne WebView introduce la capacidad para que los usuarios sean notificados directamente cuando el contenido en el catálogo electrónico de piezas, haya sido alterado.
- Replicación de Bibliotecas Masivas. Ahora que los fabricantes de equipos mantienen grandes bibliotecas de libros LinkOne en todo el mundo, la última versión incluye una documentación nueva de herramientas para ayudar a asegurar que las bibliotecas completas se mantengan sincronizadas.
Ventyx LinkOne es un catálogo de piezas de gráfica digital, que hace más eficientes los procesos de mantenimiento de equipos y gestión de las piezas mediante la integración de datos de las mismas a través de múltiples fabricantes, conectando los gráficos con la información crítica de las piezas. Con un solo clic, los usuarios no sólo pueden ver la información específica de una parte, sino también toda la información asociada a ésta, como instrucciones de servicio, el asesoramiento de pedidos, instrucciones de seguridad, o la lista completa de piezas.
Ventyx
Schreder Chile ilumina plaza de armas de Osorno con luminarias calla led
Last changed: may 02, 2012 19:09 by Editor Portal Minero Labels: schréder, chile, led, osorno

25 de Abril de 2012.- Schréder Chile se adjudicó un proyecto en virtud del cual efectuó la reposición de 60 luminarias tipo globo de 210 W de sodio, por 60 luminarias Calla LED de 26 watts, que destacan por su elegancia y funcionalidad, siendo ideales para el alumbrado y decoración de áreas verdes, tales como plazas, parques y paseos peatonales, entre otras zonas urbanas.
Estas luminarias con forma de flor, disponibles en color blanco y blanco neutro, están equipadas con 15 LEDs y poseen 105 Lúmenes por LED, permitiendo un consumo eficiente de energía eléctrica y un adecuado alumbrado y sensación lumínica, mejorando la calidad de vida de las personas.
Amigable con el medioambiente, la luminaria Calla LED es resistente a los impactos (IK 07) y altamente hermética (IP 66), permitiendo, además, una fácil instalación y mantenimiento.
Para dar a conocer más detalle de ésta y otras luminarias, la Escuela de Iluminación Schréder, EIS, dicta charlas y cursos gratuitos, tanto en sus instalaciones como en terreno.
Schréder Chile
INACAP y AII unen fuerzas en pro del Capital Humano
Last changed: may 02, 2012 19:09 by Editor Portal Minero Labels: inacap, aii, convenio, colaboración
Lineamientos estratégicos de cada organización buscan asociatividad para fortalecer el desarrollo de las personas de la región.

25 de Abril de 2012.- Con el objetivo de gestionar beneficios mutuos orientados por la necesidad de fomentar los aspectos inherentes a los propósitos institucionales y de desarrollo regional de cada organización, la Asociación de Industriales de Iquique (AII) y la Universidad Tecnológica de Chile, INACAP, firmaron un convenio de colaboración mutua en pro de un mejor desarrollo del Capital Humano de Tarapacá.
Así lo dieron a conocer la gerente general de la AII, Izaskun Bengoechea y el vicerrector de INACAP Iquique, Arnoldo Imalay, quienes se dieron cita en la sala de capacitación de la AII este miércoles 25 del presente, para ofrecer una conferencia de prensa y firmar el acuerdo.
“Desde fines del año pasado hemos reorganizado los focos estratégicos de nuestro gremio y entre ellos, nuestro directorio determinó que el fortalecimiento del Capital Humano es esencial en la gestión que debemos realizar hacia nuestros socios. Por ello y como las proyecciones de la industria, en su generalidad son auspiciosas en este ítem, es que hemos puesto especial énfasis en esta línea, sobre todo considerando que la demanda será tanto en términos de cantidad como de calidad. En este sentido, para nosotros es muy importante la firma de este convenio con INACAP, no sólo por ser uno de nuestros socios, sino que también porque han venido desarrollando un eficiente trabajo de formación y vinculación de las personas con la industria de la región y por cierto, estamos dispuestos a contribuir también con ellos, de acuerdo a los nuevos lineamientos estratégicos que la AII tiene”; explicó la gerente general de los Industriales de Iquique.
En tanto, para el vicerrector académico de INACAP esta firma es parte de una serie de vínculos que han venido realizando con los gremios y principales actores regionales, en virtud del trabajo que realizan a diario. “También estamos muy satisfechos de concretar esta alianza estratégica con la AII, ya que hace un par de años nos asociamos y hemos sido miembros activos, por lo que ahora y siempre siguiendo la línea de contribución con la industria que tiene INACAP, queremos colaborar con el gremio a través de todo nuestro know how, así como también con nuestras investigaciones de carácter clástico y toda nuestra infraestructura”.
La firma del convenio quedó registrada en dos ejemplares que se entregaron a cada una de las partes y contó además con la presencia de autoridades de INACAP, ejecutivos de la AII y medios de comunicación local.
Inacap
Antofagasta Minerals premió a SODEXO
por su excelente gestión en Relaciones Laborales en Minera Los Pelambres
Last changed: may 02, 2012 19:09 by Editor Portal Minero Labels: sodexo, amsa, premio

25 de Abril de 2012.- Antofagasta Minerals premió -por segundo año consecutivo- en la categoría de “Gran Empresa”, a la multinacional francesa SODEXO, Líder Mundial en Soluciones de Calidad de Vida Diaria, por la connotada gestión Relaciones Laborales, en el contrato de Minera Los Pelambres, faena ubicada en las cercanías de Salamanca, provincia de Choapa, Región de Coquimbo.
La octava versión de premiación anual de las empresas colaboradoras del Grupo Minero, fue encabezada por el presidente del Directorio de Antofagasta Minerals, Jean-Paul Luksic, quien entregó la máxima distinción a Janet Awad, Gerente General de SODEXO Chile.
Dicho galardón dejó en evidencia la excelente gestión que realiza Sodexo con los más de 500 colaboradores que se desempeñan prestando los servicios de alimentación, hotelería y recreación, consolidándose de esta manera como socio estratégico de la compañía minera.
En este marco, la actividad contó además con la asistencia del Subsecretario del Trabajo y Previsión Social, Bruno Baranda; autoridades de Gobierno nacional, regionales, organismos gremiales y ejecutivos del Grupo Antofagasta Minerals, de las distintas compañías mineras del grupo y de las empresas colaboradoras de cada una de ellas.
Sodexo
Foro Económico Mundial y CESCO, Líderes de la minería y el Gobierno acuerdan reforzar iniciativas de integración económica y social que impulsen el desarrollo en Chile
Last changed: may 02, 2012 19:09 by Editor Portal Minero Labels: cesco, foro, mundial, cobre
Ministro de Minería, ejecutivos mineros y agentes sociales buscan extender el impacto económico y social de la actividad minera en Chile

25 de Abril de 2012.- Tenemos amplias oportunidades de mejora en la forma en que la minería contribuye al desarrollo del país pero nuestro comportamiento como industria requiere reforzar el trabajo colaborativo", dijo el Ministro de Minería Hernán de Solminihac al término de la reunión con más de 40 representantes de alto nivel de empresas, gobierno, y sociedad civil que se celebró el pasado miércoles dentro de las actividades de la Semana CESCO.
En Chile se percibe necesaria creación de espacios de diálogo para que todos los grupos de interés se sumen a la acción de crear una agenda de trabajo común para impulsar el desarrollo económico que la actividad minera induce en la economía chilena. Entre ellas destaca el impulso para robustecer una industria de bienes y servicios para la minería de categoría mundial, y el avance en las relaciones comunitarias.
En la conversación se destacó la necesidad de crear más y mejor talento para la minería, sin olvidar una mayor incorporación de la mujer al sector. Asimismo, se subrayó la conveniencia crear mesas de diálogo incluyendo a gobiernos centrales y locales, ONGs y representantes de las comunidades.
El enorme volumen de inversiones mineras que Chile espera en los próximos años, es una oportunidad única para el desarrollo de una industria de servicios de categoría mundial que permita no sólo dejar un mayor beneficio económico en el país, sino además aprovechar la fuerza del sector minero chileno para mejorar la competitividad del país en el largo plazo.
Uno de los ejecutivos mineros destacó la importancia de la minería como vehículo de desarrollo y el avance de Chile hacia esta meta. Asimismo destaco la oportunidad de creación de valor compartido si todos los actores son capaces de enfrentar los desafíos de manera constructiva y reconocer los desafíos y oportunidades que se presentan con una mirada colaborativa..
Un sector de oportunidades
La minería representa al sector que más contribuye al crecimiento del PIB, a los ingresos fiscales y a las exportaciones del país, y más aún se espera un crecimiento muy significativo de la inversión en los próximos años. Ante estas grandes oportunidades, la reunión analizó alternativas para que este sector dinamice aún más a la economía chilena.
Chile, líder mundial en la producción de cobre, exporta bienes y servicios mineros por unos 250 millones de dólares, un monto muy pequeño en comparación con otras potencias mineras como Australia o Canadá.
Las dos empresas más grandes Codelco y BHP Billiton, han sido pioneras en el diseño de programas de ayuda a los proveedores con dicho fin. Instituciones académicas como la Universidad de Chile o la Universidad Católica cuentan con centros de desarrollo tecnológico para fomentar iniciativas de I+D. Instituciones como CORFO, Fundación Chile y CSIRO (Australia) han puesto en práctica ambiciosos programas de fomento de estas actividades.
El Foro Económico Mundial
El Foro Económico Mundial es una Fundación sin ánimo de lucro que tiene como misión la mejora del estado del mundo y que fomenta el emprendimiento en favor del interés social. Plataforma de dialogo global, imparcial e independiente, el Foro Económico Mundial trabaja en la convención de los sectores público, privado, y de la sociedad civil para tratar asuntos de interesa global. La iniciativa sobre el Desarrollo Minero Responsable es un ejemplo del impacto de esta fundación asentada en Suiza www.weforum.org
Centro de Estudios de la Mineria y el Cobre
El Centro de Estudios del Cobre y la Minería (CESCO) es una organización independiente, sin fines de lucro, constituida en Santiago en 1984. La misión de CESCO es contribuir al diseño y debate de las políticas públicas que permitan el mejor aprovechamiento del potencial de la minería para el desarrollo de las economías de los países productores de minerales y metales. www.cesco.cl
cesco
Minera Doña Inés de Collahuasi reconoce a Tecno Fast Atco como el mejor contratista en términos de seguridad
De las 15 empresas que realizan labores para la Vice Presidencia de Proyectos de Collahuasi, la minera destacó a Tecno Fast Atco y su equipo de trabajo por su gestión de seguridad en 2011 y lograr el record de no tener accidentes durante más de dos años

25 de Abril de 2012.- La Compañía Minera Doña Inés de Collahuasi realizó una jornada sobre seguridad y prevención de riesgo, en la cual se reconoció a la empresa de construcción modular Tecno Fast Atco por su destacada gestión en seguridad durante todo el año 2011, periodo en el que cumplieron dos años de trabajo en 8 faenas de Collahuasi sin ningún tipo de accidentes.
El Vicepresidente de proyectos de Collahuasi, Deepak Bhasin,expresó que Tecno Fast Atco recibió este reconocimiento porque “desde el principio de nuestra relación laboral, TFA ha mantenido un alto estándar en seguridad, efectuando permanentemente mejoras a través de campañas, incentivos yreuniones conjuntas de análisis de desviaciones, que les ha permitido contar con un excelente control de los riesgos en cada uno de sus proyectos”.
Muy orgullosose mostró gerente general de Tecno Fast Atco, Rodrigo Prado, por la obtención de este reconocimiento por parte de Collahuasi. “Para TFA, la seguridad de nuestros trabajadores y usuarios de nuestros productos es un tema prioritario. Por lo mismo, recientemente obtuvimos la certificación OHSAS 18001 sobre seguridad y salud ocupacional, la cual nos exige cumplir con altos estándares en esta materia. Esto sumado a las certificaciones ISO 9001 y 14001, que nos convierte en la única empresa chilena de construcción modular tricertificada, consolidando así un liderazgo sustentable en la industria”, enfatizó.
A la ceremonia de premiación asistieron por Collahuasi el vicepresidente de proyectos Deepak Bhasin, el gerente de prevención de riesgos Llurcan Acuña, superintendente de prevención de riesgos Patricio Portilla, gerente senior César Retamal y el gerente HRT Miguel Ángel Alvarado. Tecno Fast Atco estuvo representado por sugerente general Rodrigo Prado, jefa de prevención Carolina Rojas, y administrador de contrato René González. Además asistieron los ejecutivos de todas las empresas de servicios externos directos que trabajan en la minera
Hasta la fecha, Tecno Fast Atco ha construido para Collahuasi siete proyectos: Ampliación Hotel Pabellón del Inca Wing G, Campamento Pioneros Hitos 1, 2 y 3, salas de recreación norte, salas multiuso y sala de cambio Rosario. Actualmente un equipo de TFA se encuentra levantando la Ampliación Hotel Pabellón del Inca Wing F.
Teco Fast Atco
2012/04/24
Estudio confirma que mina más antigua de toda América estuvo en Taltal, Chile
Last changed: may 02, 2012 19:09 by Editor Portal Minero Labels: mina, san, ramón, doce, mil
Expertos de la U. de Chile descubrieron en 2008 yacimiento indígena de 12 mil años de antigüedad.

24 de Abril de 2012.- En el año 2008, Diego Salazar y un grupo de investigadores de la Universidad de Chile descubrieron una antigua mina en la quebrada San Ramón, al norte de Taltal.
El año pasado los restos encontrados y las cotas analizadas arrojaron su data: entre 10 y 12 mil años de antigüedad.
Hoy la revista Current Archeology confirmó el hallazg el yacimiento encontrado es la mina más antigua de América, y según Conicyt es una de las investigaciones más importantes realizadas en el país durante el 2010.
Se trata de una mina de óxido de hierro, mineral de altísimo valor en la época, pues se usaba para realizar pinturas con fines ceremoniales en los cuerpos de los difuntos y para ornamentar objetos. "Su hallazgo revoluciona la concepción que teníamos de los indígenas que habitaron el área", cuenta aSalazar, refiriéndose a la cultura huentelauquén que habitó la zona entre lo que hoy es Los Vilos y Antofagasta hace 9 y 12 mil años.
Su cultura siempre fue concebida como la de una sociedad básica que recolectaba y pescaba en la costa del norte de Chile. Sin embargo, el tamaño de la mina y la cantidad de extracciones que eran capaces de hacer cambiaron esta creencia.
El yacimiento tiene 40 metros de largo, y por lo menos seis metros de profundidad y fue explotada intensamente por miles de años. "Hemos establecido que durante el tiempo que funcionó sacaron unos 700 metros cúbicos de roca, que equivalen a unas dos mil toneladas. Esto indica que había producción de excedentes y por lo tanto una economía más compleja de lo que pensábamos", explica Salazar. Esto, porque los excedentes de mineral pudieran haber originado un intercambio comercial con otras culturas de las zonas colindantes.
Es por eso que Salazar y el equipo de expertos de la U. de Chile seguirán investigando el lugar en busca de nuevos restos que permitan dilucidar más aspectos de los huentelauquén. "Hoy sólo tenemos rocas y huesos pintados, por lo que los próximos pasos serán determinar con qué indígenas intercambiaban el material y detallar cómo era usado por los mismos indígenas", concluye Salazar.
La Tercera
Ministra Matthei destaca más de 20.000 visitas a feria laboral del gobierno en Santiago
Last changed: may 02, 2012 19:09 by Editor Portal Minero Labels: feria, laboral, matthei, empleo

24 de Abril de 2012.- Con una multitudinaria asistencia se desarrolló hoy la 1ra. Feria Laboral organizada por el gobierno en Santiago, y que ofreció 16.000 puestos de trabajo con más de 100 empresas participantes.
La feria contó con la presencia del Presidente de la República, Sebastián Piñera, y de la ministra del Trabajo y Previsión Social, Evelyn Matthei, quienes recorrieron el lugar y compartieron con las miles de personas que llegaron a la Estación Mapocho en busca de un empleo.
La secretaria de Estado señaló que “el año pasado se hicieron 50 ferias desde Arica a Punta Arenas y se ofrecieron 80 mil empleos. Este año ya hicimos una en Valdivia, en Ovalle, y hoy en la Estación Mapocho. Hay más de 100 empresas que están ofreciendo 16.000 cupos”.
La ministra Matthei destacó que se esperaba para hoy la asistencia de más de 20.000 personas en Santiago, frente a las 18.000 que llegaron a la feria laboral de Santiago de 2011, desarrollada en Providencia.
“Estamos tratando de ayudar lo más posible a la gente para que pueda encontrar un empleo o para que pueda cambiarse a un mejor trabajo. Hay muchas empresas que están buscando gente, porque ya ese cartelito que estaba en todas partes ‘no hay vacantes’, ahora se está cambiando por ‘se necesitan trabajadores’ y eso es bueno”, sostuvo la ministra Matthei.
Por su parte, el Presidente Piñera afirmó que “el trabajo no es sólo ganarse la vida, es un aporte a la familia y al país, y por eso nuestro compromiso con darle a todos los chilenos y chilenas un empleo digno. A eso apunta esta feria, que se va a realizar en todas las regiones del país, a buscar un punto de encuentro entre quienes buscan trabajo y quienes buscan trabajadores. De esa manera avanzamos para cumplir la meta de crear un millón de nuevos y buenos empleos al 2014”.
Entre los 16.000 puestos de trabajo que se ofrecieron durante la feria están: Eléctricos, secretarias, Asesores comerciales, Auxiliares de limpieza, Ejecutivos de venta, bodegueros, choferes, garzones, administrativos, promotores, bodegueros, chef, guardias de seguridad, entre otros.
Desempleo en Gran Santiago
Consultada sobre las cifras de empleo del Gran Santiago a marzo, dadas a conocer hoy por el Centro de Microdatos de la Universidad de Chile, la ministra Matthei señaló que “al comparar con marzo de 2011, el desempleo bajó de 8,7% a 8%, lo que es positivo. Cuando comienza el otoño hay empleos que se acaban en la agricultura, y por eso sube el desempleo por un efecto estacional. Lo correcto es comparar marzo a marzo, y la cifra conocida hoy es buena desde ese punto de vista. Medirla frente a diciembre no tiene ninguna validez”.
Ministerio del Trabajo
IncubaUC llega a China
Last changed: may 02, 2012 19:09 by Editor Portal Minero Labels: incuba, uc, china, negociación, acuerdo
IncubaUC, incubadora de negocios de la Pontificia Universidad Católica de Chile, firma acuerdo que materializa su llegada a China.

24 de Abril de 2012.- El acuerdo fue resultado de una exitosa negociación que se consolidó con la firma de un convenio entre las incubadoras NTI e IncubaUC para la internacionalización de proyectos chilenos al mercado asiático. Gracias a esto IncubaUC podrá inyectar recursos del orden de los $300 millones de pesos a cada uno de los proyectos que deseen instalarse en China para la fabricación y comercialización de tecnología.
La comitiva fue conformada por Marcelo Díaz Bowen, Gerente de IncubaUCy Felipe Bahamondes, Gerente General de DICTUC S.A., quienes visitaron específicamente la ciudad de Changzhou, a 180 Km al oeste de Shanghai, con el objeto de materializar un protocolo de acuerdo cuyo objetivo es permitir a las empresas vinculadas aIncubaUC, que están en fase de aceleración, acceder al Mercado Chino a través de la Incubadora NTI, gestionada por la empresa israelí Shirat Enterprises.
“Gracias al acuerdo con China logramos consolidar la comercialización internacional en Asia y con ello cerramos un ciclo importante en la estrategia de IncubaUC, estableciendo programas de Softlanding para nuestros emprendedores en países referencia de desarrollo de cada línea tecnológica. Por un lado los proyectos TIC irán directo a buscar inversión a Silicon Valley, California, Estados Unidos; mientras que los High-Tech tendrán su destino en China, Israel / Palestina y España”, afirmó Marcelo Díaz Bowen, Gerente de IncubaUC.
El arribo al gigante asiático fue en alianza con el fondo de inversión israelí Shirat Enterprises y con la consultora Golzman Partners for Business con presencia en España y Chile. En Israel las incubadoras son instituciones privadas, de las que un 1/3 de las 26 existentes son controladas en un 1/3 por empresas de capital de riesgo. Estas eligen a los mejores emprendimientos tecnológicos y financian el 15% de los US$600 mil del crédito que entrega el Estado de Israel a cada emprendimiento. A cambio de las mentorías y el apoyo, estas instituciones pueden exigir como pago hasta el 30% de la empresa.
Cabe señalar que Shirat Enterprises es una empresa que forma parte de la red de colaboradores de Golzman Partners for Business, empresa que asesora y representa desde el año 2011 los intereses de IncubaUC en mercados internacionales, con especial énfasis en Europa y Medio Oriente.
“Este acuerdo es un avance muy importante, ya que se abren nuevas fronteras de negocios para los actores de esta triangulación efectiva entre Chile, China e Israel y esperamos pronto llevar a Asia los mejores emprendimientos forjados en nuestro país”, dijo Aarón Golzman, CEO de Golzman Partners for Business.
Incuba UC
PCI Geomatics innovando con nuevas tecnologías para conocer las demandas de la Industria Geoespacial Chilena

24 de Abril de 2012.- PCI Geomatics, un desarrollador líder-mundial de sistemas y software de geoimágenes, publicó recientemente la nueva capacidad en su software de Geomática 2012 que específicamente se añade soporte riguroso y automatizado para FASat-Charlie. La nueva versión de Geomática 2012 Service Pack 2 incluye ahora soporte para FASat-Charlie, un sensor del satélite óptico que se puso en marcha el 16 de diciembre de 2011. El nuevo satélite, que será administrado principalmente por el Ministerio de Defensa de Chile y la Agencia Espacial Chilena, incluye una capacidad de imagen de 1,45 m. pancromática y 5.8 multiespectral.
PCI Geomatics ha trabajado en estrecha colaboración con su socio chileno, GEOSOLUCIONES, para obtener algunas de las primeras imágenes adquiridas por el nuevo satélite, con el fin de poner en práctica métodos automatizados de sensores específicos para la corrección de imágenes, con el fin de crear imágenes ortorectificada de gran precisión directamente. PCI Geomatics es conocida por el desarrollo e implementación de modelos rigurosos de Satélites RSM (por sus siglas en ingles) de forma rápida y eficiente una vez que se lancen nuevos sensores. La nueva RSM está disponible tanto para Geomatica 2012 (SP2) como parael GeoImagingAccelerator de PCI (GXL).
“La capacidad de corregir imágenesrápidamente y de forma precisautilizando las técnicas del estado del arte es un aspecto crítico de los requisitos operacionales para el Ministerio de Defensa de Chile", dijo Peter Hazlett, Gerente del Producto de PCI Geomatics. "La Industria Geoespacial Chilena se beneficiará de la capacidad para la corrección de la imágenes de FASat-Charlie en formarápida y precisa dentro de los software Geomatica y/o GXL. Esto permitiría el desarrollo de aplicaciones nuevas e innovadoras que aprovechen este sensor en combinación con otras imágenes”.
GEOSOLUCIONES
Ministro Solminihac apuesta por movilidad laboral interregional en puestos mineros
Last changed: may 02, 2012 19:09 by Editor Portal Minero
*
Materialización del histórico plan de de proyectos mineros, que alcanza los 91 mil millones de dólares en los próximos ocho años, requiere de numerosos profesionales y técnicos.
*

24 de Abril de 2012.- El ministro de Minería, Hernán de Solminihac, junto al intendente de la Región de Los Ríos, Juan Andrés Varas, al subsecretario de la cartera, Pablo Wagner, y a la seremi sectorial, Marcela Kehr, abrieron esta mañana en Valdivia el primer encuentro de la minería que se desarrolla en el sur del país.
El seminario “La minería al sur de Chile”, que se realiza en la Universidad San Sebastián, busca promover la actividad minera que se desarrolla entre las regiones del Biobío y Magallanes, así como sus nuevos proyectos, entre otros temas.
Durante su intervención, Solminihac abordó la necesidad de incrementar el capital humano para la industria, tanto en carreras profesionales como técnicas, dado que el crecimiento de la oferta académica en el ámbito minero no ha crecido al mismo ritmo que el sector.
Actualmente, dijo el ministro, la industria emplea a más de 250 mil personas. Sin embargo, añadió, para el año 2015 se estima un demanda de 70 mil trabajadores adicionales en empresas mineras.
“Esto representa una gran oportunidad para quienes buscan mejors trabajos. Para enfrentar este desafío, la cartera está articulando una serie de líneas de acción que involucran a los principales actores públicos y privados de la industria, con el propósito de aumentar la oferta de trabajadores calificados para la minería, principalmente de mujeres y jóvenes”, expuso el secretario de Estado.
Ente las iniciativas destacadas por autoridad, están los programas de inserción laboral femenina en la actividad minera y de trabajo con los centros de formación para atraer más jóvenes al sector. También está el plan para mejorar la información laboral disponible y las oportunidades que ofrece el estudiar carreras mineras
En paralelo, precisó Solminihac, la cartera trabaja en acercar la minería a la gente y hacer que los entornos a las faenas mineras sean más atractivos para los trabajadores y sus familias.
Sobre las postulaciones a las ofertas laborales de empleo que lanzó la última feria internacional minera, Expomin, el ministro Solminihac hizo un positivo balance.
“El portal de empleo (www.expomin.trabajando.com) ha recibido más de 178 mil visitas, 25 mil inscritos y más de 23 mil postulaciones. Y lo más importante, es que las vacantes de empleo aumentaron a seis mil ofertas”, informó el titular de Minería.
Un hecho valorado por Solminihac, es que la mayor cantidad de postulaciones corresponden a las regiones de Valparaíso, Metropolitana y Biobío, lo que demuestra una disposición a la movilidad laboral interregional.
Ministerio Minería
La Industria minera en crecimiento y con trabajo argentino
Last changed: may 02, 2012 19:09 by Editor Portal Minero Labels: argentina, bayton, minería

24 de Abril de 2012.- Según datos de la empresa Bayton, “la industria minera, el petróleo y el turismo son tres de los sectores que desarrollaron un crecimiento exponencial" y "acompañaron durante todo el 2011 el ritmo de crecimiento del país".
Las empresas pertenecientes a estas áreas demandaron durante el 2011 operarios y personal especializado (técnicos y profesionales) y "la tendencia continua firme para todo el 2012”, afirmó Ricardo Wachowicz, Presidente de Bayton Grupo Empresario, empresa de capitales argentinos líder en el sector de recursos humanos y con más de 33 años de experiencia.
“Es importante la incorporación de proveedores estratégicos nacionales que puedan contribuir con elementos fundamentales en la cadena de valor como lo es el capital humano; al contratar empresas especializadas en el sector laboral estamos agregando un eslabón más a la cadena del compre nacional con trabajo argentino y registrado”, sostuvo Wachowicz.
Por su parte, Damian Altgelt, Gerente General de la Cámara Argentina de Empresarios Mineros en declaraciones al programa Cultura Empresarial expresó:
“En los últimos 10 años se ha dado un crecimiento muy importante en la Argentina y a nivel mundial dadopor distintos factores, uno de ellos es la sostenida demanda de minerales por países como China, Brasil, India que han venido creciendo internamente y demandado minerales a nivel mundial, esto ha hecho que en latinoamerica haya un crecimiento importante, Argentina forma parte de ese grupo que se ve beneficiado por ese crecimiento y personalmente creo que lo va a seguir haciendo en los próximos años.
Hoy en día estamos entre 600 y 700 proyectos en exploración, en la cual las empresas investigan, averiguan que es lo que hay debajo de la tierra cuanto mineral hay, que calidad tiene, que costo tiene extraerla y luego pasan a la etapa de producción, en esta etapa los proyectos son muchos menos, nosotros decimos que de cada 100 proyectos que hay en exploración, 2, 3 o con suerte 5 son los que pasan a la siguiente etapa. Esta es una de las características por lo cual el sector minero es un sector de muy alto riesgo.
San Juan en muchos sentidos se ha convertido en un modelo de hacia dónde debe ir el sector. Es una provincia que desde el apoyo de sus autoridades ha tenido un crecimiento enorme, muchos proyectos de exploración, empresas en producción, muchos desarrollos de proveedores locales, un derrame en la economía de las comunidades locales creemos que muy superior a lo que sucedía en otras provincias y eso hizo que por ejemplo en Catamarca, la gobernadora Lucia Corpacci quiera reflejar en su provincia lo que se ha hecho en San Juan”.
Bayton
Expropiación de REPSOL YPF en argentina afectará inversiones en sector hidrocarburífero de América Latina
*SNMPE calificó de arbitraria medida dispuesta por gobierno argentino
*

24 de Abril de 2012.- Como una medida arbitraria que afectará el flujo de inversiones hacia el sector hidrocarburífero en América Latina, calificó la Sociedad Nacional de Minería, Petróleo y Energía (SNMPE), la decisión del gobierno argentino de expropiar la empresa petrolera Repsol – YPF.
El presidente de la SNMPE, Pedro Martínez manifestó que la decisión de la administración gubernamental en Argentina en contra de Repsol – YPF, atenta contra la estabilidad jurídica y la propiedad privada; y es una señal nefasta para los inversionistas.
En este contexto, informó que el control de precios aplicado por el gobierno argentino, invirtiendo importante dinero en subsidios, ha originado un desincentivo masivo en inversiones en exploración y explotación de hidrocarburos.
La decisión de nacionalizar YPF vía la expropiación del 51% que le pertenece a Repsol no se justifica en absoluto, afirmó Pedro Martínez, tras señalar que esta medida provocará un impacto negativo para las inversiones previstas en el sector hidrocarburífero de América Latina, pues inversionistas que habían decidido dirigir sus inversiones hacia países latinoamericanos ante la crisis europea ahora reconsiderarán su decisión.
Martínez dijo que no es posible que en la actualidad algunos gobiernos latinoamericanos persistan en la aplicación de medidas populistas y seudo nacionalistas, que la realidad y la historia, han demostrado que no logran bienestar para la población, pues más bien traen consigo menos empleo y más pobreza.
“Al final, quienes paga la factura son los propios consumidores a través de mayores impuestos y de más inflación, como consecuencia del congelamiento de precios, alza de costos, escasez y, posteriormente, ajustes traumáticos para corregir esos garrafales errores, con un altísimo costo para la población”, sentenció.
El presidente del gremio mineroenergético expresó que medidas como las adoptadas en Argentina no tienen espacio en el Perú, porque hoy nuestro país se caracteriza por su estabilidad jurídica, económica y política, así como por el respeto a los contratos y a la inversión privada.
SNMPE
TTM presentó en Expomin innovación y tecnología en sus sistemas de transporte de minerales
Last changed: may 02, 2012 19:09 by Editor Portal Minero Labels: ttm, expomin, transporte, mineral

24 de Abril de 2012.- TTM, empresa con operaciones en Chile, Perú y Bolivia, dedicada a proveer soluciones tecnológicas y soporte a la gestión minera en el ámbito de los Sistemas de Transporte de Mineral, tuvo una destacada participación en la reciente Expomin 2012, realizada en Espacio Riesco y considerada la más importante de su tipo en Sudamérica.
Apoyada de un moderno stand de dos niveles, la compañía exhibió una propuesta multimedia de su oferta integral y tecnológica, destinada a respaldar en forma global la gestión minera en faenas. Asimismo puso al día a los visitantes, acerca a las innovaciones en materia de Componentes de Sistema Transportador y Soluciones de Confiabilidad, junto con una amplia explicación de sus áreas de Ingeniería de Mantenimiento y Project Management, destinadas a entregar un valor agregado y único a cada cliente.
En la ocasión, la empresa difundió su amplía gama de soluciones ligadas a alianzas con socios estratégicos internacionales como Phoenix, Küpper, Hosch, Hese, MMI, Cove y Emsys. En ese sentido el gerente general de TTM en Chile, José Miguel Ballivián, señaló que “son múltiples las nuevas oportunidades de negocio que estamos analizando, pero sin duda el uso de componentes para sistemas de transporte que contribuyan a una mayor eficiencia energética es el foco de nuestro esfuerzo”.
Completó la exhibición, un modelo de conveyor a escala, donde la empresa plasmó sus componentes de última generación y mostró sus aplicaciones tecnológicas en materia de Ingeniería de Mantenimiento. Francisco Carvallo, gerente Comercial de TTM en Chile, señaló que “TTM dispone hace años de un software llamado ‘TTM Insight’ el cual permite a nuestros clientes incrementar la confiabilidad de su flujo de mineral mediante un monitoreo permanente de sus sistemas de transporte y una gestión eficiente de la mantención de estos.”
TTM
Antofagasta Minerals premia a sus empresas colaboradoras por buen desempeño laboral
El grupo minero nacional reconoció la gestión de las empresas colaboradoras que se destacaron durante el año 2011 en sus cuatro operaciones: Michilla, Los Pelambres, El Tesoro y Esperanza.

24 de Abril de 2012.- Con la presencia del Subsecretario del Trabajo Previsión Social, Bruno Baranda, autoridades de gobierno nacional y regionales y organismos gremiales, y encabezada por el presidente del directorio de Antofagasta Minerals, Jean-Paul Luksic, se llevó a cabo en Santiago la octava premiación anual a las empresas colaboradoras de Antofagasta Minerals y sus cuatro operaciones: Michilla, Los Pelambres, El Tesoro y Esperanza.
En la actividad el Grupo Minero premió a tres empresas colaboradoras por cada compañía, además del Centro Corporativo, que se destacaron por su gestión en el ámbito de recursos humanos, en las categorías gran, mediana y pequeña empresa. Asimismo, se destacó a un supervisor de una de las compañías del grupo por la mejor relación laboral con personal propio y colaboradores, el cual recayó en Manuel Carrasco Valderrama, de Minera El Tesoro.
Para definir el premio a las empresas colaboradoras,las compañías cuentan con un modelo de “Convenios de Desempeño” que indica que si los objetivos son cumplidos (accidentabilidad, relaciones laborales, gestión operacional), se da lugar a un incentivo variable que el contratista paga a sus trabajadores una vez al año. Para participar de dicho bono, las empresas colaboradoras participan de una Auditoría Anual al Cumplimiento de la Legislación Laboral, la cual es promovida por Antofagasta Minerals, donde los ganadores deben lograr un porcentaje superior al 97%.
Dentro de las empresas premiadas, en la categoría gran empresa se destacó este año a Servicios Generales Astudillo y Hnos. Ltda., elegida en Minera Michilla por su eficiente gestión de Recursos Humanos y preocupación por el bienestar de sus trabajadores; Sodexho Chile, la cual fue galardonada en Minera Los Pelambres por la gestión de su público interno, el cual es un elemento fundamental para el alcance de excelentes resultados, finalmente Minera Esperanza premió a la empresa TANDEM S.A.
Por su parte en la categoría mediana empresa, Minera Michilla entregó el premio a Proyecta S.A., por sus novedosos sistemas de administración de contenidos. Minera Los Pelambres otorgó el primer lugar a Contitec Chile Ltda., debido a su profesionalismo y responsabilidad, a su vez El Tesoro destacó a la empresa Maquinarias THM S.A. por su constante superación en prácticas laborales, y en Esperanza la empresa P Y C Ltda., por su manejo innovador y profesional de Recursos Humanos.
En la categoría pequeña empresa, Minera Michilla entregó el primer lugar a Elecmain Ltda. Los Pelambres hizo lo propio premiando a la compañía Maquinarias Olmué Ltda., El Tesoro concedió el galardón a Minepro Chile S.A. y finalmente Minera Esperanza premió a Mutual de Seguridad de C.CH.C. Todas estas compañías cumplen con los valores de Antofagasta Minerals y destacan por su permanente espíritu de superación.
El Vicepresidente de Operaciones de Antofagasta Minerals, Hernán Menares,manifestó la relevancia y el valor que tiene el Recurso Humano en las compañías mineras. ”Para nuestra compañía es fundamental que las organizaciones cumplan con altos estándares operacionales, de seguridad y prevención de riesgos, y que además mantengan un cumplimiento de la legislación laboral durante todo el período, lo cual puede ser verificado gracias a nuestros sistemas de control laboral”, explicó.
Por su parte el Subsecretario del Trabajo y Previsión Social, Bruno Baranda, expresó la importancia de premiar a las empresas que cumplan con altos estándares de calidad y servicio. “El Gobierno de Chile está comprometido en que las empresas proveedoras cumplan con las necesidades del cliente. Esta iniciativa es un ejemplo, los invito a que sigan de esta forma y trabajan en conjunto con las empresas, en beneficio de la industria”, concluyó.
Amsa
Henkel logra récord de ventas y resultado
Last changed: may 02, 2012 19:09 by Editor Portal Minero Labels: henkel, resultados, anuales
*Las ventas en Latinoamérica crecieron un 8% a 1.065 millones de euros.
*

24 de Abril de 2012.- Henkel, productora de marcas y tecnologías para las áreas de Detergentes/Productos de Limpieza, Cosmética/Cuidado Corporal y Adhesive Technologies, anunció sus resultados financieros correspondientes al ejercicio 2011.
En un entorno económico desafiante, la compañía aumentó las ventas a 15.605 millones de euros y, con ello, un 3% respecto al valor del año anterior. Orgánicamente, es decir, depurados los efectos del tipo de cambio y las adquisiciones/desinversiones, las ventas aumentaron incluso un 6%. Contribuyeron a esta evolución positiva todas las divisiones.
El beneficio operativo depurado de los ingresos únicos, gastos únicos, así como gastos de reestructuración mejoró un 9% de 1.862 millones a 2.029 millones de euros. Contribuyeron a esta mejora todas las tres divisiones. El beneficio operativo (EBIT) fue de 1.857 millones de euros, un 7% por encima del valor comparable del año anterior. El rendimiento de las ventas depurado (margen EBIT), a pesar del considerable aumento de los precios en los mercados de abastecimiento, aumentó un 0,7%, pasando del 12% al 13% y alcanzó de este modo el valor planificado. El rendimiento de las ventas se situó en un 12%, después del 11% del año anterior.
El superávit anual depurado, después de deducir las participaciones no mayoritarias, aumentó frente al año anterior un 11%, de 1.217 millones a 1.356 millones de euros. El superávit anual se situó en 1.283 millones de euros, frente a los 1.143 millones de euros el año anterior. Después de deducir las participaciones no mayoritarias en un importe de 30 millones de euros, el superávit anual se situó en 1.253 millones de euros (año anterior: 1.118 millones de euros). El resultado por acción preferente (EPS) depurado aumentó un 11% a 3,14 euros frente a los 2,82 euros del año anterior. Sin depurar, el EPS fue de 2,90 euros frente a los 2,59 euros del año anterior.
El Consejo de Dirección, el Consejo Supervisor y la Comisión de Accionistas proponen, a la Junta General, aumentar los dividendos por acción preferente a 0,80 (año anterior: 0,72) euros y los dividendos por acción ordinaria a 0,78 (0,70) euros.
La región de Latinoamérica evolucionó con mucha fuerza y presentó un crecimiento de las ventas del 8% a 1.065 millones de euros. El crecimiento orgánico de las ventas fue de un 11%. Especialmente la evolución comercial en México, Brasil y Venezuela contribuyó a esta mejora.
Puntualmente en Chile, donde Henkel está presente hace 27 años a través del área de Tecnologías Adhesivas, operando en los segmentos de adhesivos selladores y productos para el tratamiento de superficie, con marcas como Agorex, Pritt, Loctite y Liofol, las ventas netas de Henkel Chile en el año 2011, ascendieron a $ 34.068.745 (moneda local), mientras que las ventas netas de Henkel Chile en el año 2010, ascendieron a 31.397.137 (moneda local), lo que implicó un crecimiento orgánico del 8.51% del año 2011 con respecto al año 2010.
“2011 fue de nuevo un año muy satisfactorio para Henkel. A pesar de los grandes desafíos en un entorno económico inseguro, hemos alcanzado totalmente nuestros ambiciosos objetivos y, en parte, incluso los hemos superado. Las ventas y el resultado, son mayores que nunca anteriormente“, afirmó Kasper Rorsted, presidente del Consejo de Dirección. “Un factor fundamental del gran rendimiento de Henkel fue la consolidación de la posición en los mercados en crecimiento, en los que se creció nuevamente en el orden de dos cifras. En 2011 hemos realizado grandes progresos en nuestro camino y puesto las bases de nuestro éxito futuro. Sobre esta base, tenemos gran confianza en alcanzar nuestros objetivos financieros para el año 2012, que formulamos en 2008“.
Respecto al ejercicio 2012, Rorsted comentó: "El entorno económico sigue siendo desafiante, siendo actualmente mucho más volátil que en el pasado. Por este motivo tenemos que adaptarnos continuamente para reaccionar rápida y flexiblemente a los cambios del entorno. Pero, en general, creemos que Henkel está bien preparada. Esperamos un crecimiento orgánico de las ventas entre el 3 y el 5%. Para el margen EBIT depurado calculamos un aumento al 14% y para el resultado por acción preferente depurado, con una mejora mínima del 10%“.
Henkel
Vicepresidente de Cochilco Participa en Reunión Anual
de Grupo Internacional de Estudios del Cobre
Last changed: may 02, 2012 19:09 by Editor Portal Minero Labels: cochilco, giec, reunion, anual

24 de Abril de 2012.- El Vicepresidente Ejecutivo de la Comisión Chilena del Cobre (Cochilco), Andrés Mac-Lean, participará esta semana en la 20° reunión del Grupo Internacional de Estudios del Cobre (GIEC), organización intergubernamental que agrupa a 23 países productores y consumidores de cobre, incluyendo la Unión Europea, cuya sede está en Lisboa, Portugal.
Las reuniones del GIEC se extenderán entre el 26 y 27 de abril de 2012, y en ellas se analizarán aspectos ambientales y económicos de la industria del cobre, entre otros. Tema de especial interés son los reportes estadísticos con las proyecciones del mercado internacional del cobre que entrega el organismo, así como también el análisis de los inventarios de cobre no-reportados por los países. En esta oportunidad se realizará, el 25 de abril, un seminario para analizar cómo la sociedad se beneficia del desarrollo del sector minero.
A este encuentro, el Vicepresidente Ejecutivo de Cochilco asistirá acompañado de la Directora de Estudios y Políticas Públicas de la Institución, María Cristina Betancour.
El GIEC es un organismo intergubernamental que tiene como objetivo principal promover la cooperación internacional en temas del cobre, mejorando la información disponible del mercado a nivel internacional, y proporcionando un espacio para el análisis y discusión intergubernamental sobre este metal.
El GIEC lo componen Australia, Alemania, Bélgica, Chile, China, España, Estados Unidos, Federación Rusa, Finlandia, Francia, Grecia, India, Italia, Japón, Luxemburgo, México, Suecia, Perú, Polonia, Portugal, Serbia y la Unión Europea y Zambia.
Cochilco
Dan a conocer la factibilidad técnica para incorporar ERNC al sistema eléctrico nacional
Last changed: may 02, 2012 19:09 by Editor Portal Minero Labels: acera, ernc, estudio, seminario

24 de Abril de 2012.- Una de las discusiones que hoy está en boga tiene relación con la integración de las energías renovables no convencionales (ERNC) en los sistemas eléctricos nacionales. Es por eso que interesa estudiar y analizar la factibilidad técnica de inserción de ERNC dada la actual configuración del sistema eléctrico nacional. De esta forma, la Asociación Chilena de Energías Renovables (ACERA) entregará los resultados de un estudio denominado “Factibilidad Técnica de la Incorporación de las ERNC al Sistema Eléctrico Nacional”, con el fin de entregar los argumentos al respecto. La investigación fue realizada por el Centro de Energía de la Facultad de Ciencias Físicas y Matemáticas de la Universidad de Chile y liderada por Rodrigo Palma.
La actividad, que se llevará a cabo el próximo 26 de abril en elAuditórium de la SOFOFA desde las 09:00, contará además con la participación de los expertos internacionales Mahesh Marjoria, vicepresidente de Global Grid Integration, y Alvin M. Razon, consultor sénior del Departamento de Energía de Estados Unidos (DOE).
Del mismo modo, expondrán los directores ejecutivos de los CDEC SING y SIC, Daniel Salazar y Eduardo Ricke, respectivamente; Gabriel Olguín, subgerente de estudios de Nuevas Tecnologías de Transelec. Los moderadores de los bloques serán Hugh Rudnick, profesor titular de la Pontificia Universidad Católica de Chile y Ramón Galaz, gerente general de Valgesta.
Junto con la entrega de los resultados delmencionado estudio, el objetivo de la actividad es crear una instancia de análisis, intercambio y difusión con la participación de los CDEC e importantes panelistas nacionales y extranjeros.
De esta forma, se abordarán temas como:
·Qué requieren las ERNC de los sistemas de transmisión y cuál es su impacto sobre ellos ·Cuáles son las implicancias de este tipo de energías sobre la operación del sistema ·Sistema de transmisión seguro y confiable, diseñado para permitir el acceso a todas las fuentes de generación (concepto de carretera y/o multicarrier eléctrico) ·Cómo desarrollar proyectos ERNC que impacten favorablemente en la demanda de los grandes usuarios de energía (clientes libres, industriales, mineros) ·Participación de fabricantes y tecnólogos que facilitan la incorporación de las ERNC en el sistema (nuevas tecnologías, soluciones energéticas eficientes, etc.) ·Institucionalidad sectorial que necesita Chile para el desarrollo de las ERNC hacia el 2020 ·Tendencias Internacionales para el desarrollo (innovación y tendencias) e incorporación de las ERNC
El evento se encuentra enmarcado dentro de una serie de actividades que está realizando ACERA durante 2012 como serán el seminario de Impactos macroeconómico de la meta 20/20 a realizarse en agosto y la primera Feria Eólica y Solar a realizarse en octubre. Esta ocasión será una importante oportunidad para el intercambio de opiniones con autoridades del sector, ejecutivos, profesionales, consultores y docentes vinculados al ámbito de las ERNC en Chile.
ACERA
2012/04/23
Más de 16.000 cupos de empleo ofrecerá Feria Laboral del Ministerio del Trabajo en Santiago
Last changed: may 02, 2012 19:09 by Editor Portal Minero Labels: trabajo, feria, laboral

23 de Abril de 2012.- En su desafío por crear un millón de nuevos y buenos empleos al 2014 y contribuir con la colocación laboral de personas desempleadas, el Gobierno de Chile, a través del Ministerio del Trabajo y Previsión Social, invita a la Feria Laboral de Santiago que se realizará mañana entre las 09:00 y 18:30 hrs. en el Centro Cultural Estación Mapocho (Metro Cal y Canto).
En ella, las 100 empresas participantes pondrán a disposición de los/as interesados/as más de 16.000 cupos de empleo, repartidos en distintos sectores productivos, como comercio, seguridad, retail, agricultura y transporte, servicios, etc.
“Con esta Feria estamos cumpliendo el compromiso del gobierno del Presidente Piñera de crear más y mejores empleos. Chile cumple y el Presidente cumple en este sentido. Esta Feria ayuda a que miles de chilenos encuentren un empleo, o puedan optar a uno mejor”, señaló la ministra del Trabajo, Evelyn Matthei.
Durante la actividad, las empresas participantes realizarán el proceso de reclutamiento y selección de postulantes: recibirán Currículum Vitae y realizarán entrevistas de selección a los asistentes.
A quienes visiten la feria, se les recomienda llevar impresas o en archivo digital tantas copias del su Currículum Vitae como estime necesarias.
“Esta es unaexcelente ocasión para que las empresas presenten sus distintas ofertas de trabajo y, lo más importante, una muy buena oportunidad para que quienes buscan empleo puedan conocer que está ofreciendo el mercado de una sola vez y postular a varias empresas al mismo tiempo”, explicó el director del Sence, Juan Bennett.
Entre los 16.000 puestos de trabajo que se ofrecerán durante la feria están: Eléctricos, secretarias, Asesores comerciales, Auxiliares de limpieza, Ejecutivos de venta, bodegueros, choferes, garzones, administrativos, promotores, bodegueros, chef, guardias de seguridad, entre otros.
Ferias Laborales 2011
El año 2011, el Ministerio del Trabajo realizó a través de Sence 50 Ferias Laborales a lo largo de país. En ella, las 1.113 empresas participantes ofrecieron 74.863 puestos de trabajo. Las ferias convocaron a 96.205 asistentes.
Sólo en Santiago, se puso a disposición de los/as interesados 20.500 cupos de trabajo.
La apuesta de la Gira de Empleo 2012 incluye 70 Ferias laborales, repartidas en las 15 regiones del país.
Bolsa Nacional de Empleo
Durante la actividad, los/as visitantes tendrán, además, la oportunidad de registrarse en la Bolsa Nacional de Empleo, www.bne.cl ( http://www.bne.cl/), portal de oferta y demanda de trabajo más grande del país. El ingreso de sus antecedentes curriculares laborales en la BNE les permitirá ampliar la búsqueda de trabajo.
Ministerio del Trabajo
Minera Los Pelambres presentó su proyecto “Conectados”
Last changed: may 02, 2012 19:09 by Editor Portal Minero Labels: mlp, tics, cetiuc

23 de Abril de 2012.- En una interesante exposición, el gerente de Tecnologías de la Información de Minera Los Pelambres, Cristián Peña, dio a conocer a los asistentes a la conferencia “Desayunos del Club CIO” del Centro de Estudios de Tecnologías de Información, de la Universidad Católica de ChileCETIUC, el proyectos “Conectados”, de la compañía, concitando el interés de sus pares de las principales empresas del país.
La charla indicaba cómo se desarrolló un sistema de información hacia los trabajadores de la compañía y entre ellos mismos, para lograr de esta forma una mayor eficacia en la aplicación de la tecnología dentro de los procesos productivos.
En este sentido, Peña que “la innovación tiene que ver con las perspectiva a cómo estamos haciendo las cosas y de la manera de mirar las necesidades de las personas, de conectarse entre ellas y de cómo necesitan conectarse con la información, el por qué, qué herramientas se pueden ocupar y cómo facilitamos que estas cosas ocurran porque el negocio es netamente humano, es ahí donde se crea el valor, las máquinas solas no hacen nada”, explicó.
Por su parte, el director del Centro de Estudios de Tecnologías de la Información CETIUC, Marcos Sepúlveda, destacó la experiencia que ha tenido Minera Los Pelambres con este proyecto. “La idea es innovadora en el sentido de tratar de pensar no en la óptica del negocio propiamentetal, sino que desde el punto de vista de las personas que trabajan en ella y cómo usar la tecnología, ser un habilitador que les permita aprovechar al máximo sus capacidades para generar conocimiento y tomar mejores decisiones”, señaló.
Los Desayunos del Club CIO, tienen por objetivo dar a conocer el uso de la tecnología de la información en las empresas como una herramienta de generación de valor y a ellos asisten los gerentes de informática de las principales empresas del país.
MLP
SQM Implementa Prometedor Plan Productivo en Quillagua
Last changed: may 02, 2012 19:08 by Editor Portal Minero Labels: sqm, quillagua, rse
La Iniciativa que está desarrollando la Compañía en la localidad, ya comenzó a dar los primeros resultados.

23 de Abril de 2012.- En el marco del Programa de Fomento Productivo que SQM desarrolla hace un año en la localidad de Quillagua -ubicada en la comuna de María Elena-, los pobladores ya están cosechando los primeros frutos, en términos agrícolas.
Para Víctor Palape, dirigente de la comunidad “el trabajo que ha realizado SQM ha sido muy bueno, se han concretado iniciativas que están ayudando a la comunidad a desarrollar distintas actividades agrícolas y capacitaciones; junto con la entrega de maquinaria para trabajar la tierra, se está avanzando en los sistemas de riego y construcción de un gran invernadero para el cultivo de lechugas hidropónicas”.
El Programa de Fomento Productivo para Quillagua ha logrado importantes avances en las distintas áreas, como en el sistema de conducción de agua, donde se han instalado 3.916 metros de tubería. Además, se encuentra en ejecución la instalación de fittings para la distribución de agua y construcción de una cámara de captación. Este trabajo permitirá realizar un diseño de riegos tecnificados, utilizando energías renovables. A esto se suma, la compra de maquinaria agrícola, lo que a la fecha se ha traducido en la adquisición de un tractor, una retroexcavadora, rotovator nardi, entre otros.
A su vez, el Proyecto de Alfalfa, contempla el ensayo de variedades comerciales y ecotipos locales y la habilitación y limpieza de terrenos, muestreo de suelo y agua, para definir el mejor plan de trabajo.
Para Pablo Pisani, Gerente de Medio Ambiente y Comunidad de SQM, “hemos encontrado en Quillagua una comunidad con muchas ganas de aprender y mejorar su calidad de vida, y como empresa hemos podido desarrollar un proyecto-abierto para toda la comunidad- ; tras un año de funcionamiento, los resultados son muy satisfactorios y nos obligan a seguir trabajando” señaló el ejecutivo.
Una de las iniciativas más interesantes, es el Proyecto de Hidroponía, que busca entregar una innovadora herramienta para la producción y comercialización de lechugas, éste considera capacitación, la construcción de un invernadero de 720 m2, con sistema de producción Hidropónica NFT (Nutrien Film Technique), método económico muy utilizado.
Cabe mencionar, que también se incorporó dentro del proyecto el área de turismo, de este modo, durante el año 2011 se certificaron 15 vecinos como guías turísticos. Además, se realizaron mejoras como el diseño e instalación de señaléticas.
Para el año 2012 se contempla el mejoramiento de las dos oficinas turísticas, junto con la capacitación en ecoturismo y arreglos en el salón museográfico de la comunidad.
SQM
Crystal Lagoons y Comisión Nacional de Riego evalúan impulsar innovador proyecto para enfrentar escasez de agua en Chile
Last changed: may 02, 2012 19:08 by Editor Portal Minero Labels: crystal, lagoons, cnr, agua, hídrico, lagunas
Gobierno busca innovadoras alternativas de tecnología para almacenar grandes cantidades de agua dulce de alta calidad en napas subterráneas de manera eficiente y económica.

23 de Abril de 2012.- La Comisión Nacional de Riego (CNR) y Crystal Lagoons están impulsando una innovadora solución para el aprovechamiento de aguas lluvias, respondiendo a la preocupación del Gobierno frente a la disponibilidad del recurso hídrico –problema neurálgico en el desarrollo futuro del país- y a la actual escasez del vital elemento en las zonas centro y norte del país.
Se trata de una nueva aplicación industrial del concepto y tecnología Crystal Lagoons, desarrollada por el reconocido innovador chileno, Fernando Fischmann, que permite capturar, tratar y purificar aguas lluvias por medio de lagunas cristalinas y luego infitltrar las agua de alta calidad a los acuíferos subterráneos,que experimentan déficit de volumen por falta de precipitaciones o altas tasas de extracción.Posteriormente el agua almacenada es bombeada a la superficie para su uso industrial en agricultura, minería y sanitarias, posibilitándose una constante reposición del recurso hídrico.
“El enorme interés de la CNR por la tecnología Crystal Lagoons se explica por la urgente necesidad de implementar fuentes de agua renovables en el país. Los escenarios de sequía son cíclicos y los embalses sólo capturan el 4,2% de las aguas superficiales, mientras que el resto del recurso hídrico se pierde en el mar”, explica el gerente de Desarrollo de Crystal Lagoons, Joaquín Konow.
El objetivo es aprovechar los proyectos en las cuatro zonas donde se analiza infiltrar aguas. Para partir con el proyecto piloto, se eligió la cuenca de La Ligua-Petorca, una de las más golpeadas por la sequía y que fue declarada como zona de emergencia.
En países desarrollados se están aplicando sistemas de infiltración de napas subterráneas, que sin embargo tienen limitaciones técnicas y costos muy altos, lo que ha impedido su masificación. Con la tecnología chilena se hace posible que el vital elemento se purifique con costos muy inferiores, a los logrados en esas experiencias, infiltrando agua de alta calidad a los acuíferos.
Según el Secretario Ejecutivo de la CNR, Felipe Martin, la iniciativa surge de la necesidad de tener agua de buena calidad, según lo que dicta la norma que permite los permisos para la recarga de acuíferos. “Si almacenas aguas contaminadas subterráneamente se puede echar a perder un acuífero de por vida. Por eso recurrimos a quienes tienen la tecnología probada en esto para así apurar los permisos”, explicó Martin.
La tecnología sería probada en una planta piloto de infiltración de aguas que el Gobierno está evaluando construir próximamente en la zona de Ligua- Petorca, región de Valparaíso.
Crystal Lagoons
Edifica – ExpoHormigón ICH 2013 crea lazos con industria peruana
Last changed: may 02, 2012 19:08 by Editor Portal Minero Labels: edifica, expohormigon, perú, cchc
El comité organizador de la feria de la construcción más importante de Chile y Latinoamérica, viajó a Perú para establecer alianzas y definir su participación en la muestra nacional.

23 de Abril de 2012.- Gran interés por participar en Edifica – ExpoHormigón 2013 mostraron representantes del sector de la construcción de Perú.En esta versión, la feria se convertirá en la exhibición internacional más grande e importante de Latinoamérica de la industria.
El comité organizador de la muestra, compuesto por representantes de la Cámara Chilena de la Construcción y Fisa, viajó a este país para sostener reuniones con diversas organizaciones relacionadas al sector, entre ellas, la Cámara Peruana de la Construcción, PromPerú, la Cámara de Comercio Peruano-Chilena y la representación de ProChile en Lima.
El principal objetivo de realizar este viaje y mantener reuniones con importantes organizaciones del sector de Perú fue invitar a la Cámara Peruana de la Construcción a participar en la feria, con 100 m2 de exhibición de productos, servicios y técnicas de construcción que sean de interés para el mercado chileno. “En reunión con PromPerú, entidad de gobierno que promueve las exportaciones peruanas, y la Cámara Peruano Chilena de Comercio, concluimos que será muy importante una delegación del Perú que participe en las Ruedas de Negocios y Charlas Técnicas que se realizarán en la muestra” destacó Carlos Erdmann, presidente del comité organizador de Edifica – ExpoHormigón ICH 2013.
Agregó que “hay mucha inversión cruzada y empresas chilenas están invirtiendo en Perú así como otros grupos peruanos lo hacen en Chile. Lo mejor de cada país lo encontramos en el otro país. El comercio y la inversión unen los pueblos con trabajo y bienestar”.
Los pares peruanos manifestaron su interés por ser parte activa de la feria, mostrando interés por enviar empresas peruanas a participar como expositores, también en traer misiones comerciales de compradores y en participar en las ruedas de negocios que se realizarán.
Edifica
Oficina Turner Arquitectos recibe Distinción Bercia 2011
Last changed: may 02, 2012 19:08 by Editor Portal Minero Labels: bercia, premio, arquitectos
Como ya es tradición desde 1995, Bercia otorgó nuevamente dicha distinción que reconoce la destacada labor profesional en un proyecto arquitectónico.

23 de Abril de 2012.- Desde el año 1952 que el Grupo Bercia, empresa con amplia trayectoria y expertise en sistemas y productos de arquitectua que contribuyen a la eficiencia energética y a la Certificación LEED®, ha acompañado a las principales oficinas de arquitectura, decoración, constructoras e inmobiliarias del país, en el desarrollo de sus proyectos.
En este largo camino es que en 1995, Bercia instituyó la entrega de la Distinción Bercia para reconocer la destacada labor de una oficina de arquitectura en Chile, entre los cuales Bercia ha participado con su amplia gama de soluciones, y que se ha transformado en una tradición.
Este año, el premio recayó en la oficina Turner Arquitectos por el proyecto Hotel Hyatt Place Vitacura; y en Energy Arq, asesores LEED® de dicho proyecto, por incorporar conceptos de sustentabilidad que contribuirán a la eficiencia energética a través de la innovación tecnológica tanto de los materiales como del diseño.
La distinción fue entregada por Abishai Rovner, Gerente General de Bercia y recibida por Josefina Vergara y Rodrigo Morales, Socios de Turner Arquitectos; y por Rolf Sielfeld, Socio de Energy Arq.
Cabe señalar que el nuevo Hotel Hyatt Place Vitacura es uno de los nuevos proyectos de crecimiento que está desarrollando Grand Hyatt Santiago, estará orientado a ejecutivos, contará con 180 habitaciones y abrirá sus puertas a fines de 2012.
Grupo Bercia
Transportes Bolívar adhiere a Red Pacto Global Chile
Last changed: may 02, 2012 19:08 by Editor Portal Minero

23 de Abril de 2012.- Con la presencia de la Directora Ejecutiva de Pacto Global Chile, Margarita Ducci, y del Gerente General de Transportes Bolívar, Nelson Figueroa, se llevó a cabo la firma de adhesión a este protocolo de Naciones Unidas, por parte de la empresa chilena de transporte de carga por carretera.
La ceremonia de ratificación de dicho protocolo contó también con la presencia de Jenny Chicurel, Coordinadora del Area de Socios de Pacto Global. Por Transportes Bolívar, participaron además Rodrigo Figueroa, Gerente de Administración y Finanzas; Francisca Avendaño, Encargada de Gestión de Personas y Jennifer Pérez, Encargada de Medio Ambiente y Prevención de Riesgos.
La Directora Ejecutiva de Pacto Global, Margarita Ducci, destacó que esta iniciativa de Naciones Unidas lanzada en el Foro de Davos, tiene como propósito promover en todos los ámbitos el respeto de los derechos humanos y las normas laborales, el cuidado del medio ambiente y la lucha contra la corrupción. A dicho acuerdo global se han sumado empresas globales y locales, así como sindicatos e instituciones no gubernamentales.
Destacó que la red chilena de Pacto Global cuenta actualmente con 72 empresas e instituciones adherentes, comprometidas a desarrollar estos diez principios dentro de su área de influencia y a reportar anualmente sus progresos en distintos campos como la abolición del trabajo infantil, la discriminación laboral y la adopción de tecnologías amigables con el medio ambiente.
Por su parte, el gerente general de Transportes Bolívar, destacó que la empresa está comprometida con el bienestar de sus trabajadores, la seguridad de las personas y el cuidado del planeta. “Somos la primera empresa en la industria que mide su huella de carbono y compensa todas sus emisiones, por lo que somos una empresa carbono neutral”, enfatizó. Asimismo, explicó que llevan a cabo un manejo integral de sus residuos para su correcto acopio, tratamiento y reciclaje, reduciendo así los impactos sobre el entorno.
El ejecutivo señaló que Transportes Bolívar impulsa una política de seguridad y bienestar de sus trabajadores que pone el énfasis en el auto cuidado, el respeto absoluto de las normas laborales, la capacitación permanente y el uso de tecnologías que contribuyen a una mayor seguridad.
Puntualizó que la empresa seguirá impulsando acciones en su cadena de valor para promover el adecuado respeto y protección de las personas y el medio ambiente, “porque creemos en la eficacia del compromiso local para obtener un resultado global”, concluyó.
Desarrollo sostenible
Bolívar es una empresa de transporte por carretera que ofrece servicios de carga nacional e internacional, carga sobredimensionada y de sobrepeso, almacenamiento, logística y distribución a empresas mineras, de ingeniería, grandes proveedores para la minería ycompañías embarcadoras, entre otras. Opera actualmente en grandes proyectos como Organic Grow Proyect 1, de Minera Escondida, y Caserones, de Lumina Mining, entre otros.
Es la primera empresa del rubro en Chile y América Latina que ha medido y neutralizado todas sus emisiones de gases de efecto invernadero, siendo una empresa ciento por ciento amigable con el medio ambiente.
A nivel mundial, Transportes Bolívar forma parte del exclusivo club de medio millar de empresas que han obtenido la distinción carbono neutral, entre ellas UPS, SAS Airlines y Tata.
En nuestro país, la empresa opera bajo los estándares globales que fijan las normas ISO 9001 y 14001 en materia de calidad y medio ambiente, así como la norma OHSAS 18001, sobre seguridad y salud laboral.
Pacto Global Chile
Empresas Otero trae la primera mesa de corte láser fibra
Last changed: may 02, 2012 19:08 by Editor Portal Minero

23 de Abril de 2012.- Empresas Otero, grupo chileno con casi 50 años de experiencia en el mercado industrial, ha logrado consolidar una posición de liderazgo como una de las principales abastecedoras de aceros especiales e insumos industriales del país a través de sus empresas: Aceros Otero, Serviper y Hey! Arriendos.
La compañía busca ser la opción más confiable para los negocios de las empresas industriales, porque cuenta con productos e insumos de primer nivel, una logística de excelencia, y con un personal calificado en cada una de sus empresas con alto nivel de preparación y expertise, que conoce las necesidades de cada una de las áreas que atiende.
Mesa de corte láserfibra
Una de las novedades que Empresas Otero incorpora a su línea de procesoes la nueva mesa de corte láser, máquina de fibra óptica fabricada con tecnología chino-italiana que permite una rapidez de corte cinco veces mayor que la que realiza un corte con sistema plasma.
El láser fibra permite cortar todo tipo de aceros al carbono, inoxidables, dúplex, titanio, aceros antiabrasivos, además de aluminio, cobre, bronce y plásticos industriales, materiales que no se pueden mecanizar con un laser de CO2.
Empresas Otero es la primera empresa en Chile que cuenta con esta mesa de corte láser fibra, que estará operativa en Centro de Distribución San Ignacio (Quilicura) a partir de mayo de 2012
Empresas Otero
Planta minera móvil en el sur busca recuperar histórica tradición de los mineros del oro
Comercialización del mineral se realiza en algunas joyerías de Valdivia, a donde viajan cada mes los mineros para vender la producción.

23 de Abril de 2012.- El ministro de Minería, Hernán de Solminihac, junto al intendente de la Región de Los Ríos, Juan Andrés Varas, al edil de la comuna de Mariquina, Guillermo Mitre, y a la seremi de la cartera, Marcela Kehr, entregaron esta mañana la primera planta minera móvil que busca recuperar la histórica tradición de los mineros artesanales del oro en la región.
La iniciativa favorece a 41 mineros artesanales asociados en el Sindicato de Pirquineros Independientes de la Colonia de Paillaco, quienes se adjudicaron el proyecto que significó una inversión de unos $58 millones.
“Potenciar la actividad aurífera y minera en la Región de Los Ríos, es uno de los compromisos del gobierno del Presidente Sebastián Piñera, y que el Ministerio de Minería ha decidido apoyar a través de las herramientas y recursos que tiene disponible”, indicó Solminihac.
El secretario de Estado precisó que la construcción de la planta móvil, es un paso importante para el sector minero artesanal, dado que permitirá generar mayores y mejores emprendimientos.
El intendente Juan Andrés Varas, en tanto, destacó que “Los Ríos es una región emergente desde el punto de vista de la actividad minera, y con una historia que debemos volver a recuperar. Con esto ayudamos al trabajo por lograr la tan ansiada equidad territorial y entregamos nuevas oportunidades laborales".
En paralelo, Solminihac señaló que la cartera trabaja para que los mineros del oro y carbón de Los Ríos se conviertan oficialmente en propietarios, y mantengan la extracción de minerales como una forma de vida segura.
La autoridad agregó que la secretaría regional de la cartera trabaja para regularizar la actividad. Para ello, dijo, la seremi ha preparado visitas de Sernageomin para que expertos visiten a los mineros artesanales de la región. Asimismo, el ministerio ha postulado a fondos de desarrollo regional con el propósito de transferir tecnología a los mineros artesanales, junto a la contratación de profesionales para que puedan asesorarlos en forma técnica y jurídica.
Ministerio de Minería
2012/04/20
Lureye Electromecánica y sus desafíos para el 2012

20 de Abril de 2012.- Luego de un 2011 de grandes logros, Lureye Electromecánica sigue profundizando su presencia en el mercado nacional a través de la comercialización de soluciones electromecánicas, las cuales incluyen un variado mix de productos, donde podemos encontrar motores eléctricos IEC y NEMA, sistemas de automatización, reductores de velocidad y equipos de levante.
Lureye en sus casi 70 años de historia ha estado presente a lo largo de todo Chile en los diversos requerimientos delos sectores productivos de la economía, lo que se ha podido desarrollar gracias a la existencia de sus sucursales en Antofagasta, La Serena (HO), V región (HO), Santiago, VII Región (HO), Concepción y Puerto Montt.
Lureye Electromecánica, como novedad para este año, incorporará 2 nuevas marcas en su portafolio de productos, enriqueciendo su oferta de la mano de los variadores de frecuencia Delta (que se caracterizan por su gran versatilidad, amplitud de prestaciones y su amigable tecnología) y de los motoreseléctricos KEB, los cuales se unen a lasya reconocidas marcas Siemens y US Motors, que la empresa distribuye. Por último, la empresa informó que para este 2012 seplanea profundizar los conceptos por los que los clientes han preferido la marca Lureye, los cuales se basan en la reconocida calidad de sus productos, la presencia en terreno, su experiencia en el mercado y la confianza que seofrece.
Lureye
Codelco Salvador Renueva Carros de Transporte

20 de Abril de 2012.- Con el objetivo de realizar mejoras que permitan cumplir los compromisos de producción, la Gerencia Minas Plantas adquirió diez nuevos carros metaleros, con los que se renovó parte de la flota existente en el Ferrocarril Portal y donde el aporte de los profesionales de las Superintendencias Minas y Mantenimiento fue esencial a la hora de materializar el proyecto.
“Teníamos una flota muy limitada, que hoy se ve reforzada con estos diez carros nuevos. Esto por un lado, nos da mayor disponibilidad de equipos y por otro, nos permite hacer los mantenimientos sin afectar la productividad” señaló, quién era el jefe de la Unidad de Transporte y Chancado, Carlos Orellana y que ahora desempeña otras funciones en la gerencia.
En diciembre, la gerencia recibió el último de los diez carros incorporados a la flota, cuya estructura y fabricación es chilena y su sistema de rodado brasileño. Su capacidad es para 40 toneladas, cumpliendo con todas las exigencias establecidas en los Estándares de Control de Fatalidades, que permiten una operación más segura.
Codelco Salvador
Tripp Lite presentó su oferta de Soluciones Integradas en ExpoMin

20 de Abril de 2012.- Cerca de 70 mil personas visitaron la reciente versión de Expomin 2012, del 9 a 13 de abril recién pasados, oportunidad en la que Tripp Lite -fabricante líder de soluciones para la protección de energía y conectividad- mostró con éxito su completa oferta de Soluciones Integradas al mundo de la minería.
Durante esta feria, la más importante del rubro minero de América Latina, ejecutivos, ingenieros y técnicos de la gran y pequeña minería conocieron las ventajas de la oferta de Tripp Lite, que permite a las empresas, independiente de su tamaño, diseñar una solución ajustada a su medida y necesidad, con el respaldo de un líder en protección energética.
Las Soluciones Integradas de Tripp Lite ayudan a los clientes a desarrollar el sistema de protección y administración de energía que más se adapte a cada compañía, y considera todos los componentes que garantizan la eficiencia y continuidad de los sistemas de información en una empresa., entre ellos, equipos UPS, soluciones de racks y enfriamiento, productos de cableado y conectividad, herramientas para el manejo y control en redes, así como asesoría y soporte durante todo el proceso pre y post implementación.
Tripp-Line
Codelco Salvador Entrega Equipos de Emergencia a Brigadistas
Last changed: may 02, 2012 19:08 by Editor Portal Minero Labels: codelco, emergencia, salvador

20 de Abril de 2012.- Vehículos 4x4, que cuentan con sistema de iluminación y equipados con todo el material necesario para atender todo tipo de emergencias -sean éstas de rescate vehicular, trabajo en altura y espacios confinados- son algunas de las características de las nuevas camionetas que fueron entregadas a las Brigadas de Emergencia de División Salvador.
El gerente general, Jaime Rojas, quien encabezó la ceremonia de entrega de las camionetas, señaló que “contar con equipos de este estándar es lo que realmente necesitaba nuestra División. Esperamos no tener que utilizar nunca estas camionetas, pero si eventualmente lo requerimos, esto sin duda nos permitirá enfrentar de mejor manera una emergencia, puesto que se suma a la constante capacitación que reciben nuestros brigadistas”.
Cesar Mingorance, de la empresa PESCO, aclaró que “este es un proyecto en el que más hemos trabajado los detalles, porque a diferencia de lo que sucede en otros lugares, si llegase a ocurrir una emergencia en la División son los brigadistas quienes deben prestar el primer auxilio. Entonces estos equipos se diseñaron y equiparon para que sean capaces de atender y solucionar cualquier tipo de emergencia en sus áreas de trabajo”.
Codelco-Salvador
Novedoso congreso de eficiencia energética en la construcción se realizará en Antofagasta
Last changed: may 02, 2012 19:08 by Editor Portal Minero

20 de Abril de 2012.- Las inversiones en nuestro país siguen aumentando día a día en todas las grandes industrias, concretándose una serie de nuevos proyectos que implican la construcción de modernas instalaciones, tanto industriales como de servicios anexos que permitan su funcionamiento.
Hoy en día la industria de la construcción es cada vez más exigente con sus instalaciones y faenas, lo que obliga a que las construcciones sean más eficientes, sobre todo considerando el déficit energético que presenta nuestro país, lo que hace necesaria la búsqueda de soluciones eficientes.
La Multinacional Metecno, presenta la Conferencia Técnica “Eficiencia energética de la construcción” a cargo de Néstor Silva, Gerente Técnico de la compañía, en la que se reunirán expertos en el rubro. Se tratarán temas como la importancia de los materiales utilizados, tanto en muros como en pisos, soluciones constructivas para aislación térmica y acústica, además de características de resistencia al fuego.
La empresa cuenta con más de 50 años de experiencia en los 5 continentes y sus paneles son utilizados en proyectos mineros, energéticos, comerciales, industriales y residenciales. La conferencia se realizará este jueves 3 de mayo, de 18:.30 a 20:30 hrs., en el Hotel Enjoy de Antofagasta.
Portal Minero
Ministro Bunster conoció innovadores proyectos de Energías Renovables No Convencionales
Last changed: may 02, 2012 19:08 by Editor Portal Minero Labels: energía, ernc, geotermia, cauquenes
En visita a la Región de la Araucanía, y a más de 2.000 metros de altura, el Ministro de Energía recorrió la que podría ser la primera central en el país en ocupar el recurso geotérmico para generación eléctrica.

20 de Abril de 2012.- Esta mañana, y en compañía de las principales autoridades regionales, el Ministro de Energía, Jorge Bunster, visitó las instalaciones de la Central Geotérmica Curacautín, de la empresa GeoGlobal Chile.
El proyecto, ubicado en las laderas del volcán Tolhuaca, contempla una inversión de US$ 330 millones y proyecta 70 MW de potencia instalada para abastecer de energía al Sistema Interconectado Central (SIC).
"Conocer proyectos como éstos, e impulsar este tipo de energía es fundamental, más aún cuando nuestros lineamientos de política energética apuntan hacia una matriz cada vez más diversificada, y menos dependiente", afirmó el Ministro Bunster.
"La geotermia presenta algunas ventajas comparativas frente a otros tipos de energía, como su capacidad de operar en forma continua, con un factor de planta cercano al 95%", agregó el jefe de cartera, insistiendo además, en el potencial que tiene nuestro país para este tipo de generación eléctrica.
La Central Geotérmica Curacautín es el único proyecto geotérmico en etapa de desarrollo activo en Chile. Corresponde a una concesión de 7.800 hectáreas y se encuentra en proceso de pruebas. Actualmente, está en etapa de evaluación ambiental y se estima que sus operaciones comiencen a fines de 2015.
INFORMACIÓN RELACIONADA:
Ministerio de Energía finaliza con éxito licitación de 20 áreas de exploración geotérmica
La inversión de las 13 empresas para realizar estudios que conduzcan al hallazgo del potencial de los reservorios, asciende a US$ 250 millones y cubre una superficie de un millón de hectáreas.
http://www.minenergia.cl/ministerio/noticias/generales/ministerio-de-energia-finaliza-con.html
Ministerio de Energía
Anglo American inauguró moderna sala de computación en colegio de Lo Barnechea
Last changed: may 02, 2012 19:08 by Editor Portal Minero Labels: anglo, american, rse, sala, computación
La iniciativa liderada por la operación Los Bronces beneficiará a más de 700 alumnos del colegio San Esteban Mártir.

20 de Abril de 2012.- Anglo American inauguró oficialmente junto a representantes del colegio y autoridades, las instalaciones de la nueva sala de computación del colegio San Esteban Mártir de la comuna de Lo Barnechea. Hasta la fecha, el establecimiento no contaba con este tipo de equipamiento.
La iniciativa, coordinada en conjunto con la Fundación Educacional Alto Las Condes, tiene como objetivo entregar mayores herramientas y oportunidades de aprendizaje a los alumnos del establecimiento que contribuyan a disminuir la brecha digital, beneficiando a más de 700 alumnos.
“Para Anglo American poder colaborar con la comuna de Lo Barnechea a través de la construcción de esta sala de computación con tecnología de punta, es una gran satisfacción, ya que nos va a permitir seguir colaborando con la educación y entregar nuevas herramientas a cientos de niños del colegio San Esteban Mártir. Además, viene a ratificar nuestro compromiso por brindar nuevas oportunidades de desarrollo a las localidades en las cuales estamos insertos”, afirmó Samuel Rasmussen, gerente general de Los Bronces de Anglo American. La nueva sala de computación cuenta con tecnología de punta e incluye la instalación y puesta en marcha de una red LAN, habilitación de mobiliariode computación para 25 usuarios, alarma inalámbrica, sumado a la donación de 27 computadores, una impresora láser y un proyector.
Esta actividad se enmarca dentro de los diversos proyectos que la operación Los Bronces de Anglo American en el ámbito de la educación en las comunas de Lo Barnechea, Colina y Til-Til.
Anglo American Chile
Kinross Maricunga Entrega Indumentaria Deportiva a Escuela de Gimnasia Ritmica
Last changed: may 02, 2012 19:08 by Editor Portal Minero Labels: kinross, maricunga, rse, copiapó
La importante donación consistió en un juego de buzo para cada integrante de la escuela y fue entregada en el Estadio Orlando Guaita de la ciudad de Copiapó.

20 de Abril de 2012.- Como parte de su compromiso con la comunidad y enmarcado claramente en uno de sus cuatro valores, “Ser Un Ciudadano Corporativo Sobresalientes”, la Minera Kinross Maricunga entregó 19 tenidas de buzospara cada una de las integrantes de la escuela de Gimnasia Rítmica “GRD” , de la ciudad de Copiapó.
El importante apoyo fue entregado en el Estadio Orlando Guaita por el analista de Recursos Humanos de Kinross Maricunga, Roberto Villa. En la oportunidad el representante de la minerahizo mención al excelente trabajoque día a día realizan las alumnas de la escuela en torno a esta disciplina yaseguro que seguirá existiendo un constante apoyo por parte de la compañía.
En tanto la profesora a cargo del equipode gimnasia rítmica, Karina Pardo,agradeció el aporte de la minera canadiense y señaló que “es de vital importancia proporcionar este tipo de herramientas para el desarrollo profesional de las deportistas.Las niñas necesitan reconocimiento y estosignifica un gran estimulo para seguir participando en las distintas competencias”.
Cabe mencionar que en la actualidadla escuela de Gimnasia Rítmica “GRD” de Copiapó, está conformada por 19 niñas, provenientes en su mayoría de colegios municipales de la zona, que han sabido sobreponerse a grandes dificultades como por ejemplo no tener recursos para viajar atorneos nacionales.
Kinross Maricunga
Sansano construye el primer Péndulo de Foucault completamente chileno
Last changed: may 02, 2012 19:08 by Editor Portal Minero Labels: utfsm, pendulo, foucault
El Ingeniero Civil en Electrónica de la Universidad Técnica Federico Santa María, Gonzalo Arroyo, fue el encargado del diseño y la fabricación de un sistema de propulsión que pudiera mantenerlo oscilando indefinidamente.

20 de Abril de 2012.- Una esfera de acero cromada de 115 kilos, una longitud de 19,5 metros y un periodo de oscilación de 8,7 segundos son algunas de las características del primer Péndulo de Foucault construido íntegramente en Chile, específicamente en Puerto Montt, y unos de los pocos existentes en América del Sur; siendo encargado su diseño y la fabricación del sistema de propulsión que lo mantienen oscilando indefinidamente al Ingeniero Civil en Electrónica de la Universidad Técnica Federico Santa María, Gonzalo Arroyo.
La primera parte en desarrollarse fue el sistema de propulsión electrónico, explicó. “La idea es dar un pequeño impulso al Péndulo para que la oscilación se mantenga a una amplitud constante, a pesar del roce con el aire y de las piezas mecánicas que lo sostienen. Esta parte se desarrolló de forma metódica, logrando en menos de una semana un primer prototipo básico. Para lograr un funcionamiento óptimo se probó una serie de sensores y se diseñaron diferentes versiones de la bobina de actuación (electroimán), antes de lograr el producto final”, explicó.
Sin embargo, al probar el sistema de propulsión y aunque se realizaron diversos ajustes, el péndulo que hoy se encuentra en las nuevas dependencias del Colegio San Francisco Javier, en Puerto Montt, no funcionó del todo bien debido a que el sistema de suspensión no era lo suficientemente bueno y perturbaba la dirección de oscilación. “A raíz de eso, fue necesario rediseñar por completo todas las partes mecánicas, exceptuando la esfera de acero, e incluir nuevos elementos para que no fuera influenciado por la rotación de la Tierra. Esta nueva parte requirió nuevamente un proceso de investigación, diseño y fabricación de piezas”, detalló.
Investigación y pruebas
Lo más complejo de este proceso fue el gran trabajo que significó la cuidadosa fabricación de cada una de las partes mecánicas del sistema de propulsión. “El proceso de diseñarlas comenzaba con un bosquejo en un cuaderno, seguía en el Autocad, a veces lo conversaba con gente de la Universidad y luego buscaba alguna maestranza que estuviera dispuesta a fabricarla. No siempre las piezas quedaban bien, por lo que había que hacerlas nuevamente y las que se usan actualmente en el sistema de suspensión combinan una fabricación precisa con un diseño robusto a pequeñas imperfecciones”.
Otro tema crucial en el funcionamiento fue la correcta ubicación de las piezas. “Dada la lenta dinámica del péndulo, por cada pieza nueva que se probaba se requerían varios días entre ajustes y pruebas para evaluar el funcionamiento. El sistema de suspensión se encuentra a 20 metros del suelo, por lo que había que subir andamios o colgando de un tecle. Esto aumentaba la dificultad del proceso de ajustes, que es de por sí complejo”, agregó.
Cabe destacar que el Péndulo de Foucault construido por Gonzalo Arroyo se encuentra en las nuevas dependencias del Colegio San Francisco Javier en Puerto Montt y constituye uno de los objetos más importantes con los que cuenta el establecimiento. “Es un excelente recurso para comprender que la Tierra es un elemento dinámico en el universo, lo cual resulta increíble, porque bajo nuestros sentidos la Tierra nos parece algo estático”, sostuvo.
UTFSM
MET y municipio de Sierra Gorda firman convenios por la educación
Last changed: may 02, 2012 19:08 by Editor Portal Minero Labels: met, tesoro, sierra, gorda

20 de Abril de 2012.- Minera El Tesoro (MET) y la Ilustre Municipalidad de Sierra Gorda firmaron 2 acuerdos de colaboración orientados a fortalecer la educación y desarrollo de los niños y jóvenes de la localidad de Sierra Gorda, el pasado 18 de abril.
El primero de estos convenios, se refiere al apoyo en el traslado de alumnos de Enseñanza Media desde la comuna de Sierra Gorda hasta Calama, donde la mayoría de ellos cursa sus estudios secundarios. Este programa es coordinado íntegramente por la Municipalidad de Sierra Gorda y financiado en un 85% por MET, y permite que diariamente los jóvenes cuenten con un servicio de transporte que los traslada a Calama y luego retornen a sus hogares en forma segura, constituyéndose además en un ahorro importante dentro de los gastos básicos de cada familia.
La segunda de estas iniciativas, es el programa de apoyo de Lenguaje y Comunicación a través del Teatro, instancia en la que todos los estudiantes de educación básica desarrollan y refuerzan contenidos de esta materia en forma lúdica a través de las artes escénicas. Este programa, que se desarrolla en conjunto con la compañía Teatro de los Sueños, se ha transformado además en un espacio de desarrollo personal para los alumnos.
“Para nosotros el tema de la educación es un pilar estratégico para el desarrollo del capital humano. Es por ello que, por ejemplo, contribuimos a disminuir la tasa de deserción escolar en la comuna a través de entregar alternativas de transporte a Calama, y a la vez, mejorar la calidad de la Educación Básica, apoyando la labor de los docentes a través de innovadoras herramientas para los niños y jóvenes de la comuna”, afirmó Carlos Spano, Gerente de Recursos Humanos y Asuntos Externos de Minera el Tesoro.
Por su parte, el alcalde de Sierra Gorda, Jorge Guerrero, comentó que “gracias a estas gestiones, nuestros jóvenes cuentan con un vehículo moderno que cumple con los estándares de seguridad necesarios para brindar mejores oportunidades a nuestras familias, así como también la continuidad del taller de teatro ejecutado en la Escuela G-101 “Caracoles”, iniciado en 2006 y desarrollado con éxito por la compañía “Teatro de los Sueños”, beneficiando a un número importante de niños y niñas de este establecimiento”.
Al respecto, una de las apoderadas de uno de los alumnos beneficiados con el programa Lenguaje y Comunicación”, Luisa Sáez, afirmó que “todo lo material que mi hijo ha aprendido aquí ha sido bueno para él, porque se va a ir con una base de acá, para poder seguir en Calama o Antofagasta, donde él se vaya a estudiar”.
A juicio de Spano, esta iniciativa ha sido muy provechosa para los niños y jóvenes de Sierra Gorda, ya que les ha entregado técnicas para expresarse de mejor forma, desarrollar su personalidad, y a la vez fortalecer el interés y formación en el área del Lenguaje y la Comunicación, uno de los pilares fundamentales en el proceso de la Educación Básica. “A nosotros como compañía nos llena de satisfacción el hecho de poder estar colaborando en la educación y formación de los niños y niñas de Sierra Gorda, ya que son herramientas que no sólo les servirán durante su etapa escolar, sino para toda la vida”.
MET
2012/04/19
El Abra Entregó Veinte Becas de Estudio a Jóvenes Indígenas
Last changed: may 02, 2012 19:08 by Editor Portal Minero Labels: abra, freeport, mcmoran, educación, loa
*Iniciativa de Minera contó con el apoyo de Gobernación Provincial, Proloa y CONADI
*

19 de Abril de 2012.- Para pensar en un futuro mejor es fundamental potenciar la educación. Por esta razón,Minera El Abra, operada por Freeport McMoran, realizó una emotiva ceremonia, en la cual entregó veinte becas de estudios superiores paraalumnos destacados de las comunidades indígenaspertenecientes al Área de Desarrollo Indígena, Alto Loa y Asociaciones Indígenas de Calama, las cuales fueron asignadas mediante un trabajo asociativo con Proloa, la Gobernación Provincial y la Corporación Nacional de Desarrollo Indígena, CONADI.
Uno de los beneficiados es Juan Rojas, estudiante de Técnico en Odontología del Instituto AIEP, quien ha sido merecedor de esta beca por tercer año consecutivo. Al respecto, el alumno comentó que “al contar con esta ayuda de El Abra, me he sentido respaldado y he podido sacar mis estudios adelante, ya que me permitió dedicarme a la carrera sin tener la preocupación de trabajar para financiarla”.
Sobre esta iniciativa, el Gerente de Comunicaciones y Asuntos Públicos de El Abra, Yuri Rojo, señaló que “para nosotros es muy importante apoyar la formación de estos jóvenes, no sólo como profesionales sino como mejores personas. Por esta razón, nuevamente estamos entregando estas becas, las cuales han ido aumentando el número de beneficiados, hoy se entregan diez becas para educación universitaria y la misma cantidad, para educación técnico-profesional. Lo importante es que los estudiantes aprovechen esta oportunidad, para que en el futuro puedan ser un aporte para sus comunidades de origen”.
En tanto, el Gobernador Provincial, Luis Garrido, explicóque “tenemos a las comunidades indígenas con muchas necesidades y a través de este tipo de iniciativas podemos tener la opción de entregar un futuro mejor para los jóvenes. Esperamos que ellos puedan retornar para trabajar por esta tierra y por su gente, pues en ellos están puestas nuestras esperanzas”.
Respecto al proceso de entrega de las becas, el trabajo en conjunto permitió contar con una mesa técnica sólida para favorecer a quien más lo necesitaba. Sobre esto, la Gerente de Proloa, Alexandra Marín, manifestó que “es un orgullo para nosotros como institución poder apoyar esta iniciativa, pues es muy importante trabajar el tema de la educación, ya que es un aspecto trascendental para el desarrollo de la provincia”.
Este es el noveno año en que Minera El Abra realiza la asignación de estas becas, las cuales buscan incentivar a aquellos alumnos de origen indígena que destaquen en sus estudios y del mismo modo, aportar al desarrollo de nuevas oportunidades para los jóvenes del Alto El Loa.
SCM El Abra
Minera Gaby consolida la operación de la mayor flota de camiones autónomos del mundo
Last changed: may 02, 2012 19:08 by Editor Portal Minero Labels: gaby, camiones, autónomos, komatsu
Se desarrollaron mejoras al software que permite entregar mayor seguridad, mejorar el rendimiento y más flexibilidad.

19 de Abril de 2012.- Minera Gaby sigue marcando hitos en innovación tecnológica. Tras convertirse en 2008 la primera minera a nivel mundial en iniciar su operación con camiones autónomos, hoy consolida este lugar al aumentar su flota y transformarse en la mayor del globo.
6 nuevos camiones Komatsu 930E4, que operan con tecnología autónoma se incorporaron a los 11 ya existentes, totalizando 17 equipos que estaráncargo de realizar todas las labores de transporte de material desde el rajo.
Este aumento en la flota, se suma a las mejoras tecnológicas que se realizaron al software y que permitirán una mejor performance, rendimiento y seguridad. Dentro de las características de esta nueva versión se destaca que permite a los camiones alcanzar mejores estándares de velocidad, el sistema se robustece con más capas de seguridad y permite una gestión de la información más flexible.
Claudio Olguín, gerente general de Minera Gaby, destaca que esta innovación ubica a la minera a la vanguardia de la industria en materia tecnológica. “Somos pioneros y eso nos llena de orgullo. Fuimos los primeros en el mundo en apostar tan fuertemente por la automatización y hemos demostrado que fue una opción exitosa”.
Adicionalmente, comenta que la decisión de utilizar camiones autónomos trae consigo una serie de otros beneficios asociados que van más allá de la producción. “Estamos innovando no solo en tecnología, sino también en seguridad para nuestros trabajadores, en disminución de costos y con una mirada a futuro centrada en la sustentabilidad”, concluye.
Hay que considerar que todos los equipos presentes en las labores de mina cuentan con el sistema instalado lo que les permite conversar con los camiones Komatsu 930E4. Es así, como pueden existir 30 equipos trabajando en forma simultánea en el rajo e interactuando con total seguridad con los autónomos.
Historia
La tecnología de Camiones Autónomos es un sistema informático y satelital desarrollado por Komatsu que se adapta a un vehículo minero y que utiliza una señal GPS (Global Positioning System), junto a otras señales de apoyo en tierra, como sistemas de posicionamiento y navegación, que le permite desplazarse y transportar cargas de manera independiente, es decir, sin la necesidad de operadores o de un tele comando remoto.
El camión autónomo está diseñado para operar 24 horas continuas, navegar por rutas predefinidas y a una velocidad predeterminada, esperar y posicionarse en áreas de carguío, además de reportar estados de ubicación, entre otras cualidades.
Todas estas características le otorgan al sistema autónomo mayor seguridad y continuidad operativa inigualable que redunda, finalmente, en la reducción de costos de mantención y operación.
Las primeras pruebas de esta tecnología se realizaron en Japón en 1990 para en 1996 integrar el sistema GPS como parte fundamental de la operación. En 2006 llegana Chile utilizando la División de Codelco Radomiro Tomic como campo de pruebas y ante los óptimos resultados, en 2007 se instalan en Minera Gaby que se transformó en la primera minera a nivel mundial en iniciar sus operaciones con este tipo de tecnología.
Actualmente, y tras la exitosa experiencia en Gaby, otra importante compañía minera trabaja con camiones autónomos de Komatsu en Australia.
Camión Komatsu 930E4
Este equipo es el último modelo de los camiones eléctricos AC de la serie 930 en producción. Tiene una capacidad de 290 toneladas métricas, con una potencia de 2.700 HP.
El camión es el único en el mercado que permite la operación autónoma y, además, puede operarse en sistema manual. Su motor, sistema hidráulico y sistema eléctrico permiten un bajo consumo de combustible y su motor ECOT3 fue diseñados específicamente para satisfacer las nuevas regulaciones Stage IIIA de la Unión Europea (correspondiente a la Tier III en los Estados Unidos) aportando menos emisiones de NOx.
Gaby
Agricultores y Minera Los Pelambres trabajan por mejorar la producción del Choapa
Last changed: may 02, 2012 19:08 by Editor Portal Minero Labels: mlp, choapa, fitosanitario
En el trabajo que desarrolla la Mesa Productiva, ambas entidades acordaron una serie de acciones fitosanitarias para mejorar la productividad de la uva pisquera y nogales, entre otras plantaciones.

19 de Abril de 2012.- La temida arañita roja, pequeño ácaro que no supera los 0,5 mm, ha mantenido por meses preocupados a los agricultores del valle alto de Salamanca, en la provincia de Choapa. Si bien, la producción de uva pisquera y de nueces mantuvo sus niveles, la aparición de esta arañita y el pulgón los puso en alerta.
Agrupados en la Mesa Productiva, instancia que une a agricultores y vecinos de la zona con Minera Los Pelambres, se acordó aplicar productos fitosanitarios en 170 predios catastrados en la localidad de Cuncumén.
“El control de la arañita partió con un monitoreo de la vid pisquera, damasco y nogal, que son las principales plantaciones del sector y arrojó como resultado un ataque significativo en el nogal y la vid pisquera. Por lo tanto, se realizó un programa de aplicación que partió esta semana, donde tenemos 5 equipos operando en terreno, comenzando por los sectores más críticos y luego la zona centro”, explica julio Molina, gerente de la Cooperativa de Desarrollo Sustentable (CDS).
Alejandro Escudero, subgerente de Asuntos Públicos de Minera Los Pelambres, añade que el apoyo viene desde el 2010, con un programa fitosanitario que busca nivelar las capacidades productivas de la zona, controlando las plagas. “Existen experiencias muy interesante que hemos implementado a través de un equipo técnico, en el marco dela mesa productiva y que ha permitido que este año, 170 productores se hallan incorporado a este trabajo entre parceleros y sitiantes, lo que permitirá enfrentar estos desafíos productivos, que sabemos que en la zona de Cuncumén, son muy requeridos”, agrega el ejecutivo.
Para el proceso fitosanitario se están utilizando los mejores productos en el mercado y realizando constantes monitoreos de los predios tratados, asegurando el real efecto del control fitosanitario, según comenta Gelasio Vera, ingeniero agrícola y Jefe de Terreno del proceso. “La irinosis se está tratando con fertilización, la arañita se trata con abamectín y el pulgón del nogal se está controlando con Imidacloprida. De aquí a 4 días se notará el efecto sobre la arañita y pulgón y el realizar una nueva aplicación dependerá de la población de ácaros el huerto”.
Rodrigo Rojas, productor de nogales y vid pisquera en la localidad de Cuncumén, indica que “nunca había sido beneficiado y siempre estamos un poco a trasmano acá en la El Manzano y para recibir beneficios tuvimos que acercarnos para saber de qué se trataba”.
MLP
AIA impulsa alianzas comerciales entre empresas proveedoras chilenas y australianas
Last changed: may 02, 2012 19:08 by Editor Portal Minero Labels: aia, encuentro, negocios, antofagasta
60 proveedores locales sostuvieron rondas de negocios con empresarios oceánicos

19 de Abril de 2012.- Con interesantes opciones de alianzas comerciales entre empresas chilenas y australianas, se realizó el encuentro de negocios “Proveedores de la Minería: Australia-Antofagasta 2012”, evento organizado por la Asociación de Industriales de Antofagasta (AIA) y la Embajada de Australia en Chile a través de la Australian Trade Commission (Austrade).
En la ocasión, se congregaron ejecutivos pertenecientes a las mineras chilenas Codelco Chuquicamata, Minera Escondida, Xstrata Copper Lomas Bayas, Minera El Tesoro, Codelco Radomiro Tomic, Minera Gaby y BHP Pampa Norte, quienes sostuvieron diversas rondas de negocios con representantes de 20 empresas australianas.
“Este evento busca propiciar el espacio y la sinergia entre empresas, elemento y base fundamental de nuestra labor como gremio, siendo nuestro norte, el precisamente poder vincular empresas regionales con otras empresas del mundo, entendiendo que el negocio minero es globalizado y por lo tanto, generareste tipo de alianzas cobra cada vez más importancia”, explicó el Gerente General de la AIA, Fernando Cortez.
En tanto, el Gerente de Austrade, Ian Frederick, dijo que actividad “posibilita la concreción de negocios y afianza lazos estratégicos comerciales, con el diálogo directo de los empresarios con ejecutivos de las áreas de operaciones y abastecimiento de las compañías mineras de esta región, donde están emplazadas los principales yacimiento de cobre del mundo, razón por la cual es clave para nosotros estar acá presentes”.
Junto con la posibilidad de que estas compañías oceánicas, en su gran mayoría prestadoras de servicios y proveedoras para la minería, puedan concretar negocios con las mineras chilenas, el Gerente de Austrade Santiago destacó que esta posibilidad existe “ya que cada vez más empresas australianas invierten en Chile”, agregando además que incluso es posible que estas establezcan alianzas con alguna empresa proveedora local, “existiendo dentro del modelo de negocios de ellas o bien instalarse desde cero o venir a buscar el socio con el cual aliarte, siendo esto algo natural entre ellos, esperando que esto se logre sin duda tras esta reunión”, sostuvo.
FOMENTANDO ALIANZAS
Para propiciar esta alianza comercial entre empresas australianas y proveedores mineros e industriales de la región de Antofagasta, es que además concurrieron al evento un total de 92 ejecutivos pertenecientes a 60 empresas locales, las cuales no solo interactuaron con los representantes oceánicos, sino que aprovecharon la ocasión también de dialogar con los ejecutivos mineros.
Para el Jefe del Centro de Desarrollo Empresarial de la AIA, Ricardo Muñoz, lo importante de este evento, “es poder contribuir a la generación de estas alianzas ya sea a través de joint venture o representaciones comerciales australianas en Chile con estas empresas regionales, todo en concordancia con las necesidades y requerimientos del sector minero”.
En esta reunión, realizada en el Hotel Terrado, participaron los encargados de las compañías australianas Oniqua, Tall Bennet, RME Global, Runge, ACIM, EMECO, Mining Plus, Red Appointments, Micromine, WORLDPOLY, SEDGMAN, BRANACH, IMMERSIVE, Fluid Power, MINEWARE y GMC, entre otras. Además, de 16 ejecutivos de siete empresas mineras, además de 92 representantes de 60 empresas proveedores industriales y mineras de la Región de Antofagasta.
AIA
Minera Spence incorpora avanzada tecnología de TTM y MMI en sus procesos en faena

19 de Abril de 2012.- TTM, empresa líder en innovación y dedicada a proveer soluciones tecnológicas y soporte a la gestión minera en el ámbito de los sistemas de transporte de mineral, instaló en Minera Spence la solución ToothMetrics™ y ViewMetrics™ de Motion Metrics International (MMI), aplicación desarrollada para el monitoreo y detección preventiva de pérdida de dientes de las grandes palas excavadoras, asegurando así los más altos estándares de calidad, eficiencia y disponibilidad en las faenas.
Estas soluciones especialmente diseñadas para el monitoreo de equipos en faena minera han sido instaladas en una pala P&H 4100 XPC, recientemente puesta en servicio en Minera Spence. Esto responde a la necesidad de controlar el desprendimiento imprevisto de los dientes de los baldes de pala, los que sufren una alta abrasión y desgaste y que pueden provocar daños en los equipos de chancado, detenciones no programadas y las respectivas pérdidas económicas.
La tecnología de ToothMetrics™ se basa en el procesamiento de imágenes en tiempo real, lo que permite entregar soluciones como detección de caída de dientes pala, análisis de fragmentación de rocas, prevención de colisiones, etc., información de suma importancia en la operación de maquinarias pesadas en faenas mineras.
En este sentido, Carlos Lopéz, Área Manager de Soluciones de Confiabilidad de TTM Chile, señaló que “para nosotros es un gran desafío este contrato, a través del cual proveímos e instalamos nuestras soluciones de confiabilidad y monitoreo preventivo de última generación en el corazón de la faena. Estamos seguros que seremos un real aporte al proceso productivo de Minera Spence, entregándoles todo nuestro apoyo y experiencia en soluciones a la medida”.
TTM
Lureye Electromecánica suministra motor de anillos rozantes

19 de Abril de 2012.- Como resultado de una excelente gestión de venta y un soporte en terreno de calidad,realizado desde fines del año 2010,Lureye Electromecánica se adjudicó el suministro de un motor Siemens de anillos rozantes de 1000KW de potencia, alimentado en 4KV (MT), esto debido a la necesidad del cliente de remplazar un motor crítico existente para su planta. El requerimiento implicó un alto grado de dificultad y conocimiento técnico, debido a la tecnología utilizada en este tipo de motores, demostrando nuevamente la confianza de la minera hacia la empresa.
Para Lureye Electromecánica resultó muy gratificante desarrollar este proyecto, dada sus complejidades técnicas y logística.Cabe destacar, que equipos de estas características no se suministra habitualmente a través del canal de distribución, por lo que el éxito de la venta tuvo directa relación con el trabajo en terreno que realizó el personal de Lureye, y la cercanía que mantiene con sus clientes, así como el soporte técnico y profesionalismo que lo caracteriza, recibiendo toda la confianza necesaria para una operación de esta envergadura. Sin duda que este caso de éxito sienta un precedente, debido a que deja en evidencia la experiencia y conocimientos necesarios para proveer equipos de estas características y cumplir con los requerimientos más exigentes del mercado nacional, lo que llena de satisfacción a la empresa.
Lureye
Ministerio de Energía lanzó campaña de eficiencia energética en Magallanes
La primera etapa de esta iniciativa, que cuenta con la colaboración de Methanex, tiene por objetivo cambiar 60 mil ampolletas tradicionales por luminarias de bajo consumo en los sectores residenciales de Punta Arenas.

19 de Abril de 2012.- "Magallanes inteligente, usa energía eficiente" es el nombre de la campaña de eficiencia energética y difusión de energías renovables que fue lanzada hoy en Punta Arenas por el Subsecretario de Energía, Sergio del Campo, y el Seremi de la cartera, Octavio Casas.
El proyecto consta de cuatro grandes acciones mediante las cuales se promoverá la sensibilización y el mejor uso de la energía entre niños, jóvenes y adultos, todo esto gracias a una alianza público-privada, cuyos integrantes se han comprometido a aportar en esta tarea que cada vez se hace más necesaria en toda la Región de Magallanes.
En la primera etapa de la campaña se entregarán gratuitamente ocho ampolletas de uso eficiente a 7.500 hogares de Punta Arenas, lo que suma una distribución total de 60 mil luminarias, las que fueron donadas por la empresa Methanex. En tanto, la logística de entrega de las mismas estará a cargo del Ejército de Chile.
Con esta iniciativa se fomentará el uso de equipos energéticamente eficientes a nivel residencial, y se añade un beneficio social debido a que el gasto económico se verá reducido en cada vivienda, lo que se podrá comprobar con el seguimiento que realizará Edelmag.
El subsecretario Del Campo, destacó que "la Eficiencia Energética es uno de los principales pilares de la Estrategia Nacional de Energía lanzada por el Presidente Sebastián Piñera. Iniciativas tan importantes como ésta nos ayudarán a alcanzar la meta que nos fijamos en este documento, que es reducir un 12% la demanda energética al 2020".
Por su parte, el intendente Arturo Storaker manifestó que "éste es un esfuerzo conjunto para concientizar lo importante que es el ahorro de energía, sobre todo en una región donde ésta es un sustento para sus habitantes".
Paul Schiodtz, gerente general de Methanex, señaló que "éste es el programa de Responsabilidad Social más grande asumido por Methanex en la región" y que en esta campaña de recambio de iluminación su aporte supera los 100 millones de pesos.
Concurso de Eficiencia y Energías Renovables
Paralelamente al cambio de las ampolletas en los hogares, durante las próximas semanas se presentará el Concurso de Eficiencia Energética y Energías Renovables en Magallanes, cuyo objetivo es difundir y educar a los niños y estudiantes sobre la materia.
En este contexto, se dará especial importancia a las distintas formas de energías renovables que posee la Región, donde se resaltará la creatividad del trabajo de los participantes. Para esto, se crearon cuatro categorías de competencia: enseñanza pre básica, básica, media y superior.
La tercera etapa de esta campaña se llevará a cabo durante el segundo semestre, realizando seminarios y conferencias con expositores regionales y nacionales, lo que permitirá intercambiar experiencias que apunten a nutrir el trabajo de diversificación de la matriz energética local.
La cuarta etapa comprende un reacondicionamiento térmico de viviendas de autoconstrucción, ya que actualmente existe la necesidad de efectuar mejoras en casas, que por su condición, no cumplen con los requisitos mínimos exigidos por el Estado para acceder a los subsidios existentes, pues además en su mayoría se trata de domicilios no regularizados.
Las empresas que han confirmado su participación en esta instancia, cooperando de diversas formas para llevar a cabo todas estas acciones, son Methanex, Edelmag, ENAP, Gasco, GeoPark, PetroMagallanes y Pan American Energy, quienes se adhirieron al trabajo del Gobierno Regional, que incluye el apoyo de la seremi de Desarrollo Social, Fosis y la Coordinación de Seguridad Pública, además del aporte logístico del Ejército de Chile.
Ministerio de Energía
Compañías mineras de Coquimbo valoran uso de energías limpias como complemento a su demanda
Cuarta Jornada de la Mesa de Sustentabilidad Minera, liderada por la SEREMÍA de Minería Coquimbo, y coordinada por la Corporación Regional de Desarrollo abordó el problema energético del sector minero regional.

19 de Abril de 2012.- En un contexto donde el suministro eléctrico se encarece, en que hay retrasos en la puesta en marcha de los proyectos energéticos y falta inversión en materia de transmisión, la Mesa de Sustentabilidad Minera de la Región de Coquimbo abordó los escenarios actuales y futuros de las Energías Renovables No Convencionales (ERNC), como aporte y alternativa a esta industria.
En esta jornada, la cuarta de este año, se contó con la presencia del Centro de Energías Renovables (CER) de CORFO, a través del analista Ricardo León, quien detalló que energías como la solar o la eólica son alternativas viables hoy en Chile, en particular porque se han abaratado en costos de inversión y operacionales y porque nuestro país cuenta radiación y condiciones de viento favorables en muchos puntos del país, además de una legislación que promueve su uso.
La SEREMI de Minería Jocelyn Lizana, agregó que para efectos de la minería regional se analizó los casos de los proyectos eólicos de Barrick en Punta Colorada y el contrato suscrito por Minera Los Pelambres con el Proyecto El Arrayán.
Ambas compañías establecieron modelos distintos para administrar estos proyectos, “Barrick lo hizo desde dentro de su compañía, generando una filial generadora de energía, y Pelambres desde fuera, haciendo un contrato de largo plazo con especialistas en el tema eólico a nivel mundial. Son soluciones inteligentes para aportar energías limpias al país, reducir sus huellas de carbono entre otros beneficios”, dijo la SEREMI.
Ricardo Funes, Gerente de Insumos Críticos de Minera Los Pelambres, destacó el modelo de contrato a largo plazo que permitió desarrollar el Parque Eólico El Arrayán. “Las compañías mineras podemos contribuir a que el Sistema Interconectado Central genere más energías verdes, y ayudar a lograr la meta de diversificar la matriz energética nacional en 2020”.
Por su parte, Luciano Larrondo, asesor eléctrico de Minera Teck Carmen de Andacollo, fue enfático al decir que Chile no debe recurrir siempre al diesel para solucionar sus problemas de estrechez energética, por ello el experto agrega que “lo que hay que hacer es incorporar todas las energías limpias que se puedan, dejando muy claro sí, que sólo son energías complementarias ydiscontinuas - sólo funcionan si hay viento o sol, etc. - y por tanto se necesita de los otros tipo de energía para lograr tener industrias continuas como la Minería, si no es imposible".
“Por lo general, cuando se publican cifras, se dan las potencias instaladas de las ERNC y no se cuentan las horas en que los equipos realmente pueden operar, que en general no supera el 25% del tiempo, este el llamado factor planta”, dijo Larrondo.
Igual opinión manifestó Ricardo Arias, gerente de Ingeniería de Sulfatos Chile. S.A, para quien no es factible quedarse con una sola fuente de energía limpia, “porque las ERNC son fuentes de energía volátiles, más que las fuentes de energía dura”. Pero Arias reconoce que desarrollar este tipo de proyectos permite a las mineras insertarse en la comunidad (…) Lograr incorporar tecnologías limpias y de punta a las localidades más aisladas, no solo es unbeneficio para la compañía, sino que es una inserción real de una comunidad en la actividad económica”, precisó.
Seremia Minería Coquimbo
Ministra Matthei coloca primera piedra de fábrica de contenedores que dará empleo a 1.800 personas en San Antonio
*Según estimaciones del Ministerio del Trabajo, de acuerdo a
información del INE, el efecto en empleo que produciría la planta equivale a una reducción de hasta cuatro puntos en el desempleo provincial, que es uno de los más altos del país.
*

19 de Abril de 2012.- La ministra del Trabajo y Previsión Social, Evelyn Matthei, informó que se está avanzando rápidamente en la puesta en marcha de la fábrica de contenedores de la empresa danesa Maersk y, auguró, que ésta tendrá un tremendo impacto para la provincia de San Antonio.
“Estoy muy contenta porque se va avanzando, ya se puso la primera piedra, a fines de este año comenzamos las capacitaciones. En este momento estamos levantando los perfiles,qué es lo que necesitan aprender, quiénes son las que van a enseñar, cómo le vamosenseñar a los profesores que van a impartir los cursos”, señaló la secretaria de Estado, tras participar en la ceremonia realizada hoy en la zona y donde se firmó un acta de protocolo entre las partes.
La fábrica de la empresa danesa Maersk supondrá una inversión cercana a los US$ 170 millones y comenzará a operar gradualmente a fines de 2013, dando empleo a 1.800 personas, preferentemente de la Provincia de San Antonio.
El Ministerio del Trabajo está apoyando la iniciativa,armando un plan en conjunto con la empresa para capacitar a trabajadores en los oficios de Soldadores y Pintores.
“Lo que queremos es hacer una capacitación de la mejor calidad para trabajar acá y que sea realmente gente que se luzca por la calidad de su trabajo. Esa capacitación la queremos hacer acá, en San Antonio, para la gente de la provincia y de la comuna” señaló la autoridad.
Asumiendo un 100% de las capacitaciones realizadas en oficios de soldadores y pintores, además de cursos de inducción de 6 días para operarios especialistas, los incentivos por parte del Ministerio del Trabajo en capacitación bordearían los US$ 3,5 millones.
Además es posible utilizar subsidios a la contratación, dentro de los cuales existen: Incentivos que aportan el 50% de un sueldo mínimo por los primero 6 meses de trabajo y subsidios para el empleo para trabajadores menores de 24 años.
Para la ministra Matthei está es una oportunidad para Chile, ya que “queremos competir con nuestros vecinos con mayor productividad, no con menores sueldos, aspiramos que los chilenos podamos seguir invitando a empresas extranjeras a que inviertany producir mucho mejor”.
El gerente general de Maersk-Chile, Francis McCawley, en tanto, destacó que las personas interesadas deben “tener ganas de trabajar y ser productivos. Eso es lo que necesitamos” y agregó que con esto Chile se transforma en un plataforma, ya que “todos estos contenedores que vamos a fabricar acá, las compañías navieras no necesitan traerlos de otros lados, los van tomar desde acá y van a iniciar el ciclo completo”.
Hasta la fecha –como aún no hay construcción, pues se inicia con la primera piedra- se han contratado 16 ingenieros locales, 9 ingenieros extranjeros, y otros apoyos, que totalizan 35.
Según estimaciones del Ministerio del Trabajo, de acuerdo a información del INE, el efecto en empleo que produciría la planta equivale a una reducción de hasta cuatro puntos en el desempleo provincial, que es uno de los más altos del país.
Los plazos de contratación y puesta en marcha de la planta: 1. En diciembre 2012 debiera estar contratado entre el 10 %y el 15% de la mano de obra operativa 2. En abril 2013, entre 30% y el 35% de la mano de obra ya estaría contratada.
3. En octubre 2013, se llegaría al 50% de la dotación operativa.
4. Entre octubre 2013 y abril 2015 se completará la dotación proyectada de 1800 personas de nivel operativo y se llevará la fábri ca al 100% de su capacidad productiva.
Según la Empresa la estructura de contratación por año y desagregación de los operarios es la siguiente:
|
Soldadores |
Pintores |
Especialistas |
Total |
año1 |
450 |
60 |
450 |
960 |
año2 |
330 |
20 |
225 |
575 |
año3 |
220 |
20 |
225 |
465 |
Total |
1000 |
100 |
900 |
2000 |
Ministerio del Trabajo
DHL cuida el medio ambiente en Chile ofreciendo servicios de envío exprés con emisión neutra de carbono
Last changed: may 02, 2012 19:08 by Editor Portal Minero Labels: dhl, huella, carbono
*
Los nuevos servicios de reporte miden la huella de carbono y calculan la emisión total de carbono
*

19 de Abril de 2012.- DHL, el líder mundial de servicios de envío internacional exprés, está lanzando tres servicios en Chile para ayudar a los clientes a reducir sus emisiones de dióxido de carbono (CO2). Los nuevos servicios incluyen un servicio de envío con emisión neutra de carbono, así como reportes para medir la huella de carbono y calcular el total de emisiones de CO2 para todos los envíos procesados por DHL. Los servicios estarán disponibles a partir del 23 de abril.
Los nuevos servicios GOGREEN para América Latina son los siguientes:
El servicio DHL GOGREEN Carbon Neutral compensa el 100% de las emisiones de CO2 generadas por los envíos de tiempo definido manejados por DHL Express. Esto ofrece una opción de envío ambientalmente responsable, mediante la cual DHL Express calcula el total de emisiones de CO2 para los envíos de la cuenta de un cliente específico y compensa las emisiones al invertir en proyectos de protección ambiental, tal como una planta de energía eólica en Nicaragua y una planta hidroeléctrica en Brasil. Los clientes también reciben un certificado anual que confirma la compensación lograda en el volumen de emisiones gracias al uso del servicio; este certificado puede utilizarse como apoyo para su contribución con los mandatos corporativos de sostenibilidad. Los clientes ya utilizan este servicio de forma satisfactoria en más de 45 países.
El Reporte DHL GOGREEN Carbon Footprint mide el impacto de las emisiones de CO2 en el servicio de transporte de cada cliente y ofrece reportes detallados trimestrales y anuales. Estos reportes están disponibles por ruta de comercio (por ejemplo, de China a México), por modalidad de transporte, por número de cuenta y por periodo.
El Reporte DHL GOGREEN Carbon Estimate genera un estimado de las emisiones de CO2 de un cliente. Los clientes reciben una instantánea de sus emisiones de CO2 relacionadas con el número total de envíos, el peso y el medio de transporte. El reporte cubre el trimestre previo y está disponible para todas las cuentas de DHL Express o las cuentas seleccionadas de un cliente. “Al introducir estos valiosos servicios del programa GOGREEN en América Latina, DHL Express ofrece a los clientes de la región una nueva oportunidad única de calcular y neutralizar las emisiones de CO2 generadas por sus actividades de envío exprés, y para demostrar su compromiso con la protección ambiental y la sostenibilidad corporativa", dijo Segundo Pizarro, Gerente General de DHL Express, quien además agregó que “las compañías pueden utilizar estos reportes para respaldar sus esfuerzos globales de reducir su huella de carbono, dar seguimiento a su progreso en comparación con sus objetivos corporativos de sustentabilidad y buscar maneras de administrar sus recursos con mayor eficiencia y mayor rentabilidad".
Para garantizar la rendición de cuentas y la transparencia, los cálculos y la metodología de los servicios GOGREEN se verifican de forma anual conforme a los principios ISO 14064 a través de un organismo de certificación independiente, la Société Générale de Surveillance S.A. con sede en Suiza.
Estos servicios son parte del programa GoGreen de Deutsche Post DHL, una iniciativa de protección ambiental global dirigida a apoyar el compromiso de la empresa para hacer una contribución positiva al mundo y ofrecer a nuestros clientes soluciones innovadoras y sustentables. DP DHL fue la primera empresa en la industria de la logística en establecer una meta de protección climática mesurable.Tomando el año 2007 como base, estableció el objetivo de mejorar su eficiencia de emisiones de CO2 en 30% para el año 2020 a nivel mundial, incluyendo todos los servicios de transporte proporcionados por los contratistas. En 2010, la empresa alcanzó un objetivo provisional de mejorar en 10% la eficiencia de reducciónde emisiones de CO2, dos años antes de su objetivo original.
La iniciativa mundial GoGreen incluye medidas com sustituir para el 2015 el 15% de las aeronaves de la empresa por aviones con mayor eficiencia en el consumo de combustible; desviar envíos de transporte aéreo a transporte por carretera, mar y ferrocarril, y de carretera a ferrocarril siempre que sea viable; sustituir los vehículos terrestres antiguos por camiones y camionetas con mayor eficiencia en el consumo de combustible; capacitar a los conductores para que manejen de forma que ahorren más combustible y optimizar la estructura de las rutas. La empresa ha diseñado vehículos de transporte de mayor eficiencia aerodinámica y está probando más de 4,000 nuevas tecnologías de ahorro de energía a nivel mundial.
Durante varios años, DHL Express ha adelantado las iniciativas de GoGreen en América Latina no sólo en cuanto a su negocio, sino también en materia de las comunidades y el medio ambiente. En este contexto, empleados de DHL Express han plantado voluntariamente árboles en lugares emblemáticos de Santiago, contribuyendo concretamente a la reforestación de la capital.
DHL
Experto del Centro de Excelencia en Geotermia Aplicada visita la USM
Last changed: may 02, 2012 19:08 by Editor Portal Minero Labels: usm, geotermia, aplicada
Su principal objetivo es generar y desarrollar importantes vínculos académicos entre ambas instituciones, que permitan solventar la necesidad de capital humano que exige el sector.

19 de Abril de 2012.- Generar y desarrollar importantes vínculos académicos con el Centro de Excelencia en Geotermia Aplicada(CEGA) fue el principal objetivo de la visita de su director, el profesor Diego Morata, a la Universidad Técnica Federico Santa María, oportunidad en la que también ofreció al alumnado una charla sobre el Desarrollo de la Geotermia en Chile, ambas, actividades gestionadas con apoyo de la Oficina de Asuntos Internacionales (OAI) y por el Centro de Automatización y Supervisión para la Industria Minera (CASIM).
En el encuentro también participaron el profesor del Departamento de Electrónica y director de CASIM, Jorge Pontt, el profesor del Departamento de Ingeniería Química y Ambiental, Patricio Núñez, el director del Centro de Economía y Administración de Recursos Sólidos (CEARS), Gerd Reinke y el director general de Investigación y Postgrado, Alexander Quaas quienes presentaron y revisaron la apuesta académica de la USM vinculadas a una disciplina como la geotermia.
En base a esto último, el profesor Pontt destacó que esta Casa de Estudios abrirá próximamente la Carrera de Ingeniería Civil de Minas y que anteriormente impulsó el desarrolló del CASIM, además de precisar que existen áreas de estudios que constantemente prestan su apoyo y están involucradas con el rubro minero.
Por su parte, el también profesor del Departamento de Geología de la Universidad de Chile, precisó que “este es sin duda un primer acercamiento, que permite estudiar como la USM puede ser parte del CEGA en temas de investigación a fines con la disciplina que se maneja. Además conozco la excelente labor que realiza la Universidad y creo que están todas las posibilidades para trabajar en conjunto”.
Además indicó que “la geotermia se presenta como un campo sumamente amplio, más aún cuando empiece a operar la primera planta geotérmica. Esto significa que debemos contar con el capital humano necesario o sino deberemos contar con ingenieros venidos desde el exterior, pudiendo nosotros formarlos. Se trata de una necesidad de país y la idea es preparar a los futuros profesionales que trabajarán de manera efectiva en el rubro de la geotermia”.
Cabe destacar que se ha convenido una colaboración entre el CEGA (U. de Chile) y CASIM (UTFSM) para el desarrollo científico, tecnológico, proyectos conjuntos y difusión a la comunidad, con el foco en energías renovables y minería.
UTFSM
Anglo American dio inicio a la edición 2012
del Programa Emerge
Last changed: may 02, 2012 19:08 by Editor Portal Minero Labels: anglo, programa, emerge, uai
La iniciativa se desarrolla desde 2007 y busca potenciar y contribuir al desarrollo económico y bienestar de las comunidades.

19 de Abril de 2012.- Anglo American dio inicio a las clases de la generación 2012 del Programa Emerge, integrada por 80 nuevos emprendedores pertenecientes a las regiones de Antofagasta, Atacama, Valparaíso y Metropolitana.
La iniciativa de Anglo American, que se desarrolla por quinto año consecutivo, busca contribuir al desarrollo económico y bienestar de las comunidades cercanas a las operaciones de la empresa, impulsando los negocios de emprendedores de dichas localidades. Esto les permitirá no sólo mejorar su propia calidad de vida de forma sustentable, sino que además podrán apoyar a otros a través de la generación de nuevos puestos de trabajo.
Para esto, el programa capacita a través de un diplomado del programa eClass de la Escuela de Negocios de la Universidad Adolfo Ibáñez –que tiene una duración de 33 semanas y combina clases presenciales con tareas y evaluaciones por internet–, entrega asesoría comercial permanente para la elaboración de un plan de negocios y otorga la posibilidad de postular a financiamiento a través de un crédito blando a aquellos emprendimientos que demuestren viabilidad económica en sus iniciativas.
“Para Anglo American, dar inicio a una nueva generación de nuestro Programa Emerge es una gran satisfacción que confirma nuestro compromiso por generar nuevas oportunidades de desarrollo, contribuir al progreso y entregar mayores herramientas que ayuden a mejorar la calidad de vida de las comunidades en las cuales estamos presentes”, afirmó Úrsula Weber, gerente de Desarrollo Social de Anglo American.
Sobre el Programa Emerge
El Programa Emerge, ha apoyado hasta la fecha a más de 25 mil emprendedores a través de dos líneas de trabajo:
-Emerge - Microempresarios: A través de una alianza con Fondo Esperanza, se entregan micro-créditos y educación emprendedora a pequeños empresarios agrupados en Bancos Comunales, lo que fomenta la organización y la solidaridad. Hasta la fecha se ha apoyado a más de 25 mil emprendedores.
-Emerge- Potenciando Negocios: Enfocado en potenciar a aquellos emprendedores que se encuentran en etapa de desarrollo y están en busca de una oportunidad para crecer. Para ello, Anglo American ha elaborado una metodología que contempla cuatro aspectos esenciales: capacitación, asesoría y financiamiento a través de un crédito blando a las iniciativas que demuestren ser económicamente viables. Hasta la fecha se ha apoyado a más de 200 emprendedores.
Anglo American
2012/04/18
Destacada participación de Sika Chile en Expomin 2012
Last changed: may 02, 2012 19:08 by Editor Portal Minero
Sus últimos desarrollos, como son el supresor de polvos para caminos y el revestimiento para blindaje de hormigón, fueron algunas de las tecnologías que expuso la multinacional en la feria.

18 de Abril de 2012.- Nuevas soluciones que contribuyen a la seguridad y eficiencia de procesos en la minería—además de ser amigables con el medio ambiente— fueron las que presentó Sika Chile en la versión 2012 de Expomin, la cual tuvo lugar en Espacio Riesco del 9 al 13 de abril y contó con la cifra récord de 70.000 asistentes.
Líneas de productos asociadas principalmente a fortificación subterránea, protección a impacto y abrasión, mantenimiento de vías y revestimientos industriales fueron las que expuso la multinacional suiza en su stand a lo largo del encuentro. Entre éstas, cabe mencionar las nuevas soluciones desarrolladas específicamente para la industria minera, como son: El supresor de polvos para caminos Sika® Dust Seal y los revestimientos para blindaje de hormigón Sikadur® Steel.
“Expomin fue una instancia que nos permitió efectuar el lanzamiento de nuestros últimos desarrollos y cumplir el objetivo principal de dar a conocer a la industria nuestro compromiso de negocios en la minería, reforzado con un claro enfoque en sus procesos industriales”, señaló Rodrigo Caballero, Key Project Manager de Sika Chile.
Además de ser Expomin una oportunidad para presentar tecnologías y productos, para Sika fue una instancia para reafirmar su compromiso con el desarrollo sustentable y el medio ambiente, ya que se adhirió a un programa de neutralización de emisiones de Carbono provenientes tanto de su stand como de sus delegaciones. Invitación que hizo Fisa a los expositores a través de la empresa Proyectos Globales.
“Dentro de nuestros valores como compañía existe un punto especial dedicado a la sustentabilidad, el cual hace hincapié en favorecer un desarrollo sustentable. Por ello, nos adherimos a esta causa, la que está justamente en línea con nuestros valores y acciones”, agregó Juan Francisco Jiménez, Gerente General de Sika Chile.
Sika
USM Sede Concepción dicta cursos especializados de soldadura a empresas de la región
Last changed: may 02, 2012 19:08 by Editor Portal Minero

18 de Abril de 2012.- Comenzó esta semana la segunda versión del “Programa de Formación Avanzada en Soldadura”, realizado por la Universidad Técnica Federico Santa María Sede Concepción, dirigido a quienes cumplen funciones de supervisión en temas relacionados con soldadura al interior de las empresas metalmecánicas de la región del Bío Bío.
La iniciativa tiene un total de 90 horas de duración, con clases teóricas y prácticas, y aborda los temas metalurgia física de los aceros, tratamientos térmicos en los procesos de soldadura, efecto de la temperatura en las uniones soldadas, normas y procedimientos, manejo de gases y seguridad en los procesos de soldadura y corte de metales, y soldadura de aceros inoxidables.
El Programa se enmarca en el trabajo que por años ha implementado la casa de estudios y que ha permitido el acercamiento y colaboración con empresas del sector metalmecánico de la zona, “transformando las necesidades del sector en proyectos exitosos, con impacto y beneficio directo para las pymes”, indicó el Director del Departamento de Desarrollo y Proyectos Externos (DDPE), a cargo de la iniciativa, Alejandro Navarro.
Una muestra de este trabajo en conjunto, destinado a mejorar la competitividad de las empresas de la Región, fue el proyecto “Capital Humano Metalmecánico”, que permitió formar a 120 trabajadores en Calderería Estructural, instalar capacidades en la Universidad y capacitar a docentes por un profesional experto en construcciones metálicas proveniente de la Fundación Metal Asturias - España.
Cabe señalar que hace unas semanas culminó la primera versión del “Programa de Formación Avanzada en Soldadura”, gestado en el marco del “Programa de Gestión para la Transferencia de Tecnologías en Soldadura para la Industria Metalmecánica de la Región del Bío Bío”, cofinanciado por InnovaChile de Corfo. Dicha iniciativa se ejecuta en asociación con las empresas Orecal Ltda., Servohidraulica Ltda., Tecbio S.A., Prosein Ltda. y Prosteel Ltda., cuenta con la colaboración de la Asociación de Industrias Metalúrgicas y Metalmecánicas de la Región del Bío Bío (A.G. Met Bío Bío) y Fundación Metal Asturias de España, y está enfocada a la asistencia técnica en temas de soldadura, la difusión tecnológica y la formación avanzada, entre otros temas, constituyendo con ello las bases para la implementación del Centro de Transferencia Tecnológica de la USM Sede Concepción: METALTEK.
Próximamente, la Universidad pondrá en marcha un Laboratorio de Ensayos Mecánicos y Metalográficos con equipos de estándar internacional, y adquirirá un simulador de soldadura, herramienta de alto nivel tecnológico que contribuirá de forma significativa a los procesos de formación de soldadores.
UTFSM
Schreder Chile Presenta Nueva Luminaria Teceo Para Zonas Urbanas
Last changed: may 02, 2012 19:08 by Editor Portal Minero

18 de Abril de 2012.- Schréder Chile lanzó al mercado su nueva luminaria LED TECEO, para zonas urbanas, aplicaciones industriales y mineras, que destaca por mejorar los niveles de luz, generar ahorro de energía y reducir el impacto ecológico.
LED TECEO es una luminaria eficiente, que ofrece iluminación justa, con menos consumo y amigable con el medio ambiente. Aporta a la eficiencia energética y a la calidad de vida de las personas.
La gama TECEO está disponible en dos tamaños: TECEO 1, de hasta 48 LED, ideal para iluminar calles residenciales, carreteras urbanas, ciclovías, estacionamientos, condominios, calles internas de flujo de camiones, etc; y TECEO 2, de hasta 144 LED, orientada a grandes carreteras, avenidas, autopistas.
Este último modelo está equipado con la segunda generación del motor fotométrico LensoFlex2, que ofrece una fotometría de altas prestaciones optimizada para cada aplicación, con un consumo mínimo de energía.
Estas luminarias, que cumplen 100% con la normativa de seguridad vigente según el DS 298, ofrecen módulos de LED flexibles, una selección de corrientes de alimentación y opciones de variación de intensidad para potenciar aún más el ahorro de energía y entregar una solución altamente rentable.
Además, pueden ser ajustadas in situ, lo que garantiza que las prestaciones fotométricas estén específicamente adaptadas a las necesidades reales del área que se debe iluminar.
Cabe señalar que se dispone de una versión con brazo trasero de TECEO, para poder iluminar con el mismo diseño de luminaria calles, calles laterales y grandes calzadas.
Usando tecnología de punta, las luminarias TECEO están diseñadas cumpliendo el concepto FutureProof. El motor fotométrico tiene una hermeticidad IP 66 para proteger a los LED y lentes, en tanto que la unidad óptica puede quitarse fácilmente, lo que permite su recambio in situ al final de su vida útil, de manera fácil y rápida, reduciendo costos de mantenimiento.
Schreder Chile
Geek Fantasy Camp premió a 11 proyectos
Last changed: may 02, 2012 19:08 by Editor Portal Minero

18 de Abril de 2012.-
IncubaUC, incubadora de negocios de la Pontificia Universidad Católica de Chile, premió a once proyectos en la segunda versión de “Geek Fantasy Camp”, el primer Bootcamp del país que busca entregar un espacio de trabajo durante 5 días y dos noches a estudiantes. Emprendedores y empresarios TICs con ganas de innovar y llevar sus ideas a prototipo en Silicon Valley, California, Estados Unidos.
A partir de la próxima semana los proyectos ganadores comenzarán con el proceso de mentoría para luego viajar a Silicon Valley en Julio.
Esta segunda versión de Geek Fantasy Camp comenzó el Miércoles 11 de Abril en el Campus San Joaquín de la Pontificia Universidad Católica y concluyó el Domingo, y su proceso de postulación fue de manera abierta, con un llamado dirigido a empresarios, emprendedores y alumnos de distintas universidades, quienes desarrollaron sus proyectos e interactuaron con mentores y expertos nacionales e internacionales.
Dicha convocatoria arrojó un total de 130 proyectos y casi 300 asistentes trabajando 5 días y dos noches en El Domo de IncubaUC, generando muy buenos proyectos, formando lazos y haciendo negocios de alto nivel.
“Fueron 5 días y dos noches en las que el emprendimiento TIC en Chile dio grandes frutos, con proyectos de amplia calidad y envergadura consolidamos un evento que en cada nueva versión esta tomando mejor forma y promete ir mejorando en el tiempo aún más. La calidad estuvo muy buena, recibimos proyectos muy variados e innovadores, y nos costó mucho deliberar a la hora de elegir los ganadores, lo que es muy bueno para nosotros que siempre hemos tenido por política premiar a los buenos proyectos sin importar cuantos sean. Esperamos para nuestro evento de Agosto no sólo doblar la cantidad de postulantes, sino también aumentar la calidad de los mismos.”, afirmó Marcelo Díaz Bowen, Gerente de IncubaUC.
Díaz recalcó que uno de los puntos claves fue la motivación y el compromiso que tuvieron los emprendedores durante el evento, ya que jamás bajaron los brazos y hubo un compañerismo que se dejó notar en cada etapa clasificatoria, lo que dejó ver el lado “B” de los participantes, formando en esta ocasión un grupo bastante unido y de alta proyección profesional. Cabe señalar que todo esto podrá ser visto en el Docureality “El Domo” que será próximamente transmitido por C13 Cable.
Otro factor a considerar fue la masificación mediática y el interés que ha causado en la empresa privada este evento, quienes ya se han acercado para ser parte de la próxima edición de Geek Fantasy Camp que se realizará en Agosto.
“Estamos al tanto del interés de la empresa privada por invertir en Geek Fantasy Camp, por lo que ya estamos trabajando en una nueva propuesta para la tercera versión que se realizará en Agosto, la que traerá muchas sorpresas y avances en términos de marketing. El Bootcamp de IncubaUC se está consolidando de a poco como el evento TIC más importante de Chile y tenemos que estar a la altura del mercado con una oferta de valor que sea atractiva y efectiva, con un alto retorno para nuestros clientes y un posicionamiento segmentado que sea un aporte para las marcas que depositen su confianza en este evento”, afirmó Sharif Laibe, Encargado de Marketing de IncubaUC.
Los ganadores son:
- What if?
- Ability
- Get List
- 3S
- Flea Box
- Sustainable Tripper
- Bumbrella
- Latamticket.com
- Anacromo
- I scope
- Familink
Incuba UC
CEO Rockwell Automation visita sucursal de Santiago
Last changed: may 02, 2012 19:08 by Editor Portal Minero

18 de Abril de 2012.- El CEO y presidente de Rockwell Automation,Keith Nosbusch, estuvo de visita en Santiago, como parte de su gira por Sudamérica.
La llegada deNosbusch, quien se ha mantenido en el cargo de CEO desde 2004, representa el objetivo de esta empresa líder en procesos de automatización, por reforzar las estrategias que buscan potenciar la presencia de Rockwell Automation en el mercado local.
Entre los hitos que han marcado su experiencia en Rockwell Automation se puede mencionar el lanzamiento de ControlLogix®, la principal plataforma integrada de control e información de esta empresa.
“Chile es un país que está en constante crecimiento y para nosotros es fundamental la integración de nuevos Partners y la capacitación de los profesionales que permitan proporcionar las mejores soluciones a nuestros clientes locales del sector industrial y minero”. Expresó Keith Nosbusch, CEO de Rockwell Automation.
Su paso por Chile forma parte de las estrategias para consolidar la participación de Rockwell Automation en Latinoamérica en los sectores de la Minería y Energía. Por ello, visitó otros lugares de la región como Brasil, Perú, Ecuador y Panamá.
Rockwell Automation
Culminan cursos de HDM-4 impartidos por el ICH
Last changed: may 02, 2012 19:08 by Editor Portal Minero
Como una manera de incentivar el concepto de gestión de infraestructura, atendiendo los efectos de la conservación en el largo plazo, el ICH impartió estos cursos en sus niveles básico y avanzado, en los que participaron distintos profesionales de Chile,

18 de Abril de 2012.- Dadas las restricciones de presupuesto siempre presentes para la gestión de obras nuevas de infraestructura vial o para la conservación de las mismas, en Latinoamérica se hace necesario realizar análisis de inversión de una manera metódica y coherente, que faciliten y soporten la toma de decisiones sobre las mejores alternativas conducentes a un uso eficiente y óptimo de recursos alcanzando estándares de calidad acorde a las exigencias y requerimientos del tipo de infraestructura evaluada.
En ese sentido, existen distintas herramientas a las que se puede acudir para facilitar la toma de decisiones y que permiten hacer las cosas cada vez de mejor manera. Una de ellas es el HDM-4 ((Highway Development and Management), creado para ayudar a efectuar una mejor gestión y administración de redes viales en general.
Precisamente con el objetivo de incentivar el concepto de gestión de infraestructura y, por supuesto, el empleo de la herramienta, el Instituto del Cemento y del Hormigón de Chile (ICH) ofreció el curso teórico-práctico de HDM-4, tanto para el nivel básico como el avanzado, contando en esta edición con la participación de profesionales de Bolivia, Brasil, Chile, Perú y Uruguay.
“Este es un instrumento que bien aprovechado puede ser una herramienta muy poderosa, pues permite y facilita la toma de decisiones en términos de infraestructura vial, de una manera técnicamente objetiva y bien soportada”, afirma Mauricio Salgado, jefe del Área Pavimentación del ICH.
Su empleo facilita una correcta planeación de los recursos, sin dejar de lado la conservación de los pavimentos. “Si bien es cierto que es necesario destinar recursos a la conservación, no puede ser que por gastar más en este ítem se tenga que renunciar al crecimiento y desarrollo futuro, que es lo que está sucediendo en la actualidad”, explica Salgado. De esta manera, el grueso de la inversión pública se está yendo a planes de conservación.
“Nos interesa que se utilice el HDM-4 como herramienta, ya que a través de ésta se incentiva el concepto de gestión de infraestructura, atendiendo que la evaluación de proyectos no debe hacersesolamente con una mirada cortoplacista o de costo directo, sino que se evalúen los efectos que tiene la conservación en el largo plazo”, ratifica el jefe del Área de Pavimentos del Instituto del Cemento y del Hormigón de Chile.
Diversas experiencias
Es lo que entendieron los distintos participantes que tuvo el curso HDM-4 dictado en el ICH, como Santiago Caballero, quien fue enviado por la empresa CAF de Uruguay a aprender el nivel avanzado de este software.
“Me interesaba mucho conocer la parte teórica, entender bien cuál es la lógica del sistema, cómo se llega a cada cálculo, porque necesito evaluar el trabajo de terceros y entender un poco más cómo funciona me permite mirar desde otros puntos de vista esos trabajos”, cuenta Santiago Caballero.
En tanto, Mario Becerra Salas, de la Unión de Concreteras (Unicon) de Perú, sostiene que en su país están interesados en repotenciar los pavimentos de hormigón. Sin embargo, han visto vacíos técnicos y de gestión en la administración y en los consultores peruanos, por lo que Unicon decidió donar 15 licencias del HDM al Ministerio de Transporte y Comunicaciones de Perú para mejorar esta área a nivel nacional. Y vino a actualizar y certificar sus conocimientos sobre HDM al ICH, ya que para concretar la donación necesitaban capacitar y dar soporte a la gente del ministerio. “El ICH tiene un reconocimiento a nivel regional y cuenta con el valor agregado de ser parte del Consorcio HDM Global”, considera Mario Becerra.
Por su parte, para Ángel Rozas, de OHL Concesiones de Chile, asistir al nivel básico del curso le sirve para actualizar los conocimientos que ya poseía de este software que aplica en los planes de conservación de tres autopistas que maneja en la actualidad esa concesionaria.
“Si bien ya tengo una base para programar las mantenciones en el futuro, lo que me exigía la concesionaria era tener un flujo de caja hacia el futuro respecto de la conservación que se deba realizar, lo que se puede hacer de una manera más precisa con un programa de esta naturaleza”, especifica Ángel Rozas.
Asimismo, los alcances de este software dan para otras áreas, como la que representa Alfonso Malky, de la ONG Conservación Estratégica de Bolivia, que trabaja en conservación de la biodiversidad desde un punto de vista económico. “Uno de los temas importantes que desarrollamos es el análisis de proyectos de infraestructura, principalmente aquéllos que se desarrollan en Amazonía y que tienen un impacto en términos de biodiversidad, como carreteras y empresas hidroeléctricas”, indica.
Si bien la principal herramienta que utilizan en la ONG para elaborar sus informes es el modelo RED desarrollado por el Banco Mundial, tenían el interés de conocer el HDM-4, que le ha permitido a Alfonso Malky aprender algunos tópicos más específicos, relacionados con el análisis de carreteras vinculados a mantenimientos.
“Cuando aplicamos el modelo RED, hacemos el análisis del proyecto sin incorporar externalidades sociales o impactos indirectos, que es lo que hace el HDM-4 y creo que en eso nos puede ser bastante útil”, considera. Por lo pronto, el ICH planea repetir estos cursos en los próximos meses. Más información en el correo hdm4@ich.cl.
ICH
2012/04/17
DECLARACIÓN DE OLAMI
Last changed: may 02, 2012 19:08 by Editor Portal Minero

17 de Abril de 2012.- La Asamblea General del Organismo Latinoamericano de Minería –OLAMI-reunida en la ciudad de Santiago de Chile, a los once días del mes de abril de 2012, reafirmando su compromiso con el cumplimiento de las Metas del Milenio y el Desarrollo Sostenible de las Naciones Unidas y considerando que:
·América Latina posee el 15% de la superficie terrestre mundial, el 9% de la población del planeta y genera el 8,7% del PIB, sin embargo, es uno de los distritos mineros más relevantes del orbe.
·La región es receptora de un monto significativo de recursos destinados a la exploración mineray a la inversión para desarrollar proyectos mineros. En efecto, latinoamérica captó el año 2011 el 25% del gasto mundial en exploración, esto es, US$ 4.500 millones de los US$18.200 millones que se desembolsaron a nivel global, adicionalmente, durante esta década se invertirán más de US$300.000 millones, para desarrollar proyectos mineros y es la región líder en producción de plata, cobre, renio, nitratos, litio, yodo y otros minerales.
·La fase de alta demanda de materias primas que se registra actualmente, genera una gran oportunidad para América Latina respecto de otras regiones del mundo como Africa y Asia. ·La minería es esencial para el desarrollo económico y social de los pueblos y, desarrollada de manera responsable, contribuye significativamente a la superación de la pobreza; ·El desarrollo sostenible y la minería responsable deben incluir aspectos sociales, culturales, económicos, políticos y ambientales;
- El aprovechamiento responsable de los recursos naturales es compatible con la protección de la naturaleza;
- La actividad minera formal se desarrolla en armonía con todos los sectores productivos;
- Es necesario fortalecery preservar la institucionalidad minera y la seguridad jurídica de los países;
- En la región latinoamericana reconocemos la existencia de diversos grados de desarrollo minero asociados a institucionalidades propias de cada país;
- Reconocemos la existencia de diversas visiones sobre la industria minera;
Por ello, resolvemos instar a todos los actores concernientes a,
·Generar espacios de diálogo frente a un desarrollo minero responsable y participar activamente en los mismos. ·Analizar exhaustivamente la distribución de los beneficios de la actividad minera e implementar los cambios indispensables para mejorar dicha distribución, garantizando la utilización responsable y diáfana de los tributos mineros en beneficio de las comunidades. ·Promover la formación de recursos humanos calificados para posibilitar el desarrollo del sector, bajo el concepto de minería responsable. ·Acordar principios que guíen la conducta de todos los actores en los aspectos sociales, ambientales y económicos. ·Difundir información técnica sobre la actividad minera en forma veraz y accesible para la comunidad en general y evitar dicotomías equívocas que enfrentan la vida con la industria minera. ·Propiciar la reactivación de la Conferencia de Ministerios de Minería de las Américas (CAMMA) como espacio imprescindible de vinculación de los gobiernos en temas sectoriales
Portal Minero
Ministro Bunster participó del 48° aniversario de la Comisión Chilena de Energía Nuclear
Last changed: may 02, 2012 19:08 by Editor Portal Minero
En una de sus primeras actividades como titular de Energía, Jorge Bunster destacó el aporte realizado por el servicio en sus casi cincuenta años de historia.

17 de Abril de 2012.- Los grandes aportes en materia de investigación y uso pacífico de la energía nuclear fueron sólo algunos de los temas destacados por el Ministro de Energía, Jorge Bunster, en el aniversario de la Comisión Chilena de Energía Nuclear, CChEN.
"Durante casi cinco décadas, la Comisión ha realizado avances fundamentales para la investigación y desarrollo de esta materia y ello no hubiese sido posible sin el arduo trabajo de cada una de las personas que han sido parte de la institución", dijo el Ministro Bunster en la ceremonia celebrada en el Círculo Español de Santiago.
Para el jefe de la cartera, impulsar el estudio de este tipo de energía es clave, más aún en momentos en que aumentar y diversificar nuestras fuentes energéticas se ha convertido en algo indispensable.
"Pero nuestra realidad de país sísmico, nos pone en un dilema”, aclaró el Ministro. "Es por esto, que nuestro Gobierno, y así ha sido expresado tanto por el propio Presidente Sebastián Piñera, como refrendado en la Estrategia Nacional de Energía, no tomará decisiones –en este periodo- en materia de utilización de energía nuclear para la generación de electricidad".
No obstante, el Ministro Bunster enfatizó que el Gobierno está interesado en continuar con los estudios e intercambios de información, capacitación y formación de expertos y profesionales con los países desarrollados.
En este marco, el año pasado Chile firmó un importante Memorándum de Entendimiento con Estados Unidos. Éste se suma a otros acuerdos y convenios con diferentes naciones, como Francia, Bélgica, y Corea, entre otras.
"En todo este proceso, el trabajo de la Comisión Chilena de Energía Nuclear ha sido y será clave", aseguró el Ministro. "Sin duda será fundamental para que los Gobiernos venideros estén en condiciones de adoptar definiciones en esta materia, de manera responsable, y siempre, con la participación y el adecuado conocimiento de la comunidad".
Ministerio de Energía
NIÑO GANA VIAJE AÉREO PARA CONOCER CHUQUICAMATA EN APERTURA DE SALA MINERA DEL MIM
Last changed: may 02, 2012 19:07 by Editor Portal Minero
Sala busca acercar a las familias los procesos y aplicaciones de la minería. Desarrollo de la iniciativa contó con el auspicio del Consejo Minero y el patrocinio del Ministerio de Minería.

17 de Abril de 2012.- El ministro de Minería, Hernán de Solminihac, junto al presidente ejecutivo del Consejo Minero, Joaquín Villarino, la directora ejecutiva del Museo Interactivo Mirador (MIM), Consuelo Valdés, y la directora de las Fundaciones de la Presidencia, María Magdalena Díaz, abrieron esta mañana al público el primer espacio minero interactivo que busca acercar de manera entretenida a los visitantes la principal actividad económica del país.
Luego de dos años de trabajo, en la que participaron diseñadores, educadores e ingenieros, entre otros, la Sala de Minería del MIM cuenta con una serie de módulos mecánicos y multimedia que apoyan temáticas como la historia de la minería en Chile, procesos de extracción, usos del cobre y seguridad minera.
“La minería es el motor de la economía del país, por eso tenemos que acercar su actividad a quienes están más lejos de sus faenas. Así que esperamos que este espacio sea una oportunidad para llevar la educación fuera de las salas de clases, y para que las niñas y los niños puedan jugar aprendiendo”, destacó Solminihac.
El presidente ejecutivo del Consejo Minero, en tanto, señaló que este espacio permitirá mostrar a los niños, y a través de ellos a los adultos, en qué se diferencia la minería moderna de la antigua minería. “Quienes vayan al MIM podrán darse cuenta de la enorme importancia que la gran minería hoy da a la seguridad, y también al cuidado del medio ambiente y a las relaciones con las comunidades del entorno de sus operaciones. Como asociación estamos tratando de dar a conocer esta minería moderna, y la Sala de Minería del MIM será un aporte para eso", precisó Joaquín Villarino.
Por su parte, la directora del MIM explicó que los módulos en la Sala de Minería están creados para explicar, informar, pero por sobre todo generar curiosidad sobre una de las temáticas cruciales para un país minero, como lo es Chile. “Porque sin preguntas no hay respuestas, por eso buscamos que todos nuestros visitantes se cuestionen y se motiven a buscar más de lo que pueden encontrar acá. El museo interactivo es sólo el detonante de algo que continúa más allá de sus muros, y que esperamos, en lo posible, contribuya a generar más técnicos y científicos a futuro”, agregó Consuelo Valdés.
Tras recorrer la nueva sala minera, las autoridades y los ejecutivos presentes sorprendieron con premio de un pasaje aéreo para conocer Chuquicamata a uno de los 20 niños del colegio municipal la Casa Azul de La Granja, junto a unos de sus padres.
Gracias a una invitación de Codelco Chuquicamata, el estudiante Jimmy Aedo, de séptimo básico, fue favorecido al responder correctamente las preguntas del nuevo animador virtual que tiene como atracción el espacio minero, en un concurso que pone a prueba los conocimientos en “¿Quién sabe más de minería?”.
Atracciones del nuevo espacio
Al interior de la nueva Sala de Minería, los visitantes podrán entre otras cosas, “vestirse” con distintos equipamientos que se usan en una mina. También, a través de los módulos, conocerán los niveles de protección existentes en trabajos a rajo abierto, subterráneos y fundición.
La sala además cuenta con áreas que explican cómo instala una mina y cómo se realizan los sondajes o búsquedas subterráneas de yacimientos de cobre.
El nuevo espacio está abierto para todo el público y dispone de guías especializados para orientar a los visitantes en cada módulo.
En paralelo, los profesores que visiten la sala junto a sus alumnos, recibirán material educativo con información y actividades orientadas niveles básicos y medios.
Funcionamiento
La Sala de Minería está en el segundo piso del Museo Interactivo Mirador, ubicado en calle Punta Arenas 6711, en la comuna de La Granja, a la altura del Metro Estación Mirador.
Los horarios de funcionamiento del MIM son de martes a domingo de 9:30 a 18:30 horas.
Ministerio de Minería
Dan a conocer la factibilidad técnica para incorporar ERNC al sistema eléctrico nacional
Last changed: may 02, 2012 19:07 by Editor Portal Minero

17 de Abril de 2012.- Una de las discusiones que hoy está en boga tiene relación con la integración de las energías renovables no convencionales (ERNC) en los sistemas eléctricos nacionales. Es por eso que interesa estudiar y analizar la factibilidad técnica de inserción de ERNC dada la actual configuración del sistema eléctrico nacional. De esta forma, la Asociación Chilena de Energías Renovables (ACERA) entregará los resultados de un estudio denominado “Factibilidad Técnica de la Incorporación de las ERNC al Sistema Eléctrico Nacional”, con el fin de entregar los argumentos al respecto. La investigación fue realizada por el Centro de Energía de la Facultad de Ciencias Físicas y Matemáticas de la Universidad de Chile y liderada por Rodrigo Palma.
La actividad, que se llevará a cabo el próximo 26 de abril en el Auditórium de la SOFOFA desde las 09:00, contará además con la participación de los expertos internacionales Mahesh Marjoria, vicepresidente de Global Grid Integration, y Alvin M. Razon, consultor sénior del Departamento de Energía de Estados Unidos (DOE).
Del mismo modo, expondrán los directores ejecutivos de los CDEC SING y SIC, Daniel Salazar y Eduardo Ricke, respectivamente; Gabriel Olguín, subgerente de estudios de Nuevas Tecnologías de Transelec. Los moderadores de los bloques serán Hugh Rudnick, profesor titular de la Pontificia Universidad Católica de Chile y Ramón Galaz, gerente general de Valgesta.
Junto con la entrega de los resultados del mencionado estudio, el objetivo de la actividad es crear una instancia de análisis, intercambio y difusión con la participación de los CDEC e importantes panelistas nacionales y extranjeros.
De esta forma, se abordarán temas como:
- Qué requieren las ERNC de los sistemas de transmisión y cuál es su impacto sobre ellos
- Cuáles son las implicancias de este tipo de energías sobre la operación del sistema
- Sistema de transmisión seguro y confiable, diseñado para permitir el acceso a todas las fuentes de generación (concepto de carretera y/o multicarrier eléctrico)
- Cómo desarrollar proyectos ERNC que impacten favorablemente en la demanda de los grandes usuarios de energía (clientes libres, industriales, mineros)
- Participación de fabricantes y tecnólogos que facilitan la incorporación de las ERNC en el sistema (nuevas tecnologías, soluciones energéticas eficientes, etc.)
- Institucionalidad sectorial que necesita Chile para el desarrollo de las ERNC hacia el 2020
- Tendencias Internacionales para el desarrollo (innovación y tendencias) e incorporación de las ERNC
El evento se encuentra enmarcado dentro de una serie de actividades que está realizando ACERA durante 2012 como serán el seminario de Impactos macroeconómico de la meta 20/20 a realizarse en agosto y la primera Feria Eó lica y Solar a realizarse en octubre. Esta ocasión será una importante oportunidad para el intercambio de opiniones con autoridades del sector, ejecutivos, profesionales, consultores y docentes vinculados al ámbito de las ERNC en Chile.
Acera
CONICYT adjudica 323 becas de Magíster en Chile
Last changed: may 02, 2012 19:07 by Editor Portal Minero
La convocatoria año académico 2012 de lal concurso de Becas de Magister en Chile destaca por la alta competitividad entre las postulaciones recibidas.

17 de Abril de 2012.-
La Comisión Nacional de Investigación Científica y Tecnológica, CONICYT, ha seleccionado a 323 postulantes en el marco de la Becas para Estudios de Magíster en Chile, Año Académico 2012. De esta forma, CONICYT continúa reafirmando su compromiso con el fortalecimiento de la base científica de nuestro país.
Esta convocatoria del concurso se ha caracterizado por su alta competitividad, dentro de lo cual destaca el hecho de que se recibieron más de 2000 postulaciones lo que implica un aumento considerable en relación a años anteriores. A partir de dicha cifra, se ha establecido una tasa de adjudicación del 18 por ciento.
Los principales seleccionados este año corresponden a las áreas de Física y Astronomía, Ciencias Económicas, Geología y Oceanografía, y Biología.
El 74% de los/las postulantes elige la misma región de su universidad de origen para seguir estudios de magíster. De igual forma, el 52% de los postulantes opta por una universidad distinta a la de pregrado para realizar el magíster.
Seleccionados
Una vez publicados los resultados en el sitio web de CONICYT (www.conicyt.cl) y en sitio del Programa Formación de Capital Humano Avanzado de la Institución (www.becasconicyt.cl), todos los postulantes seleccionados recibirán una comunicación de CONICYT en su casilla de correo electrónico, la cual indicará los pasos a seguir para la aceptación de la beca.
- Para revisar la nómina de seleccionados, pinche aquí.
Notificación individual de resultados
Los resultados del concurso serán notificados a cada postulante (seleccionados, no seleccionados y fuera de bases) vía correo electrónico a la casilla indicada en su postulación, dentro de los próximos días.
- Para revisar la Resolución que aprueba el Fallo, pinche aquí parte 1, parte 2 y parte 3.
- Para revisar el resumen de la adjudicación del concurso, pinche aquí.
Conicyt
Doosan Bobcat Chile S.A. Asume Este Año Como Auspiciador Oficial De
Circuito Tenis 10, En Cuyo Primer Torneo Estara Fernando Gonzalez
Last changed: may 02, 2012 19:07 by Editor Portal Minero

17 de Abril de 2012.- En el marco de su política de Responsabilidad Social Empresarial, Doosan Bobcat Chile S.A. asumió este año 2012 como auspiciador del Circuito Tenis 10 -junto a Babolat-, organizado por Tenischile.com y Entretenis, con el apoyo de la Federación de Tenis de Chile y de la Federación Internacional de Tenis, ITF.
Andrés Miranda, Director de Entretenis, señaló que el Circuito Tenis 10 apunta a que los niños y niñas menores de 10 años puedan jugar de manera más adecuada a su desarrollo y nivel de juego, al tener más tiempo debido al rebote lento de las pelotas y al contar con una cancha de dimensiones más pequeñas, que permiten un mayor alcance.
El primer torneo de este Circuito tendrá lugar el sábado 28 de abril en el Club de Campo del Colegio Médico, ubicado en Avda. La Dehesa 2245, Lo Barnechea, entre las 14:00 y 20:00 horas, y contará con la presencia especial del tenista Fernando González (se adjunta en forma anexa programa de actividades).
La actividad reunirá a niños de entre cinco a 10 años de edad que practican este deporte, quienes competirán en Categoría Cancha Roja, Categoría Cancha Naranja y Categoría Cancha Verde, estando programada una ceremonia de premiación al término del torneo de grupos. Además, se dará un diploma o medalla de reconocimiento a todos los participantes, destacando sus capacidades, entre otras distinciones.
Respecto del auspicio que entrega Doosan Bobcat Chile S.A. a este Circuito, Andrés Miranda señaló que “es altamente destacable que una empresa privada no relacionada directamente con el deporte y en particular con el tenis, decida apoyar a los niños más pequeños en el inicio de su carrera deportiva”.
Por su parte, Alfredo Lagos, Gerente General de Doosan Bobcat Chile S.A., sostuvo que “nos interesó apoyar al tenis nacional porque muchas veces otros deportes como el fútbol reciben gran respaldo, pero en el caso del tenis, más aún en la categoría de menores de 10 años, es necesaria una mayor ayuda para que puedan desarrollar sus capacidades y no queden en el camino por falta de recursos o de oportunidades”.
El Circuito Tenis 10 contempla aproximadamente 8 a 9 etapas, que se disputarán en distintos clubes de tenis y estadios de colonias, incluyendo un master de fin de año con los mejores de cada categoría.
Doosan Bobcat Chile S.A.
2012/04/16
Aurica presenta servicios en Chile
Last changed: may 02, 2012 19:07 by Editor Portal Minero Labels: aurica, demanda, monedas, oro

16 de Abril de 2012.-
Para nadie es un misterio el aumento internacional en la demanda del oro para ahorro o inversión a fin de paliar los estragos de la inestabilidad económica mundial. Por tal motivo, desde mediados del año 2011, se creó en Chile Aurica Metales Ltda., destinada a proveer al mercado local de piezas físicas para inversión financiera, acuñadas en oro por los Gobiernos de Estados Unidos y Canadá.
Conjuntamente con su creación, esta empresa obtuvo el carácter de Agente de Ventas para Chile de la multinacional Kitco Metals Inc., con sede en Montreal Canadá. Dicha canadiense es un referente mundial respecto de la comercialización de piezas de oro para inversión y/o ahorro, con más de 30 años de presencia en el mercado y con facturaciones anuales de más de 3 mil millones de dólares.
En virtud de los TLC´s vigentes entre Chile y los referidos países del norte, Aurica Metales puede importar en forma directa y permanente desde Estados Unidos y Canadá las monedas para inversión que dichos Gobiernos acuñan en oro, sin arancel aduanero. Asimismo, por ser dichas monedas de curso legal y acuñadas en oro, están exentas del Impuesto al Valor Agregado (IVA), según lo confirmado por Servicio de Impuestos Internos.
Desde entonces, podemos ofrecer a nuestros clientes tres de las más prestigiosas monedas para inversión internacional.
Nuestros productos son Gold American Buffaloes, con un 99.99% de pureza, Gold American Eagles, con un 91.67% de pureza, ambas de Estados Unidos, y el Gold Canadian Maple Leaf, también éste con un 99.99% de pureza, acuñado por orden del gobierno de Canadá, todas éstas tienen un peso de 1 Onza Troy (31.103 gramos), siendo éste el estándar internacional para determinar el peso de los metales preciosos. Del mismo modo, contamos con los Gold American Eagles ½ Onza y los Gold American Eagles ¼ Onza, como una forma de ofrecer una mayor gama de productos a nuestros clientes.
Nuestros precios son altamente competitivos y se ciñen estrictamente por el valor spot que el oro registre al momento en que nuestros clientes cerrar un negocio. Sobre dicho valor, se aplican los costes de internación y comisiones. Contamos con precios para mayoristas a fin de poder ofrecer a nuestros clientes mejores precios según el monto que decidan invertir. Nuestros clientes pueden pagar libremente en pesos, Euros o dólares de EE.UU., procediendo al pago ya sea mediante transferencia electrónica o depósito bancario.
Reserve su hora de atención, para mayor comodidad y seguridad a info@aurica.cl.
Visítenos y sepa más sobre nuestros productos en www.aurica.cl
Aurica
Novenos Coloquios de Microbiología comienzan en la Universidad Santa María
Last changed: may 02, 2012 19:07 by Editor Portal Minero Labels: coloqui, microbiología, utfsm
Ciclo de charlas científicas comenzarán en la Casa Central del plantel este jueves 12 de abril, con la conferencia "Generation of protein variants for the investigation and alteration of biocatalysts", a cargo del investigador, Dr. Bernd Hofer.
16 de Abril de 2012.- Con el objetivo de dar a conocer e intercambiar experiencias en torno a la Microbiología y el desarrollo regional que esta disciplina tiene, además de exponer las últimas investigaciones en torno a esta materia en el ámbito local, se realizarán los Novenos Coloquios de Microbiología, actividad que se inicia el jueves 12 de abril en la Casa Central de la Universidad Técnica Federico Santa María.
El ciclo es organizado por el Dr. Michael Seeger, académico del Departamento de Química de la UTFSM; el Dr. Juan Kuznar, académico de la Facultad de Ciencias de la Universidad de Valparaíso; y el Dr. James Robeson, profesor del Instituto de Biología de la Pontificia Universidad Católica de Valparaíso.
Durante las jornadas, que comienzan siempre a las 12.15 horas, y que se extenderán hasta el 23 de noviembre se abordarán los siguientes temas:
Jueves 12 de abril: "Generation of protein variants for the investigation and alteration of biocatalysts", a cargo del Dr. Bernd Hofer de Helmholtz-Zentrum für Infektionsforschung, Braunschweig, Alemania. Esta charla se realizará en el Auditorio Principal de la Casa Central de la Universidad Santa María.
Jueves 24 de may "Eliminación biológica de nitrógeno de aguas residuales", a cargo de la Dra. Lorna Guerrero Saldes, del Departamento de Ingeniería Química y Ambiental de la USM. Esta charla se realizará en el Auditorio Principal de la Casa Central de la USM.
Jueves 14 de juni "Prototipos de formulaciones microbiológicas: los desafíos entre universidad e industria", a cargo del Dr. Luigi Ciampi Panno, de la Facultad de Agronomía de la Universidad Austral de Chile, Valdivia. Esta charla se realizará en el Auditorio Principal de la Casa Central de la USM.
Jueves 5 de juli "Virus sincicial respiratorio e influenza: del genoma a la epidemia", a cargo del Dr. Luis Fidel Avendaño, de la Facultad de Medicina de la Universidad de Chile, Santiago. Esta charla se realizará en el Auditorio B de la Facultad de Farmacia de la UV.
Jueves 16 de agost "Comprendiendo a Piscirickettsia salmonis", a cargo del Dr. Sergio Marshall González, del Instituto de Biología de la Pontificia Universidad Católica de Valparaíso. Esta charla se realizará en la Sala Obispo Emilio Tagle de la Casa Central de la PUCV.
Jueves 18 de octubre: "Bacterias y bacteriólogos seducidos por los ambientes patagónicos y antárticos", a cargo del Dr. Miguel Martínez Poblete, de la Facultad de Ciencias Biológicas de la Universidad de Concepción. Esta charla se realizará en la Sala Obispo Emilio Tagle de la Casa Central de la PUCV.
Viernes 23 de noviembre: "Thoughts into the origin of microbial virulence", a cargo del Dr. Arturo Casadevall, de Albert Einstein College of Medicine de Yeshiva University, Nueva York, EE.UU. Esta charla se realizará en el Auditorio Principal de la Casa Central de la USM.
El ciclo es patrocinado por la Sociedad de Microbiología de Chile, el Centro de Nanotecnología Biología de Sistemas, CNBS-USM y Perkin-Elmer Chile, además de las Universidades Técnica Federico Santa María, Pontificia Universidad Católica de Valparaíso, y de Valparaíso.
UTFSM
Consumo Aparente de Acero durante 2011 creció un 9%
Last changed: may 02, 2012 19:07 by Editor Portal Minero Labels: icha, acero, consumo, aparente
En tanto el despacho de las siderúrgicas nacionales ascendieron un 51%.

16 de Abril de 2012.- Durante 2011 el Consumo Aparente de Acero experimentó un crecimiento del 9% respecto a 2010, alcanzando 2 millones 576 mil toneladas de acero, según señaló el Instituto Chileno del Acero (ICHA).
En este sentido, respecto a 2010, los despachos de las siderúrgicas nacionales ascendieron un 51%, alcanzando un millón 504 mil toneladas. En tanto las importaciones descendieron un 22%, situándose en un millón 117 mil toneladas.
Respecto al consumo de aceros largos, el ICHA agregó que durante el año pasado se registró un aumento del 14%, alcanzando 1 millón 344 mil toneladas. Por su parte, el consumo de aceros planos se elevó 4%, llegando a 1.231 mil toneladas.
Finalmente, hay que señalar que la diferencia entre el consumo aparente y el consumo real, radica en que en el primero -que es el centro de las mediciones- no se consideran las variaciones de inventario que se producen al inicio y término de cada ejercicio.
Icha
Confirmada segunda carrera de autos solares de Latinoamérica
Last changed: may 02, 2012 19:07 by Editor Portal Minero Labels: carrera, autos, solartes, atacama
* Ya hay 20 autos listos para competir desplegados por toda Latinoamérica.
*

16 de Abril de 2012.- Luego de realizar con éxito la primera competencia de autos solares de Latinoamérica, el equipo de Carrera Solar Atacama (CSA), ex Atacama Solar Challenge, está trabajando a toda máquina para realizar la segunda versión de esta innovadora iniciativa que recorrerá el Desierto de Atacama, en el norte de Chile desde el 15 al 19 de noviembre.
Tal como sucedió en la edición 2011, CSA invitará a equipos provenientes de toda la región que podrán inscribirse en las categorías Desafío Solar Atacama, integrada por vehículos impulsados exclusivamente por energía solar, o La Ruta Solar, con vehículos híbridos cuyo funcionamiento también se apoya en la tracción humana.
Entre las principales novedades de esta nueva edición, auspiciada por SQM y Sociedad Chilena de Litio, destaca una nueva ruta con cuatro días que cruzará por las ciudades de Pozo Almonte, Calama, San Pedro de Atacama, Antofagasta e Iquique.
El Director General de Carrera Solar Atacama, Leandro Valencia, destacó que “en esta nueva versión agregamos un día más de competencia, totalizando cerca de 1.300 kilómetros de extensión y abrimos la convocatoria a países de todo el mundo”.
Convocatoria en universidades
Por estos días el equipo de CSA se encuentra difundiendo la iniciativa en distintas universidades para que la mayor cantidad de personas se anime a formar equipos y participen de la competencia con su vehículo solar.
Respecto a la convocatoria de equipos para esta segunda versión, Leandro Valencia se mostró muy optimista asegurando que “hoy ya contabilizamos 20 autos solares desplegados por toda Latinoamérica que están listos para competir”.
Para participar los interesados deben ingresar al sitiowww.carrerasolar.come inscribirse en la categoría “Desafío Solar Atacama”, o en categoría “La Ruta Solar”.Las inscripciones son hasta el 30 de junio y los cupos son limitados.
Valencia aseguró que “quienes se paguen su cuota de inscripción hasta el 30 de abril obtendrán un 50% de descuento en el costo de este proceso, por lo que invitamos a visitarnos y ser parte de esta competencia única en la región”.
Experiencia 2011
En la primera edición de Carrera Solar Atacama participaron 11 equipos, provenientes de Chile, Argentina, Ecuador y Puerto Rico, que cruzaron por las ciudades de Pozo Almonte, Antofagasta, Calama e Iquique durante tres días de competencia, con 1.060 kilómetros de extensión.
En dicha ocasión dos chilenos se adjudicaron el título de campeón. Uno de ellos fue el equipo Antakari, de la Universidad de La Serena, que ganó en la categoría Desafío Solar Atacama, mientras que en la categoría La Ruta Solar, el equipo Los Andes Solar Team obtuvo el primer lugar.
Carrera Solar Atacama
Lixiviación de calcopirita, una alternativa para el futuro de la minería en Chile
*Equipo científico en Antofagasta desarrolla trascendental investigación
*

16 de Abril de 2012.- En la actualidad la mayoría de los yacimientos de cobre en Chile y en el mundo se comienzan a agotar las reservas superficiales de minerales, produciéndose además un descenso sostenido de la leyy escases del recurso hídrico. Por lo anterior, el futuro de esta industria que en gran medida sostiene a Chile y su desarrollo, se encamina a explotar la calcopirita: mineral que se encuentra en lo profundo de los rajos y que se compone de cobre, hierro y azufre (CuFeS2).
Precisamente estudiar la disolución de minerales sulfurados, especialmente la calcopirita, es el objetivo de un amplio estudio que desarrolla la investigadora de la UCN y asociada al Cicitem dra. Lilian Velásquez Yévenes, trabajo que es financiado por BHP Billiton desde el año 2004 cuando ella se encontraba realizando su PhD y trabajando en Australia.
“Este es un mineral muy refractario, es decir, muy difícil de disolver en condiciones ambientales, actualmente se procesa a través de una combinación de técnicas de Flotación y Pirometalurgia. Nuestro desafío, con una gran visión de futuro,es enfrentar la cinética lenta que presenta este mineral, para ello estamos estudiando todos los parámetros que puedan influir en su disolución, pero siempre considerando condiciones ambientales moderadas”.
Plantea que lo anterior, debe llevar a su equipo de trabajo a encontrar un mecanismo que permita entender el fenómeno “para luego evaluar procesos que puedan ser escalados a la industria.”, expresó la investigadora de la UCN y Cicitem.
Fuente de Cobre
La dra. Velásquez plantea que como la calcopirita será nuestra principal fuente de cobre es necesario el desarrollo de alternativas tecnológicas que permitan disolver este mineral -no sólo a través de pilas de lixiviación- sino que también lixiviando los concentrados provenientes de la flotación.
“Esto lo estamos desarrollando usando reactores agitados los cuales podrían escalarse a nivel industrial, estimamos que estos podrían ser del tamaño de una celda de flotación”, explicó.
El desarrollo de estas alternativas tecnológicas, permitiría el uso continuo de las plantas de Lixiviación, Extracción por Solventes y Electro-obtención que en el futuro se quedarían sin alimentación por el agotamiento de los minerales oxidados de cobre.
Escasez Hídrica
En este laboratorio trabajan principalmente usando cloruros como lixiviante, lo cual es una ventaja -señala la dra. Velásquez- pues es un hecho evidente la escasez del recurso hídrico en la zona norte “entonces potencialmente podríamos utilizar el agua de mar en estos procesos pues contiene cantidades de cloruro importantes. Si bien con esto surge el tema de la corrosión, creemos que este problema puede y de hecho ya está siendo solucionado, recordemos que al menos dos importantes mineras de nuestra región trabajan sus procesos con agua marina”, expresó.
Cabe mencionar que la hidrometalurgia es una alternativa a la pirometalurgia, la cual presenta ventajas importantes tales como la posibilidad de tratamientos de minerales de baja ley y un control de residuos con mayor facilidad.
Interés Mundial
Esta área de investigación ha tomado mucha fuerza en los últimos años principalmente por lo señalado al inicio de este artículo, es decir, el agotamiento de las reservas superficiales de cobre y la disminución de las leyes del mineral. “Por eso dentro de nuestro grupo de trabajo hay personas investigando el tema en Australia, Sudáfrica, Canadá y ahora en Chile”, expresó la científica de la UCN y del Cicitem.
Finalmente otro aspecto importante para destacar es la formación de capital humano altamente calificado que permite el desarrollo de este proyecto, pues varios estudiantes de pre y post grado han y están desarrollado sus tesis en este tema, además ya van publicados 6 artículos científicos en revistas indizadas, esperándose para este 2012 la concreción de otros 4.
Por David Pastén Ramos
Universidad de Antofagasta
Vicepresidente de Cochilco se reúne con Viceministro de Minas del Gobierno de Ecuador

16 de Abril de 2012.- El Vicepresidente Ejecutivo de la Comisión Chilena del Cobre (Cochilco), Andrés Mac-Lean Vergara, se reunió ayer con el Viceministro de Minas del Ministerio de Recursos No Renovables del Gobierno de Ecuador, Federico Auquilla Terán, para analizar temas de interés minero bilateral.
El Gobierno de Chile suscribió un Convenio de Cooperación con el Gobierno de Ecuador, que fue renovado en 2010, a través del cual ambos países se comprometen a prestar asesoría técnica en diferentes ámbitos mineros. Durante 2011, en el marco de ese convenio, Cochilco brindó asesoría a Ecuador en materias propias de su competencia.
A la reunión también asistieron, por parte de Ecuador, el Embajador de Ecuador en Chile, Francisco Borja; el Subsecretario Nacional de Contratación Minera, Álvaro Ordóñez; y la Directora de Comunicación Social, Yessenia Barreno, ambos del Ministerio de Recursos Naturales No Renovables; y por Chile, el Director de Evaluación de Gestión Estratégica, Adolfo López; y el Director de Fiscalización, Héctor Moraga, ambos de Cochilco.
Cochilco
Nexans se adjudica contrato por más de 50 millones de Euros para parque eólico offshore en Bélgica
Last changed: may 02, 2012 19:07 by Editor Portal Minero Labels: nexsans, parque, eólico, off, shore
57 km de cables submarinos de 245 kV conectarán Belwind Fase 2 con Northwind, y finalmente con el continente en Zeebrugge.

16 de Abril de 2012.- Nexans, compañía líder mundial en la industria de sistemas de cableado, se ha adjudicado un contrato por más de 50 millones de Euros para abastecer un total de 57 kilómetros de cables submarinos para el proyecto Northwind NV en el Mar del Norte, en Bélgica. El proyecto comprende 14 kilómetros de cables para conectar Belwind Fase 2 con el Parque Eólico Northwind (antes conocido como Eldepasco). A esto se suman 43 kilómetros de cable que transferirán los 381 MW de ambos parques eólicos offshore a la red eléctrica en tierra, a través del punto de conexión en Zeebrugge.
La granja eólica de Northwind considera 72 turbinas eólicas, que suman un total de 216 MW de capacidad instalada. La energía será despachada a la red eléctrica belga, ingresando por la estación ELIA HV en Zeebrugge. La sección de 14 kilómetros de cable de 245 kV consistirá en 3 cables con núcleo de cobre.
La mayor parte del cable de 43 km que conecta Northwind con Zeebrugge comprenderá 3 núcleos de cobre de 1000 mm2. De cualquier forma, hay un tramo en la ruta en el cual el cable, por motivos de seguridad, debe ir enterrado 9 metros bajo el lecho marino.
Los cables submarinos serán manufacturados en la planta especializada de Nexans, en Halden, Noruega. Estos también incluyen dos elementos de fibra óptica FO48, manufacturados en la planta Rognan de Nexans, para activar comunicación de datos, control y monitoreo para el sistema de transmisión de energía.
“Continuando el éxito de nuestros contrato de abastecimiento de cables Belwind Fase 1, estamos muy complacidos por haber sido elegidos adjudicatarios del contrato de abastecimiento de cables de alto voltaje para el parque eólico Northwind”, dijo Dirk Steinbrink, Vicepresidente Ejecutivo de la unidad de cables de alto voltaje y submarinos de Nexans. “Este logro es el resultado del probado expertise de Nexans, y de nuestra excelente relación de largo plazo con nuestros clientes en la industria eólica.”
Nexsans
Presentan últimas tecnologías para el mejoramiento de la infraestructura vial con pavimentos de hormigón
Se reunieron en Chile expertos internacionales y locales para dar a conocer los beneficios del acceso a tecnologías que optimizan el diseño de los pavimentos de hormigón para hacerlos más competitivos.

16 de Abril de 2012.- Dentro de las últimas tendencias mundiales, existen nuevas técnicas y soluciones en diseño, construcción y medición que permiten el mayor desarrollo y competitividad de los pavimentos de hormigón. Por ejemplo, el impulso de las losas de geometrías distintas a las convencionales ha resultado interesante, ya que permite utilizar losas de dimensiones menores, es decir, fabricar pavimentos de menores espesores, sin afectar su comportamiento.
Fue así como el Instituto del Cemento y del Hormigón, en conjunto con la empresa TCPavements, organizaron dos seminarios internacionales en las ciudades de Punta Arenas y Santiago, relacionados con las últimas tecnologías existentes. En esta iniciativa, que contó con el respaldo del Ministerio de Obras Públicas, la Cámara Chilena de la Construcción (CChC),la International Society for Concrete Pavements (ISCP) y la American Concrete Pavement Association (ACPA), se dieron a conocer los beneficios de estas innovaciones, las que, principalmente, apuntan a optimizar el diseño de los pavimentos de hormigón para hacerlos más competitivos.
Con ese fin, vinieron al país dos expertos mundiales en el área, que expusieron sobre tecnologías de infraestructura vial, como las losas cortas o el uso de fibra y método de madurez, entre otros temas. Se trata del ingeniero civil Jeff Roesler, profesor asociado de la Universidad e Illinois y director de la ISCP, quien habló sobre las tendencias e innovaciones en hormigón, así como también se refirió a tecnologías del hormigón para pavimentos y a los fundamentos del uso de fibras. Por su parte, el ingeniero civil de la U. de Leningrado, Rusia, y profesor asociado de la U. de Minnesota, Lev Khazanovic, expuso sobre los fundamentos de métodos mecanicistas de diseño y ensayos no destructivos para pavimentos, dando recomendaciones de su uso para Chile.
De la misma manera, fue presentado el sistema de losas cortas, que permite construir pavimentos de hormigón de primer nivel con costos menores. “Esta es una solución altamente atractiva de construcción de pavimentos de hormigón, porque debiera ser mucho más económica en comparación con los pavimentos tradicionales”, explica Ricardo Salsilli, ingeniero civil de la Universidad de Chile, Ph. D. Illinois University, consultor en el área de pavimentos y profesor de la Universidad de Chile y de la Universidad Técnica Federico Santa María.
Esta es una solución basada en losas con geometría optimizada, que adelgaza los pavimentos con respecto a los diseños tradiciones de hormigón en hasta un 25%, lo que la convierte en una opción muy económica si se compara también con una en asfalto equivalente. Además, debido a la versatilidad del diseño, es posible hacer muchas variaciones, como pavimentos de hormigón con o sin fibra o menores espesores.
Esta tecnología se está introduciendo en el país a través de proyectos concretos que se están realizando en la actualidad y de otros ya concluidos, que han sido licitados por la Dirección de Vialidad del Ministerio de Obras Públicas, como el tramo Chanco-Cauquenes, que actualmente construye Salfa en la Séptima Región. Entre los asistentes al seminario, tanto en Punta Arenas como en Santiago, se contaban una gran cantidad de profesionales del Ministerio de Obras Públicas provenientes de diferentes partes de Chile, así como personeros del Serviu Metropolitano. Asimismo, en ambos eventos se contó con una numerosa presencia de representantes de países como Perú, Argentina, Uruguay y Costa Rica, lo que ratifica el interés existente en otros lugares por conocer más antecedentes de estas nuevas tecnologías.
En ambas instancias, los concurrentes pudieron acceder a los fundamentos científicos de la tecnología de los pavimentos delgados de hormigón de losas cortas, además de los estándares de calidad en el proceso constructivo que permiten explotar su máximo potencial. Por otra parte, los participantes de los seminarios pudieron realizar consultas técnicas a los expertos sobre estas últimas tendencias, lo que facilita el desarrollo y ejecución de más proyectos con pavimentos de hormigón.
De este modo, este intercambio de experiencias sirvió para transmitir a las autoridades del Serviu y del MOP que esta tecnología ha tenido un buen funcionamiento, tanto en Chile como en el extranjero. “En la actualidad, hay más de 3 millones de metros cuadrados construidos en cuatro países distintos, incluyendo Chile, donde estos pavimentos se han fabricado con distintos climas y condiciones de suelo, con un comportamiento excepcional”, precisa Juan Pablo Covarrubias Vidal, gerente general de TCPavements, empresa chilena que actualmente posee la patente del diseño de pavimentos de hormigón de losas cortas.
CCHC
USM recibe a delegación australiana de expertos en minería
Last changed: may 02, 2012 19:07 by Editor Portal Minero Labels: utfsm, amira, delegación, australiana
Representantes de la Universidad de Adelaide-Australia, la Cámara Chileno-Australiana de Comercio y AMIRA International visitaron el Plantel para sondear posibles alianzas estratégicas.

16 de Abril de 2012.- Con el objeto de discutir la posibilidad de establecer colaboraciones de investigación y tecnología entre Chile y Australia, en relación al despliegue de energía geotérmica en operaciones y procesamiento de minerales, la Universidad Santa María recibió a un grupo de representantes de la Universidad de Adelaide-Australia, acompañados por María Galatsanos, presidenta de la Cámara Chileno-Australiana de Comercio y ejecutivos de proyecto AMIRA International.
Stephen Grano, director ejecutivo del Instituto de Recursos Minerales y Energía, explica que la visita se debe a que “tengo una estrecha relación con el profesor Juan Yianatos (director ejecutivo del Centro de Automatización y Supervisión Minera, CASIM) y he trabajado con él en colaboraciones de investigación previamente. Por eso conozco mucho su expertiz en eficiencia tecnológica y enérgica”.
Karol Trautmann, directora de la Oficina de Asuntos Internacionales de la USM, explica que “Australia es una potencia minera. Nosotros también lo somos. Por lo tanto, entre ambos países ya tenemos ciertas similitudes y ciertas complementariedades; en particular la USM y el CASIM tienen mucha vinculación con la minería, con la industria minera y en el fondo la idea nuestra sería complementarnos con Adelaide usando por un lado, la investigación que tienen ellos en este tema, más la investigación que nosotros ya hacemos, agregando el contacto de CASIM con la industria minera”.
Colaboración mutua
Grano propone una opción específica de trabajo conjunto en el futuro entre la Universidad de Adelaide y la USM. “Podríamos colaborar en investigaciones de prospección subterránea, por ejemplo, área en la que ya trabajamos en Australia, y en los recursos geotérmicos debajo de la tierra. La USM podría tomar esa energía calórica, aplicándola en diferentes procesos industriales”.
Karol Trautmann añade que “los investigadores comentaron la idea de aprovechar estas sinergias que se pueden producir, por un lado, por lo que aporta el gobierno australiano, y por otro lado, lo que puede aportar el gobierno de Chile a través de CORFO”.
Asimismo, enfatiza la importancia del desarrollo de una colaboración muy fuerte entre los dos países si este proyecto continúa. “Ese aporte se va a dar solamente si somos capaces de presentar un proyecto redondo, bien completo y argumentado”, recalca. “Por eso este encuentro sirvió para evaluar en qué áreas podíamos colaborar y hacer sinergia para poder eventualmente presentar algo concreto y forjar el apoyo mutuo entre ambos países”.
Por su parte, Grano es optimista acerca del potencial de ambos países para apoyar esta colaboración en minería, pero acentúa la importancia de la existencia de “asociaciones industriales y agencias gubernamentales que promueven colaboraciones de investigación como, por ejemplo, CORFO. Nos gustaría extender los enlaces de colaboración a Chile”.
En el encuentro también participaron, además del académico Juan Yianatos, los profesores Jorge Pontt, Director de CASIM; Gerd Reinke, Director del Centro de Economía y Administración de Residuos Sólidos (CEARS); Mario Toledo, del Departamento de Ingeniería Mecánica; Patricio Núñez, miembro del Centro de Innovación Energética (CIE); Pilar Gárate, del Departamento de Industrias; el investigador Roberto Olave, del CEARS y Tomás Santibáñez, Director de Investigación y Gestión de Proyectos.
UTFSM
Exitosa participación de Moly-Cop en Expomin
Last changed: may 02, 2012 19:07 by Editor Portal Minero Labels: moly, cop, bolas, acero, molienda

16 de Abril de 2012.- Con una exitosa participación, Moly-Cop Chile estuvo presente en la duodécima versión de Expomin, el encuentro mundial de minería más importante de Latinoamérica.
A través un innovador stand, el principal fabricante mundial de bolas de acero para la molienda de minerales, dio a conocer la alta calidad de sus productos y el proceso de su producción.
Los visitantes que acudieron a la feria tuvieron la posibilidad de apreciar algunas demostraciones del software Moly Cop Tools, el cual permite analizar y diseñar operaciones de molienda, mediante herramientas de simulación matemática.
Moly Cop Chile lleva más de cincuenta años abasteciendo a la industria minera, a través de sus dos plantas productivas ubicadas en Talcahuano y Mejillones. Ambas localidades producen en conjunto más de 430 mil toneladas al año y emplean a más de 200 trabajadores.
Moly Cop Chile
Sika Chile recibe certificado de PreNeutralización de Huella de Carbono
Contribuir en la batalla contra los efectos negativos del cambio climático, fue la postura de la multinacional con su Stand Carbono Neutral en Expomin 2012.

16 de Abril de 2012.- Acorde a su política corporativa, Sika Chile se sumó a la iniciativa de neutralizar sus emisiones de Carbono provenientes de sus delegaciones y stand en Expomin 2012. Adhesión que les significó recibir —en una ceremonia realizada en su stand— un certificado de Pre Neutralización, el cual simboliza el compromiso de la multinacional suiza con esta causa y que también los posicionó como un Stand Carbono Neutral.
Esta actividad contó con la presencia de Juan Francisco Jiménez, Gerente General de Sika Chile y quien recibió la distinción por parte de Jorge Urrutia, Gerente General de Proyectos Globales, empresa encargada de llevar a cabo la tarea de neutralización. Además, asistieron de Proyectos Globales Gloria Sobarzo, Ingeniero de Proyectos y Gonzalo Rojas, Gerente Técnico; junto a Cassandra Nattrass, Asesora de Carbono de Sustainable Carbon, empresa que provee los bonos de Carbono; Rodrigo Caballero, Key Project Manager de Sika Chile y Marco Kupper, Regional Controller de Sika.
“Dentro de nuestros valores como compañía existe un punto especial dedicado a la sustentabilidad, el cual hace hincapié en favorecer un desarrollo sustentable. Por ello, nos adherimos a esta causa, la que está justamente en línea con nuestros valores y acciones”, señaló Juan Francisco Jiménez, Gerente General de Sika Chile.
Esta iniciativa contribuyó directamente a combatir los efectos negativos del cambio climático, razón por la cual FISA a través de la empresa Proyectos Globales hizo esta invitación a los expositores, la que inmediatamente fue aceptada por Sika Chile. “Este llamado fue muy bien recibido por parte de los expositores de Expomin 2012. Sin embargo, creemos que la respuesta debiese ser aún más alta y este tipo de iniciativas extenderse a todas las ferias. Cabe mencionar que, las empresas proactivas en esta materia serán finalmente las que ganarán más espacio en el mercado y llevarán la delantera”, afirmó Jorge Urrutia, Gerente General de Proyectos Globales.
Sika
Tecnipak lanza correas transportadoras Bando

16 de Abril de 2012.- Tecnipak, empresa con 11 años de innovación en el diseño, fabricación e instalación de componentes para los puntos de traspaso de mineral, concebidos para optimizar los sistemas de transporte de mineral, lanza en Expomin la comercialización de correas transportadoras de calidad mundial, Bando.
Bando Chemical Industries Ltd. es una empresa japonesa especialista en la fabricación de correas transportadoras y elementos de optimización de sistemas de transporte de graneles. La gama de productos de Bando abarca correas con carcasa textil y de cables de acero con tensiones de ruptura hasta 6000 N/mm, con anchos de cinta hasta 3,000 mm, incluyendo compuestos de caucho especiales para cada aplicación.
El principal ejecutivo comercial de Bando Chemical Industrial, Sr. Ryuichi Sekine, visito nuestro país para participar, junto a Tecnipak, en Expomin. Posteriormente, se realizaron visitas técnicas a las faenas de importantes usuarios de correas transportadoras en el norte de Chile.
Complementando a las cintas transportadoras, Tecnipak ofrece al mercado una amplia gama de productos que se utilizan en los puntos de traspaso de mineral, entre ellos está la línea de raspadores de correas primarios, secundarios y de retorno, placas de desgaste, placas guiadoras, guarderas, deflectores de carga superior e inferior, chutes de traspaso y sistemas de lavados para correas con agua a alta presión.
La compañía también entrega soporte en terreno antes, durante y después de la puesta en marcha de cada proyecto.
Tecnipak
Siemens Chile construirá un Compensador Estático de Reactivos
Se trata de un Compensador Estático de Reactivos SVC PLUS con la última tecnología para el Sistema Interconectado Central en Subestación Diego de Almagro

16 de Abril de 2012.- Siemens Chile recibió la adjudicación por parte de Transelec, para el diseño, construcción y puesta en servicio de un SVCplus de 100 MVAr con conexión GIS 220 kV en la Subestación Diego de Almagro para mejorar el voltaje en el extremo Norte ante fallas de corta duración.
El proyecto - que asciende a la cifra de 25 millones de dólares - deberá desarrollarse en un plazo de 15 meses y permitirá adicionalmente incrementar en un 24 % los niveles de transferencia de potencia desde Subestación Maitencillo al Norte del país, en el sistema interconectado en 220 kV.
Se trata de la mayor solución SVCplus en América del Sur después del proyecto Río Branco en Brasil de 50 MVAr. La solución a implementar por Siemens, hace un uso más eficiente del espacio, contribuyendo a mejorar los parámetros eléctricos de la red.
Este proyecto posibilitará a mejorar la calidad del suministro de energía en la zona Norte del país.
Siemens
Dan el vamos al programa educativo De Cordillera a Mar
Last changed: may 02, 2012 19:07 by Editor Portal Minero Labels: mlp, programa, educativo, coquimbo
La iniciativa de Minera Los Pelambres ha destinado sus esfuerzos a fortalecer la enseñanza de las ciencias a través del método del “Aprender Haciendo”.

16 de Abril de 2012.- El año 2009 el proyecto “Utilizando el deshidratador solar para deshidratar nuestras frutas”, creado por alumnos de la escuela básica de Coirón, obtiene el segundo lugar en la Feria de Ciencia y Tecnología del programa Explora CONICYT realizado en la ciudad de Coquimbo.
Aquella experiencia, que llenó de orgullo a estudiantes profesores y apoderados, fue recordada esta semana en la presentación de la sexta versión del programa educativo De Cordillera a Mar (DCAM), iniciativa de Minera Los Pelambres que busca transmitir el interés por la sustentabilidad del Choapa, a través de la tecnología y la educación bajo la modalidad del “Aprender Haciendo”.
“Para nosotros esta iniciativa es un programa emblemático porque efectivamente su inserción en las escuelas de la provincia y el trabajo que se ha desarrollado con los profesores y los alumnos, nos ayuda a aportar en la educación y calidad de vida de nuestros vecinos” sostuvo Marcelo Pottstock, jefe de Relaciones Institucionales de Minera Los Pelambres.
El programa que a la fecha suma más de 6.500 alumnos, 81 profesores y 36 establecimientos educacionales, tanto de sectores rurales como urbanos, para este año presenta dos nuevas iniciativa; innovar en el fortalecimiento de la evaluación por parte de los profesores en que los alumnos a través de una “teclera” electrónica darán respuesta inmediata a consultas de materias en curso y un trabajo a realizar con los padres-apoderados en torno a trabajar con sus expectativas.
Testigos in Situ
A tres años de haber obtenido el segundo lugar en la Feria de Ciencia y Tecnología, la escuela básica de Coirón se prepara para implementar su proyecto junto a la comunidad. Así lo comenta Isabel Aguilera, directora de esta escuela rural: “Este proyecto va a tener un impacto en la comunidad misma y en otras localidades cercanas, ya que el conocimiento que tuvieron los niños en energía solar y eólica hoy se convierte en un proyecto en terreno para toda la comunidad”.
A su vez, Marco Moraga, director escuela básica de El Tambo comenta que el programa De Cordillera a Mar “ha tenido un gran impacto en las escuelas, especialmente en que los alumnos han aprendido usando nuevas tecnologías y ha permitido facilitar el trabajo de nuestros profesores en el aula, mejorando el aprendizaje de los alumnos en ciencias”.
MLP
Tecno Fast Atco lanzó el primer Módulo Sustentable “Top Eco” del mercado latinoamericano
Last changed: may 02, 2012 19:07 by Editor Portal Minero Labels: tecno, fast, atco, módulo, sustentable, top, eco
La empresa de construcción modular dio a conocer su módulo sustentable Top Eco, el cual es el primero de su tipo en Latinoamérica y que permite disminuir considerablemente la huella de carbono.

16 de Abril de 2012.-
Generar construcciones modulares, de calidad, funcionales y amigables con el medio ambiente es el objetivo de Tecno Fast Atco que desarrolló el primer módulo sustentable en Chile, el cual reduce en hasta un 60% el consumo energético, disminuyendo también, su huella de carbono de los proyectos que lo utilicen.
Los tres principales aspectos que caracterizan a este módulo es que mejora la calidad interior del aire, tiene un bajo consumo de agua y reduce considerablemente los requerimientos energéticos reduciendo el impacto ambiental y transformándose en una solución eficiente para proyectos de todo tipo, combinando las características propias de la construcción modular, como es que todo de fabrica en la planta permitiendo una reducción de hasta 60% respecto a otros tipo se construcción, con un baja intervención al entorno y ahora un manejo eficiente de los recursos.
Entre las principales intervenciones del módulo Top Eco se encuentran innovaciones en elementos tales, como griferías, lavamanos, iluminación y paredes, que permiten racionalizar y optimizar su consumo energético. Además, es importante resaltar que Tecno Fast Atco usa para la fabricación de sus módulos madera certificada de bosques reforestados.
Las características de sustentabilidad de este nuevo módulo se combina con características propias de la construcción modular, en la que todo se realiza en fábrica y en terreno sólo se ejecutan las labores de montaje, generando menor contaminación e intervención en el entorno del edificio con tiempos de términos de la obra de casi un tercio de lo que demora una construcción tradicional en concreto u otro material.
La creación de este nuevo módulo de Tecno Fast Atco, desarrollado por la División Rental, es consecuente con la preocupación de la empresa por que todos sus procesos sean de calidad, excelencia y sustentables, por ello actualmente es una de las pocas empresas en Chile que tiene la tricertificación ISO 9001, IS0 14000 y la OHSAS 18000.
Tecno Fast Atco
Presentan Calcetín con tecnología de Cobre diseñado para los 33 mineros de Atacama
Last changed: may 02, 2012 19:07 by Editor Portal Minero Labels: calcetin, cobre, mineros, 33
Dentro de las novedades que este año tendrá la bienal de minería, destaca la presentación del primer calcetín minero antibacterial, innovación chilena con tecnología de hilado con cobre InCopper, de la marca Monarch.

16 de Abril de 2012.- Perteneciente a la exclusiva línea de calcetines de seguridad, el nuevo producto está pensado para quienes trabajan en el rubro minero y desarrollan labores pesadas. Éste será presentado en Expomin 2012, entre el 09 y el 13 de abril, en el stand de Dust Control, número 902, ubicado en el pabellón 2B.
Se trata de una prenda que cuenta con tecnología desarrollada por Textil Copper Andino, llamada InCopper, que incorpora cobre a la fibra del hilado, metal que tiene propiedades biocidas, es decir, capaces de eliminar microbios, virus, bacterias y hongos.
La idea acerca de este producto surgió de las exigentes condiciones de trabajo en la minería, los que fueron tomados en cuenta en el diseño de los calcetines que Textil Copper Andino le hizo llegar a los 33 mineros que estuvieron 70 días atrapados en la Mina San José, a través de la logística de la Armada de Chile y que arrojaron excelentes resultados en su piel.
Entre las principales cualidades del calcetín con fibra con cobre, elaborados 100% en Chile con maquinarias de alta tecnología, destacan su poder para eliminar el mal olor y su capacidad antimicótica y antibacteriana certificada por la Universidad de Chile, un diseño pensado en otorgar máximo confort en condiciones extremas.
La innovación tecnológica de InCopper es altamente superior, distinguiéndose del resto de los productos existentes en el mercado, ya que incorpora cobre a la fibra del hilado, permitiendo que la propiedad antibacterial de las prendas se mantenga intacta lavado tras lavado.
El uso de los calcetines con tecnología InCopper, además, acelera los procesos de cicatrización y crea barreras contra infecciones. Dentro de sus características destacan filtro UV, punta plana y talón acolchado con hilado con cobre, tejido de rizo interior en planta y pantorrilla que protege y amortigua golpes, tejido microrejilla delantera que refresca durante el uso continuo, zona de compresión anatómica en planta y empeine que ayuda a la circulación sanguínea en personas que desarrollan trabajos pesados, siendo excelente para usar en climas extremos de frío o calor.
Expomin, en el stand de Dust Control junto con Monarch, como acción conjunta con Textil Copper Andino, los creadores de esta revolucionaria tecnología chilena.
Dust Control
Francisco Carvallo asume como Gerente Comercial de TTM en Chile
Last changed: may 02, 2012 19:07 by Editor Portal Minero

16 de Abril de 2012.- El ingeniero comercial Francisco Carvallo Jarpa, asumió como nuevo Gerente Comercial de TTM en Chile, compañía con 30 años de presencia en el mercado de la minería y especialista en sistemas de transporte de minerales.
Con amplia experiencia en cargos gerenciales, Carvallo, que anteriormente se desempeñó como creador y gerente de operaciones de la empresa de servicios Redtec S.A. y Pautas S.A., tendrá como misión el seguir desarrollando el área comercial de TTM en Chile, además de diseñar los planes estratégicos comerciales y entregar los lineamientos sobre las políticas de ventas, entre otros aspectos.
Gracias a su alta capacidad de innovación, aplicación de nuevas tecnologías y permanente compromiso por generar soluciones para hacer más eficientes las operaciones mineras, TTM se ha convertido en una empresa líder en la región, desarrollando sus tareas en Chile, Perú y Bolivia.
TTM
Feria de Repuestos Kaufmann a lo largo de Chile con hasta 50% de descuento
Last changed: may 02, 2012 19:07 by Editor Portal Minero Labels: kaufmann, feria, repuestos, insumos
*

16 de Abril de 2012.- Entre el viernes 20 y el sábado 21 de abril, Kaufmann realizará su Feria de Repuestos en todas sus sucursales a lo largo del país. Los clientes y el público en general, tendrán la posibilidad de adquirir productos con hasta un 50% de descuento para sus autos y vehículos comerciales de las marcas Mercedes-Benz, Freightliner, Western Star y Fuso disponibles en el mercado.
Con el fin de otorgar los mayores beneficios para sus clientes, Kaufmann extenderá esta exhibición en todas sus sucursales a lo largo de Chile. En los locales de Iquique, Calama, Placilla, Talca, Chillán, Temuco y Castro habrá shows con música y comida para los asistentes.
Todas las sucursales de Kaufmann que participen en esta Feria, estarán abiertas durante el viernes 20 de abril desde las 09.00 hasta las 18.30 horas y el sábado 21 de enero entre las 09.00 y 15.00 horas y tendrán a disposición del público ofertas en toda la línea de repuestos enfocados principalmente en vehículos comerciales, destacando las piezas para todo tipo de camiones americanos, en especial de las marcas Freightliner y Western Star.
Las ofertas son para todo medio de pago y contará con la experta asesoría de Kaufmann, que permitirá entregar una orientación para una compra inteligente, informada y adecuada para cada una de las necesidades de los clientes.
La Feria de Repuestos además contará con precios especiales para todos los productos boutique, entre los que destacan artículos deportivos, accesorios y marroquinería, como también precios especiales en grupos electrógenos, motores marinos e industriales Power Systems Kaufmann, y lubricantes y baterías que comercializa en toda su red de locales a lo largo del país.
Kaufmann
Llegó la luz a través de la energía solar a Toconce
Last changed: may 02, 2012 19:07 by Editor Portal Minero
*Con la implementación de Paneles y Hornos Solares en un trabajo en conjunto entre PNUD, Proloa y El Abra
*

16 de Abril de 2012.- Emocionado hasta las lágrimas quedó un grupo en condición social vulnerable de la comunidad de Toconce, quienes ahora cuentan con energía en sus hogares a través del la implementación de paneles solares, los que también fueron incorporados en hornos que utilizan esta energía limpia y renovable, todo a través de una iniciativa impulsada por el Programa de Naciones Unidas para el Desarrollo (PNUD), Proloa y Minera El Abra, operada por Freeport McMoRan.
Sin duda, un proyecto que le permite a los habitantes de Toconce gozar de una serie de beneficios, desde contar con luz en sus viviendas y disminuir los costos energéticos del hogar, sobre esto, la Tesorera de la Asociación de Mujeres de Toconce “Ninches Lickau Cota”, Jaqueline Anza, expresó su emoción indicando que “están satisfechas de participar de este proyecto desde la formulación hasta la implementación y esperamos poder seguir trabajando para poder entregar esta energía a más familias”.
Al respecto, el Gerente de Comunicaciones y Asuntos Públicos de Minera El Abra señaló que “con este proyecto queremos aprovechar la energía solar e incorporar su uso en las comunidades del Alto El Loa, es una apuesta que hemos realizado asociativamente con el PNUD y Proloa, para ir creando proyectos que puedan ser un aporte que les permita a los vecinos mejorar su calidad de vida”.
En tanto, la Gerente de Proloa, Alexandra Marín, explicó que “es muy grato finalizar proyectos que utilizan la energías renovables, como la solar que es tan abundante en la zona y además, ayudar a las comunidades indígenas que están tan aisladas y necesitan nuestro apoyo. Podemos afirmar que mediante este proyecto estamos aportando al desarrollo sustentable de la Provincia”.
Sobre esta iniciativa que es fruto de un trabajo en conjunto con la comunidad, la Coordinadora Nacional del Programa de Pequeños Subsidios delGEF-PNUD, Alejandra Alarcón, señaló que “este proyecto propone soluciones que impactaran el medioambiente a largo plazo pues no genera ningún tipo de contaminación y durarán alrededor de quince años, una alternativa de energía limpia y renovable, que además permitirá un ahorro en término de economía para la familia”.
De este modo, la implementación de paneles y hornos solares en esta localidad se transforma en un gran paso hacia el desarrollo energético sustentable y un gran aporte a la calidad de vida de las personas de este lugar.
SCM El Abra
2012/04/05
Presentan nuevos instrumentos de prevención de infracciones laborales
Chile Durante la primera sesión de este 2012 del consejo, además de la exposición del Director Regional del Trabajo sobre estos nuevos instrumentos de gestión, además se conoció detalles del programa académico de la Escuela de Negocios Mineros de la UCN, iniciativa apoyada por la Asociación de Industriales de Antofagasta. 05 de abril de 2012.- Con la presencia de una veintena de representantes de diversas empresas industriales y mineras, se realizó la primera sesión 2012 del Consejo de Capital Humano y Relaciones Laborales de la Asociación de Industriales de Antofagasta (AIA), ocasión en la cual estuvieron como invitados especiales el Director Regional del Trabajo, Marcelo Pizarro y el Director de la Escuela de Negocios Mineros de la Universidad Católica del Norte (UCN), Oscar Benavente.
Así representantes de Finning, Escondida, Cementos Bío Bío, Zaldívar, Enaex, Sofofa, Guiñez Ingeniería, Kal Tire, Centro de Entrenamiento Industrial y Minero, Yamana Gold y la OTIC de la Cámara Chilena de la Construcción, se dieron cita en esta jornada con el propósito de analizar diversos temas contingentes en materia laboral y desarrollo de capital humano. “Temas que son de suma relevancia para la industria y especialmente para todos nuestros socios, quienes a través de estas dos temáticas buscan mejorar su gestión al interior de las empresas”, señaló el Gerente General de la AIA, Fernando Cortez. Es como en esta reunión, que se realiza mensualmente el primer lunes de cada mes, tuvo como uno de los oradores al Director Regional del Trabajo de Antofagasta, quien expuso dos nuevos instrumentos que esta entidad pone a disposición de las empresas con el propósito de que éstas puedan acceder de manera expedita a una rebaja en su multas, en caso de ser sancionadas por este servicio, así como también el que ellas puedan de manera voluntaria y gratuita, informar el incumplimiento de la normativa laboral de parte de ellas, con el propósito de ser asistidos en la corrección de las infracciones y así solucionar su problema sin ser sancionados. El primero de ellos es el Recurso Administrativo Simplificado (RAS), el cual permite al empleador que ha sido notificado de una multa por infracción a la legislación laboral en temas como registro de asistencia, remuneraciones, horas extraordinarias, contrato, reglamentos y documentación, reconocer su infracción y así pueda obtener una rebaja en la multa, “lo cual permite que no se siga con el proceso y por ende, se puedan subsanar de manera inmediata todas estas irregularidades cometidas con prontitud, siendo una herramienta que beneficia tanto al empleador como al empleado”, aclaró Pizarro. El segundo instrumento es el Sistema de Apoyo al Cumplimiento (SAC), el que, como señala el Director del Trabajo, permite informar de manera gratuita y voluntariamente el incumplimiento de la normativa laboral en que la empresa puede estar incurriendo y a la vez, ser asistido en la corrección de las infracciones, con el fin de solucionar su problema sin ser sancionado. GENERANDO CAPITAL En tanto, el Director de la Escuela de Negocios Mineros de la UCN, Oscar Benavente, dio a conocer los alcances de esta iniciativa y su planificación 2012. Explicó que esta unidad académica busca contribuir al desarrollo de capital humano de excelencia para el sector minero e industrial, “a través de la capacitación en diversas áreas que les permitan desarrollar sus habilidades de liderazgo, comunicación, negociación y trabajo en equipo, fortaleciendo las competencias gerenciales de los ejecutivos de las empresas mineras, de modo que alcancen los más altos estándares de desempeño y de adaptación a los cambios que los nuevos tiempos demandan”. Para lograr esto, es que esta escuela -que nace el 2009 gracias a una alianza estratégica entre Antofagasta Minerals, Anglo American Chile, Barrick Zaldívar, Codelco Norte, Minera Escondida y Xstrata Copper, además del Gobierno Regional de Chile, Corfo, UCN y la Asociación de Industriales de Antofagasta- dispone de dos programas como son el Magister en Gestión Minera y el Diplomado en Administración de Contratos. “Ambos programas buscan satisfacer en parte la actual demanda de capital humano especializado para la minería, para lo cual se forman profesionales bajo un enfoque teórico-práctico, donde se les entrega conocimientos modernos en administración, además del entrenamiento en habilidades para la gestión minera de clase mundial, para lo cual contamos con un cuerpo de académico de vasta experiencia académica y práctica en minería”, dijo Oscar Benavente. Finalmente el Gerente de la AIA destacó ambas presentaciones, las cuales se enmarcan dentro de la política de trabajo que lleva adelante esta entidad gremial y especialmente este consejo “en aras de impulsar el fortalecimiento de las relaciones laborales a través de la concreción de espacios laborales más productivos, trabajadores más motivados y satisfechos, además del desarrollo del Capital Humano Regional con el propósito de contar con trabajadores en cantidad y calidad de acuerdo con los requerimientos de la industria”. Para la próxima sesión de este consejo se acordó volver a invitar al Director Regional del Trabajo para que exponga a los asistente lo relacionado a las Jornadas Excepcionales Marco, régimen que busca regular las jornadas de trabajo especialmente de aquellos que trabajan en el sector minero, ya sea como parte de una compañía o como miembro de una empresa prestadora de servicios. Portal Minero
Minera Los Pelambres mejora estándares en la calidad laboral de sus trabajadores
Last changed: abr 05, 2012 13:21 by Editor Portal Minero Labels: minera, pelambres, mlp, salamanca, choapa, programa, apicultura, alianza, comuneros, coquimbo, miel
ChileNuevas inclusiones en la dieta alimenticia como miel en el desayuno, equipamiento de primer nivel en el gimnasio, más clases de yoga, pilates y bailes entretenidos son sólo algunas de las iniciativas que desarrolla esta empresa con su gente. Jueves 05 de Abril del 2012.- En su búsqueda permanente de mejoras en los servicios a las personas y con el objetivo de contribuir al desarrollo integral de sus procesos, Minera Los Pelambres, su fundación y su empresa colaboradora Sodexo, presentaron una renovada oferta en el área de alimentación, recreación y esparcimiento para sus trabajadores que se desempeñan en su faena en la provincia de Choapa.
“Hoy hay una apuesta de Sodexo en la calidad alimentaria y servicios, queremos que la gente esté más sana en faena y satisfecha”, señaló René Castañón, Gerente de Integridad y Servicio a las Personas de Minera Los Pelambres, mientras que Boris Astete, representante de Sodexo destacó que “los primeros cambios están en el desayuno, almuerzo y cena. También potenciaremos las áreas de recreación, deporte y cultura; donde el primer cambio notorio es el equipamiento de punta que estamos implementando en el gimnasio y la incorporación de profesoras de yoga, pilates y baile entretenido. Las sorpresas también estarán en los ciclos de charlas culturales y motivacionales”. De igual forma, Juan Francisco García, Seremi de Agricultura de la Región de Coquimbo destacó los alcances de este convenio. “Es el puntapié para una alianza productiva que todavía no tiene precedente. Lo que hoy está pasando nos empieza a ver como unos aliados; cómo nosotros tenemos que ver los sectores productivos de la agricultura de la región y apuntar a ser la base de la alimentación para la minería”. Miel al desayuno Dentro de las mejoras que se están implementando en la alimentación, la miel será parte de los desayunos de los trabajadores, ya que se estableció un convenio con la Comunidad Apícola del Choapa integrada por apicultores de las localidades de Quelén Alto, Coirón, Cuncumén, Chalinga, Batuco, Tranquilla y Caimanes, quienes abastecerán con este producto los casinos de Minera Los Pelambres todos los días. María Mancilla, apicultora de Salamanca sostuvo que “somos grandes apicultores que tenemos bastantes colmenas. La venta de la miel nos ayuda para todo. Llevo siete años en esto. La miel es muy buena para la salud”. Portal Minero
APRIMIN y sus Empresas Asociadas participarán en Expomin 2012
ChileEn esta nueva versión de Expomin 2012, y como ya es tradicional, APRIMIN tendrá a disposición de sus asociados un moderno Stand de 105 m2, ubicado en el Pabellón I, 03, que contará con dos salas de reuniones equipadas con conexión WI-FI. Asimismo, más de 50 de sus empresas participarán con apuestas tecnológicas, stands corporativos, diversas charlas y seminarios. Jueves 05 de Abril del 2012.- En Expomin 2012, que se realizará durante la semana del 9 al 13 de abril, el stand de Aprimin que ha sido construido especialmente para sus empresas, tendrá dos salas de reuniones, conexión wi-fi y todo el equipamiento necesario para que los asociados puedan atender en forma exclusiva a sus invitados especiales, visitas y clientes.
El lunes 9 de abril a las 11:30 horas, se realizará la ceremonia oficial de inauguración de Expomin. En esta ocasión, el Presidente de Aprimin, Señor Pascual Veiga, participará del corte de cinta y concluida esta ceremonia, la comitiva oficial hará un recorrido por la feria y, como ya es tradicional, visitará el stand de Aprimin. El martes 10 de abril, a las 15:30 hrs., Aprimin recibirá en su stand, a la Comitiva de Bauma, liderada por Eugen Egetenmeir, gerente general de la compañía ferial, Messe München y por el Dr. Reinhold Festge, presidente del consejo asesor de Bauma. El mismo día, desde las 15:00 a las 16:30 horas, en la sala N° 6 se realizará la charla: “Calidad de Vida en Campamento”. En la actividad organizada por ARAMARK y patrocinada por Aprimin, Participarán como expositores René Fischer, Presidente de Hospitality & Service University, el Subsecretario de Minería, Pablo Wagner y Paola Assael, Directora de Voces Research. El jueves 12 de abril, desde las 11:50 a las 12:30 hrs., el Presidente de Aprimin, Sr. Pascual Veiga, participará en el Seminario “Tendencias Sustentables Oportunidades y Soluciones”, en el Panel de Ejecutivos: análisis y oportunidades. Esta actividad, organizada por ENERA y Expomin y Patrocinada por Aprimin, busca intercambiar apreciaciones y experiencias en torno a la sustentabilidad y compartir, junto a destacados expositores, resultados de investigaciones, mejores prácticas y desafíos. Actividades de asociados en Expomin 2012 - ACTIVIDAD: Show Magic Twins. FECHA: martes 10 de abril HORA: 19:00 LUGAR: Stand Finning INVITA: FINNING - ACTIVIDAD: Charla: “Para la Minería a gran altura, la seguridad comienza en la calidad del sueño”. FECHA: miércoles 11 de abril HORA: 16:00 LUGAR: Sala de Conferencia EXPOMIN INVITA: INDURA - ACTIVIDAD: Charla: Refugio Minero: seguridad, medicina, ergonomía y diseño aplicado. FECHA: Jueves 12 de abril HORA: 16:00 LUGAR: Sala de Conferencia EXPOMIN INVITA: INDURA - ACTIVIDAD: Visita planta Revesol. (En el marco de Expomin) FECHA: desde el 9 al 13 de abril HORA: 11:00 a 14:00 horas LUGAR: Planta Revesol. Miraflores Parcela 5ª, Pudahuel. Más información www.revesol.cl INVITA: REVESOL Portal Minero
IIMCh estará presente en Expomin 2012
Last changed: abr 05, 2012 13:38 by Editor Portal Minero Labels: iimch, expomin, admin, otro, prueba
Chile jueves 05 de Abril del 2012.- El Instituto de Ingenieros de Minas de Chile confirmó su presencia en Expomin 2012, una de las ferias mineras más importantes del mundo que se realizará en Santiago, entre el 9 y 13 de abril.
Ubicado en el stand Nº 1166 del Pabellón 2-B, el Instituto entregará variada información de su quehacer, así como de las principales actividades que realiza. A través de folletería, revistas especiales y recursos audiovisuales, los asistentes a la feria podrán conocer un poco más sobre la historia del IIMCh, y su constante aporte al sector como actor fundamental de la industria minera de Chile. Asimismo, los interesados en asociarse al Instituto como “socios activos” o “socios estudiantes” podrán registrarse en formularios especialmente dispuestos por el IIMCh en el stand de Expomin. Eventos destacados En el stand habrá información actualizada de los principales eventos que organizará el IIMCh durante el presente año, entre los que destaca la tradicional Convención Anual, el Seminario de Medioambiente, y una conferencia especial sobre capital humano. También se entregará información sobre la prestigiosa Conferencia Internacional Copper, el foro técnico más importante de la industria del cobre a nivel mundial, cuya próxima edición se realizará en Santiago, en diciembre de 2013. El stand del Instituto en Expomin 2012 se mantendrá durante los cinco días de esta importante feria minera que se desarrollará en el centro de eventos Espacio Riesco de Santiago. Portal Minero
Seremi de Minería de Coquimbo destacó inversión de US$10 millones de Minera San Gerónimo
ChileEmpresa ligada a la familia Rendic presentó un proyecto al Sistema de Evaluación de Impacto Ambiental que aumentaría la capacidad de tratamiento del mineral para la producción de concentrados de cobre. Jueves 05 de Abril de 2012.- La Seremi de Minería de la región de Coquimbo, Jocelyn Lizana, destacó la inversión de US$ 10 millones que ejecutaría la Compañía Minera San Gerónimo, en la Planta Talcuna, ubicada en la zona de Marquesa, 30 kilómetros al noreste de La Serena.
Lizana resaltó que “si bien este proyecto debe someterse al proceso de tramitación ambiental correspondiente, es una señal del crecimiento que está alcanzando la Mediana y Gran Minería de la región, con inversiones estimadas en US$ 7 mil millones para esta década”. A través de una Declaración de Impacto Ambiental presentada este 4 de abril al SEIA, San Gerónimo declaró que invertirá US$ 10 millones en potenciar la producción de la Planta Talcuna, implementando las instalaciones y ampliaciones de áreas que incrementarían la capacidad de tratamiento de mineral desde las actuales 75 KTM a 120 KTM. “Este proyecto es la visión conjunta de otros tres ambientalizados con anterioridad: Mina Tugal, Planta Talcuna y Embalse Humo Corral. Su única novedad es que aumenta la capacidad de procesamiento de mineral en la Planta, con un diferencial que provendrá de la Mina Tugal, lo que disminuye la vida útil de la mina, aumenta el flujo de vehículos entre ella y la Planta, y aumenta la producción de relaves a depositar en el Embalse Humo Corral”, señala el texto de la DIA. De concretarse esta ampliación, se considera la contratación de 35 personas para la fase de construcción y otras 80 personas para la fase de operación. La Faena Talcuna, de Compañía Minera San Gerónimo, es un complejo de minas y planta que procesa minerales sulfurados de cobre. Los minerales provenientes de la Mina a Rajo Abierto Tugal y de la Mina Subterránea Talcuna, son procesados en la Planta Talcuna, compuesta por etapas sucesivas de chancado, molienda, flotación, espesamiento y filtrado, obteniendo un producto final de concentrado de cobre que se comercializa en el mercado. Portal Minero
2012/04/03
Ceremonia de entrega de diplomas de la primera promoción del Diplomado en Gestión de Activos y Mantenimiento
 Martes 03 de Abril del 2012.- El pasado viernes 30 de marzo, se realizó la ceremonia de entrega de diplomas a la primera promoción (29 alumnos) del Diplomado en Gestión de Activos y Mantenimiento, organizado por el Laboratorio de Gestión de Activos UC (PAMLAB UC), perteneciente al Departamento de Ingeniería de Minería de la Pontificia Universidad Católica y que contó con la colaboración de Dictuc.
Portal Minero
Ampliación minera
Last changed: abr 03, 2012 15:15 by Editor Portal Minero Labels: expomin, ruukki, acero, suecia, kiruna
SueciaEn Pajala, norte de Suecia, se construye la primera mina desde hace muchos años. Ruukki suministra componentes de acero para el sector de la minería y estructuras para el molino de concentración. En Kiruna, también en el norte de Suecia, se amplía la mina existente al construir un nuevo nivel en la mina a una profundidad de 1.300 metros. Martes 03 de abril 2012.- Las actividades mineras en Kiruna se iniciaron hace más de un siglo y ya entonces se conocía que el yacimiento de mineral se extendía por debajo de la zona de asentamiento. En aquellos tiempos, no podían imaginarse la eficiencia que la minería alcanzaría ni que la demanda de mineral de hierro aumentaría a comienzos del siglo XXI. Kiruna es bien conocida como la ciudad que se reubica para alejarse del yacimiento de mineral. Partes del centro de la ciudad se están trasladando gradualmente hasta las pendientes de la colina de Luossavaara. Algunos de los edificios antiguos han sido demolidos y otros se están reubicando enteros. Esta transformación en el transcurso de los próximos 30 años afectará a aproximadamente un 10% del asentamiento.
También existe una fiebre por la minería en otros lugares en el norte de Suecia. Se reabren a buen ritmo minas antiguas y se planifica la apertura de otras nuevas. Por ejemplo, Northland Resources se prepara para explotar el yacimiento de mineral en Pajala, aproximadamente a 120 kilómetros al este de Kiruna cerca de la frontera finlandesa. La misma empresa también analiza la posibilidad de abrir una mina en Hannukainen, en Kolari en el lado finlandés de la frontera. LKAB o Luossavaara-Kiiruna Aktiebolag comenzaron la actividad minera en la cima de la colina de Kiirunavaara y hasta la fecha han alcanzado una profundidad de 1.045 metros por debajo del suelo desde el pico original. LKAB es la única empresa con explotaciones subterráneas entre los principales productores de mineral de hierro del mundo. El trabajo en los túneles está automatizado y se controla de forma remota. Cuanta más profundidad alcanza la mina, mejor calidad presenta el mineral. En la actualidad se construye un nuevo nivel en la mina a una profundidad superior a 1.000 metros. El reto no es tanto obtener el mineral, sino transportarlo. El Malmbana, o tramo ferroviario de 500 metros a lo largo del cual se transporta la producción minera desde Kiruna hasta el puerto de Narvik en Noruega o hasta el puerto de Luleå en Suecia, es imprescindible. Hasta 10-12 trenes diarios realizan el recorrido con mineral entre Svappavaara y Narvik en la orilla del Narvik o Ofoten Fjord. Desde Narvik, el mineral prosigue su recorrido hacia los mercados internacionales. De forma similar, circulan al menos 5 trenes largos con mineral entre Luleå y Svappavaara. Se transporta un total de 1.012 vagones de hierro diarios durante todo el año. El tráfico de mineral de hierro hasta Narvik amentará cuando se inicien las operaciones en la mina de Pajala en 2013. El tráfico sobre la vía de LKAB es prácticamente autosuficiente energéticamente. La ruta circula inicialmente cuesta arriba por la colina y, a continuación, desciende de nuevo. El tren puede circular con piñón libre cuesta abajo y la energía que se genera se introduce de nuevo en el cable aéreo para que se pueda utilizar durante el recorrido de vuelta cuesta arriba. La necesidad de disponer de soluciones ferroviarias e infraestructura aumentará cuando se transporte mineral desde la mina de Kaunisvaara hasta Narvik. El transporte pesado desgasta de forma natural los vagones y las vías. Los vehículos de transporte deben construirse con acero de alta resistencia que pueda soportar golpes, desgaste y condiciones meteorológicas muy frías. Al mismo tiempo, la idea es aumentar la capacidad de transporte al reducir el consumo de combustible. “La cooperación con Norrbotten ofrece a Ruukki una oportunidad excelente para analizar qué podemos llevar a cabo. Tenemos capacidad para producir aceros resistentes al desgaste con una resistencia muy alta. Asimismo, Ruukki puede soldar componentes complejos prefabricados que se pueden montar con facilidad en el lado sueco”, indica Lennart Bergquist, ingeniero de ventas en Ruukki. Bogoljub Hrnjez, gerente en Ruukki, considera que la industria de la minería ha entrado en una nueva era. “Los suministros de mineral son limitados y las actividades mineras demandan soluciones cada vez más complejas para permitir la explotación de mineral en lugares que plantean mayores dificultades de acceso”, comenta Hrnjez. “Simultáneamente, la base de costes en la industria de la minería cambia continuamente. Es más importante que nunca eliminar las costosas interrupciones en la producción y asegurar que la maquinaria y los equipos sean fiables. Los aceros Raex de Ruukki satisfacen las necesidades actuales y permiten realizar las actividades de explotación minera de forma ininterrumpida al menor coste”, afirma Hrnjez. En otoño de 2011, Hrnjez organizó la formación en el sector de la minería para los socios globales de Ruukki y algunos de los cursos se impartieron a un kilómetro de profundidad en el subsuelo. Deben tenerse en cuenta las condiciones de la explotación minera en el diseño de las cabinas para las máquinas de minería. “Los túneles de la mina pueden ser muy estrechos y las máquinas de minería y las cabinas deben adaptarse a estas dimensiones. Independiente de que se trate de un contexto de minería abierta o de túneles subterráneos, las cabinas deben tener la capacidad de soportar vuelcos o la caída de rocas sobre ellas. Por esta razón Raex es una buena elección para las estructuras del bastidor de las cabinas”, explica Juho Koskinen, vicepresidente del negocio de cabinas de Ruukki. Portal Minero
Imatesa presentará en Expomin Reductor Serie 300
ChileExpomin 2012 Martes 03 de Abril del 2012.- Imatesa empresa líder en soluciones electromecánicas para la industria, estará presente en la Feria Expomin 2012, exhibiendo en su stand el Reductor Serie 300 de Bonfiglioli.
En una de las ferias del sector minero más importantes a nivel internacional, Imatesa se encargará de mostrarle a los visitantes y clientes diversos productos de su catálogo, destacando entre ellos el Reductor Planetario Serie 300 Bonfiglioli. La serie 300 es un reductor planetario en disposición lineal o angular con cinemática eplicicloidal. Una de sus características principales es su construcción modular, tanto a nivel de trenes de engranajes como en versiones de entradas y salidas. Este hecho permite gestionar almacenes de repuestos con un tercio de los recambios que habitualmente se aprovisionarían con otros tipos y/o marcas. Principales características - Modular, compacto, de gran versatilidad y robustez.
- Rango de pares nominales: 1.000 a 1.100.000 Nm y amplio rango de reducciones.
- Acoplamiento: IEC, NEMA, Eje rápido de entrada o Motor hidráulico.
- Salidas: Eje macho cilíndrico reforzado, Eje macho dentado reforzado, Eje hueco con disco cónico de apriete y Eje hueco dentado.
- Dos versiones constructivas: en línea y a 90 grados.
- Rodamientos reforzados para soportar mayores cargas radiales y/o axiales.
- Su óptimo rendimiento permite un sensible ahorro de energía y un bajo nivel de ruido.
- Fácil instalación y mínimo mantenimiento.
“Con la exhibición de este destacado producto en la Feria Expomin 2012, queremos mostrarle a nuestros clientes que hemos realizado fuertes inversiones para poder responder al mercado de forma óptima, ya que para nosotros es fundamental entregar soluciones reales”. Manifestó Joaquín Nef, Gerente Comercial de Imatesa. De esta forma, en el Stand 310-1B, la empresa presentará a visitantes y clientes, los beneficios de sus soluciones, destacando el reductor Serie 300, y también de su línea de Motores Eléctricos, Variadores de Frecuencia, Partidores Suaves, Guarda Motores y Chancadores. Portal Minero
|
|